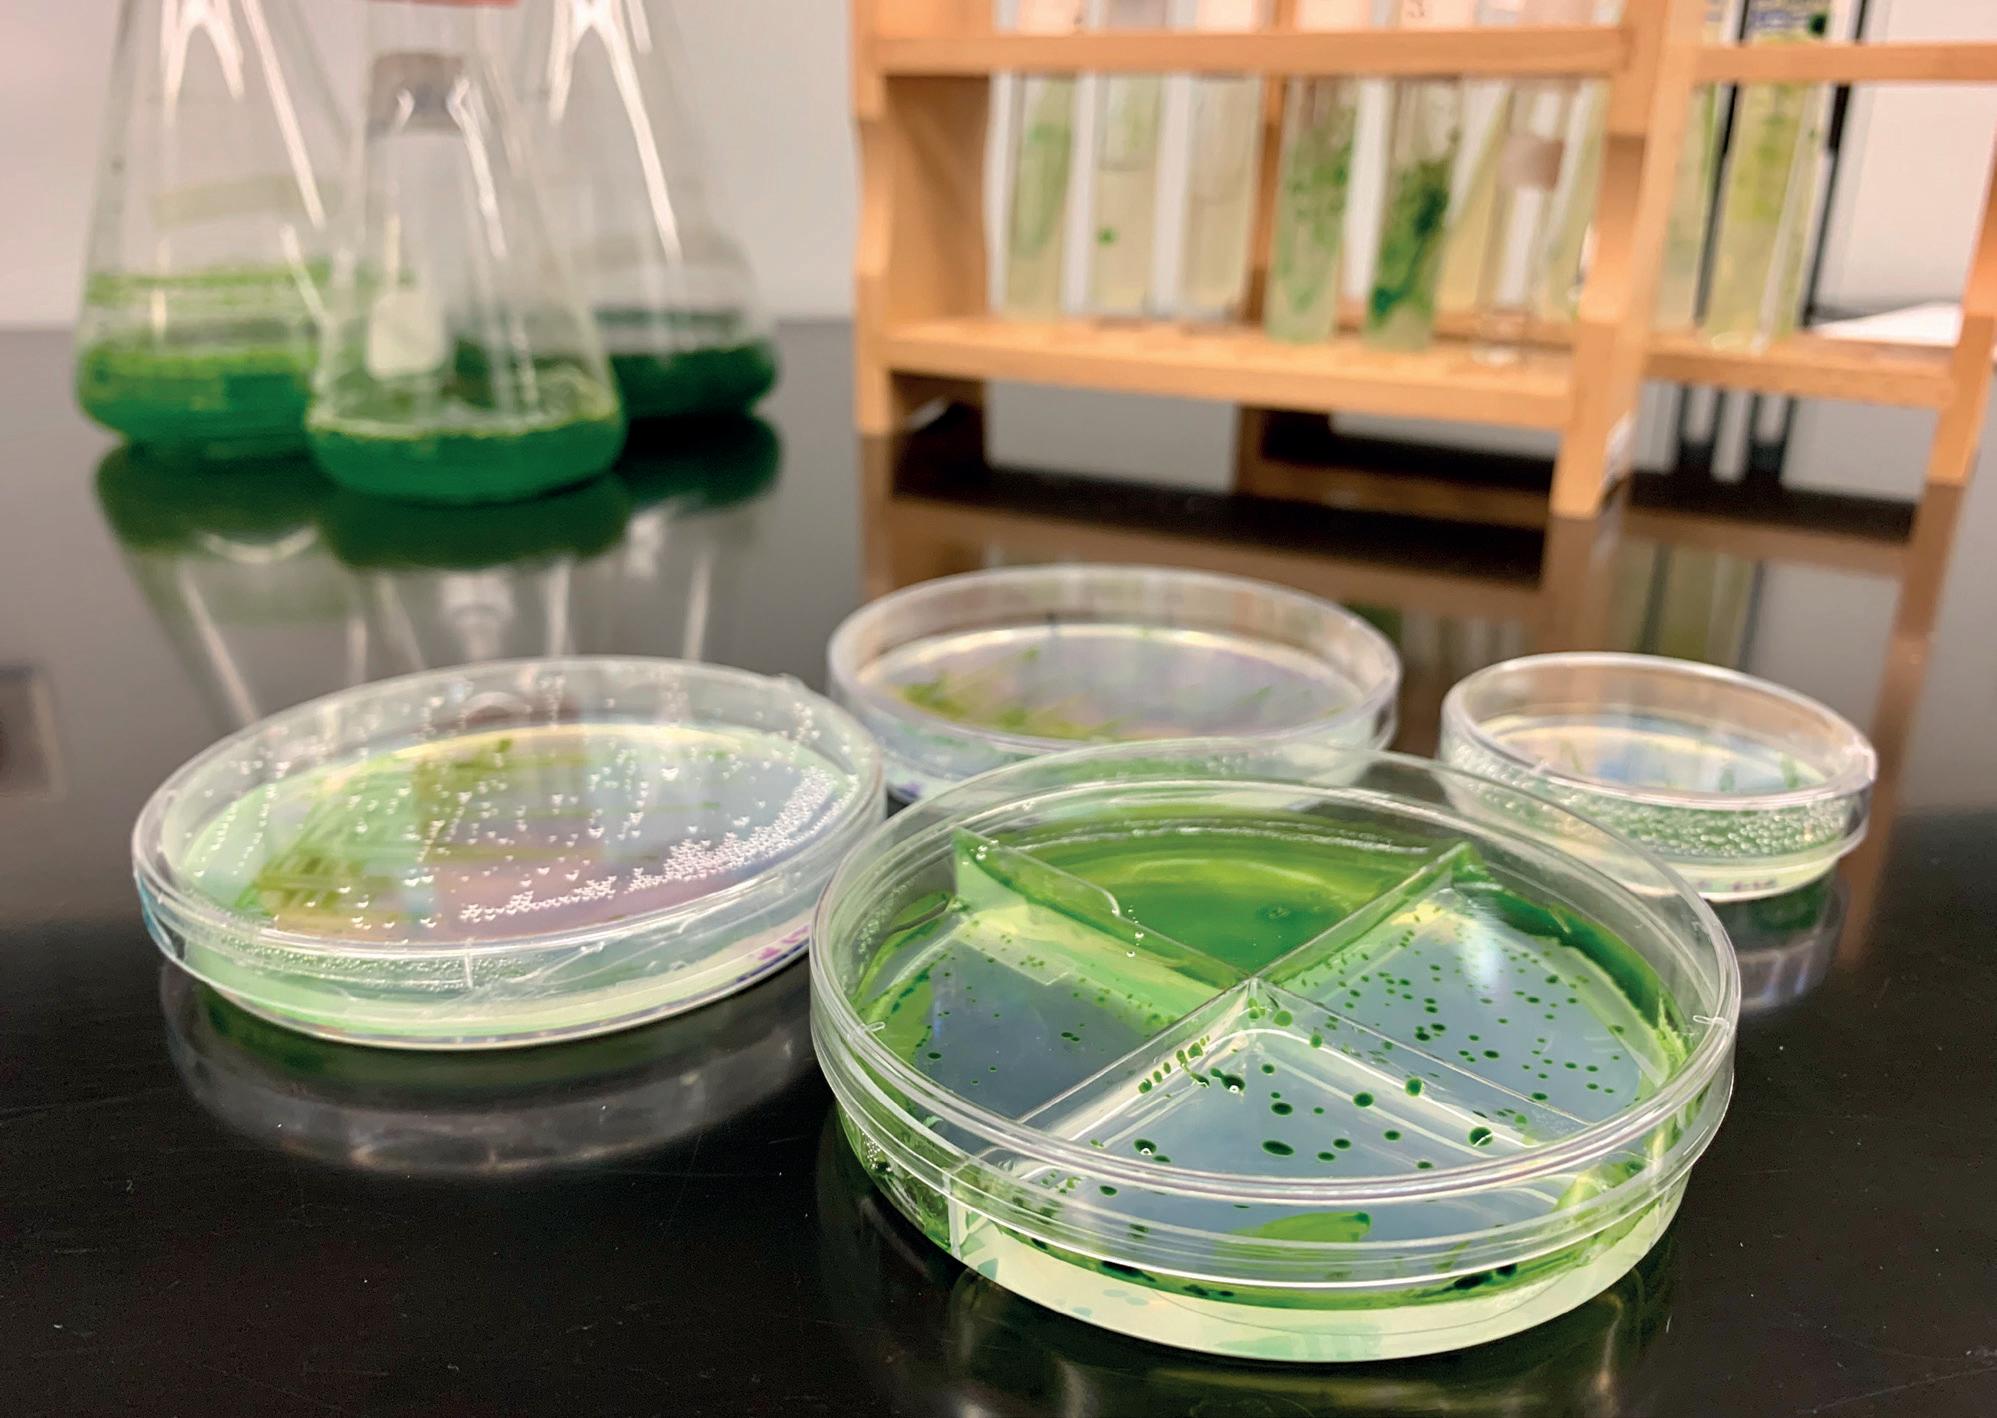

petroleoenergia.com


Celebramos 20 años de nuestra publicación. “No confundas actividad con logro”. JohnWooden
15 EDICIÓN DE LA LISTA REFERENCIA DE LA INDUSTRIA. Los actores más influyentes del sector en México. 20 LAS 100 EMPRESAS MÁS RELEVANTES EN SU DÉCIMA EDICIÓN. Listado de las empresas que están sobresaliendo en la generación de energía y contribuyendo de esta manera a nuestro desarrollo. 66

140
LAS 20 ASOCIACIONES CLAVE DEL 2022 El cuarto listado de este tipo, donde damos cuenta de los gremios más importantes del sector, reconociendo a las agrupaciones que dan voz a las empresas. 82 AÑO 20TOMO 140 DICIEMBRE 2022 / ENERO 2023 $39.00


MOMENTO HISTÓRICO
En el pasado Foro Energético Poblano, organizado por la agencia de energía de aquel estado, el Director de Operaciones de Low Carbon Chile, Erwin Plett dio una gran conferencia en la que -entre otras muchas cosasmencionó que el origen de toda la energía en el planeta viene del Sol.
Nuestra estrella convierte cada segundo 600 millones de toneladas de hidrógeno en helio (596 toneladas de helio es el resultado), de esta fusión es que tenemos la energía para nuestras actividades diarias.
Desde hace varias décadas ha habido una búsqueda para replicar este tipo de fusión a una nano escala en nuestro planeta, para así obtener una fuente de energía no solamente limpia sino -también en nuestra escala- inagotable (el Sol lo hace desde hace 4 mil millones de años).
Casi para terminar el año, a tiempo que nos distraíamos con las nominaciones al Globo de Oro de algunos mexicanos, de las discusiones políticas (en lo local, nacional y global), un grupo de científicos en el NationalIgnition Facility del Laboratorio Nacional Lawrence Livermore en California, Estados Unidos, lograron una fusión nuclear que resultó en una ganancia neta de energía.
El resultado del experimento apunta a ser una fuente infinita de energía limpia que podría ayudar a terminar con la dependencia de los combustibles fósiles.
En la actual transición energética que vivimos, hay pequeños y grandes pasos diariamente, por un lado grupos automotrices chinos multiplican su oferta de autos eléctricos (bajando los precios en el proceso), la alemana BMW inició una producción de una de sus camionetas con tecnología de hidrógeno y así como esto pasa, en Puebla una escuela pública recibió infraestructura de paneles solares en un esfuerzo del gobierno estatal para que en esta transición todos sean incluidos.
Pero la transición es lenta, con una dirección incierta y en lo que asociaciones, empresas y gobiernos tratan de acelerar, incluir e incorporar nuevas tecnologías, seguiremos dependiendo del gas y petróleo por décadas, por lo que siempre tendremos un ojo en los precios, resultado de producción, demanda y movimientos geopolíticos (que es donde entra el azar).
En esta transición, México se encuentra en un lugar privilegiado pues -a diferencia de otras grandes revoluciones- podemos ser actores protagonistas más allá de recipientes de la innovación.

Los hombres, mujeres, empresas y asociaciones que mencionamos en este ejemplar son protagonistas de este movimiento, algunos en la punta de lanza de la innovación y enfocados en las energías limpias y otros tantos en el gran esfuerzo por que la tecnología y combustibles de ayer nos rindan de forma eficiente hasta que la revolución esté completa.
Síguenos en:
/petroleoenergiaoficial @petroleoenergia @petroleoyenergia Petróleo Energia Petróleo&Energía
2 Diciembre 2022 / Enero 2023 P&E Petróleo&Energía
DICIEMBRE/ENERO
JACOBO BAUTISTA REYMUNDO DIRECTOR EDITORIAL P&E
CARTA EDITORIAL

www.petroleoenergia.com
TOMO CXL Diciembre 2022/Enero 2023, MÉXICO
Presidencia
Consejo Editorial: Redacción:
Raúl Ferráez & Jorge Ferráez
Juan Acra, Nymia Almeida, Sergio Beristain, Rubén Camarillo, Eugenio Cortina, Rubén Cruz, Guillermo García Alcocer, Rafael García, Carlos García, Javier Raymundo Gómez Aguilar, Selene González, Israel Hurtado, Sandra Jahnsen, Héctor Olea, Rodolfo Rueda, Fluvio Ruíz, Benjamín Torres-Barrón, Alberto Valdés, Juan Pablo Vega, Benigno Villarreal, Yolanda Villegas y Antonio Vivanco.
Flory Dieck, Yolanda Villegas, Miguel Tovar, Fluvio Ruiz, Julia González, Paul Alejandro Sánchez, Graciela Álvarez, David Talavera, David Cedeño, Brenda Valderrabano, Miriam Grunstein.
Lascitadaspersonassonprestadoresdeserviciosindependientesalarevista
Asistente de Presidencia
Director Editorial: Coordinador de Medios Digitales:

Director Comercial P&E: Ejecutivo de Cuenta:

Director Arte y Diseño:
Arte y Diseño:
Administración: Tesorería: Contabilidad: Facturación: Circulación:

Director Comercial: Mensajería:
Liliana Morales
Jacobo Bautista Reymundo jbautista@petroleoenergia.com Milagros Salomón msalomon@lideresmexicanos.com Javier Senderos jsenderos@petroleoenergia.com Alejandro Mentado amentado@petroleoenergia.com
Fernando Izquierdo Romero Carlos Cuevas Martínez Luis Enrique González Piceno I. Moisés Cervantes Galicia
Susana Sánchez
Claudia G. Garcia Bejarano María Angélica García Miguel A. Rojas Angeles Juan Carlos Camarillo
Gabriel Torres Origel
Alfredo Ramirez y Rogelio Flores Oficinas MÉXICO: Avenida Revolución 1267, piso 19 Int. 1976, Los Alpes, Alvaro Obregón 01010, CDMX; teléfono 91365100.
Laspersonasmencionadasparticipanenlaelaboracióndelarevistaysoncontratadaspor AdministradoradeMediosSAdeCV
DALLAS: 15443 Knoll Trail, Suite 210, 75248 Dallas, TX, USA Teléfono: (214) 206-4966 / Fax: (214) 206-4970
NEW YORK: 4 Lexington Ave. Suite 1A New York, NY 10010 Teléfono: 646-641-5068
Compañía Impresora Preprensa digital e impresión: PPD - Preprensa Digital, Caravaggio 30, Col. Mixcoac, C.P: 03910, Ciudad de México, Tel. (55) 5611 8060 Distribución; Alfesa Comercialización y Logística S.A. de C.V. ACL140903PI2 Corona No. Interior 1, Col. Cervecera Modelo, Naucalpan de Juárez, Estado de México
Petróleo & Energía es publicada bimestralmente por FERRÁEZ COMUNICACIÓN, S.A. de C.V., Avenida Revolución 1267, piso 19 Int. 1976, Los Alpes, Alvaro Obregón 01010, CDMX; Teléfono 91365100. Miembro activo de la Cámara Nacional de la Industria Editorial Mexicana No. 1864. El título de la revista, así como el contenido se encuentran debidamente autorizados y protegidos por la Comisión Calificadora de Revistas y Publicaciones Ilustradas, Secretaria de Gobernación como consta en el certificado de licitud de título y contenido No.15107. Asimismo esta solicitud se encuentra protegida y registrada ante el Instituto Nacional del Derecho de Autor, de la Secretaria de Cultura, según consta en la reserva de derechos No. 04-2018-041111363400-102. Porte pagado y autorizado por SEPOMEX número PP09-1871; Publicada bimestralmente por Ferráez Comunicación S.A. de C.V. Edición 140, Diciembre 2022/Enero 2023. Las opiniones vertidas en este número no son necesariamente las del editor. Se encuentra totalmente prohibida la reproducción parcial o total por cualquier método de esta publicación. De esta edición fueron impresos 25,000 ejemplares.
4 Diciembre 2022/Enero 2023
Petróleo&Energía
DIRECTOR GENERAL Diego Plaza DIRECTOR DE OPERACIONES Alex Prida
Estudio General de Medios Ejecutivos 2010 realizado por: ISSN-1665-8205 Copyright © 2003 - Derechos Reservados All Rights Reserved. PETRÓLEO & ENERGÍA” es ® Marca Registrada Hecho en México - Printed in Mexico CIRCULACIÓN CERTIFICADA POR EL INSTITUTO VERIFICADOR DE MEDIOS
Registro No. 248/02

Encuentra los Códigos QR en nuestra revista impresa, ¡y vive la Experiencia Digital!


1. Portada. Conoce quiénes son los 100 líderes del sector en 2022. Pag 20
• Las 100 empresas más influyentes del sector P 66

• Las 20 asociaciones que dan voz al sector en 2022 P 82
2. Expertos
• Flory Dieck Microbios e Hidrógeno P 10
• Alejandro Baizabal Construyendo desde el entorno local P 14
•Íñigo Segura: La ciberseguridad es esencial en las redes eléctricas inteligentes P 16

• Miguel Tovar: Perspectiva de 2023 para el sector petróleo y gas P 80

3. Movilidad
• El Nuevo Toyota Prius P 90
• BMW impulsado por hidrógeno P 92
• Air France - KLM P 96

4 .Descarbonización
Los esfuerzos más recientes de grandes empresas o conglomerados que buscan reducir su huella de carbono P 94
/petroleoenergiaoficial @petroleoenergia @petroleoyenergia petroleoenergia.com Petróleo Energia
6 Diciembre 2022/Enero 2023 Petróleo&Energía
04
03
02 01 ÍNDICE DICIEMBRE 2022/ENERO 2023
JOSÉ RAMÓN SILVA ARIZABALO

1. Muscle Electric Car
Con planes de sumar más mercados el próximo año, Ford produjo la unidad 150,000 de Mustang Mach-E en la Planta de Ensamble y Estampado de Cuautitlán Izcalli, Estado de México, a partir de que comenzó la producción hace casi dos años. La compañía tiene como objetivo una producción anual global de 270,000 unidades para escalar a 600,000 vehículos eléctricos anuales para fines de 2023.

2. Acuerdo en Gas Licuado
Sempra Infraestructura, subsidiaria de Sempra con operaciones en México y EUA anunció que ha firmado un contrato de compraventa a largo plazo con INEOS, para el suministro de gas natural licuado (LNG) de la Fase 1 de su proyecto en desarrollo Port Arthur LNG en el condado de Jefferson, Texas. INEOS ha acordado adquirir aproximadamente 1.4 millones de toneladas anuales (Mtpa) de GNL de la Fase 1 del proyecto de licuefacción propuesto por un período de 20 años.

3. 70 años de legado en innovación P&G México, empresa mundial líder en productos de limpieza, higiene personal y cuidado para la salud, celebró el aniversario 70 de su Planta Vallejo, con colaboradores, autoridades y miembros de la comunidad industrial. Juan Carlos Trujillo, Presidente y Director General de P&G México, destacó que Vallejo es la planta más grande y una de las más importantes, no sólo para México, sino también para Latinoamérica.

4. Ampliación del gasoducto Mayacan
El Director General de la CFE, Manuel Bartlett, el Director General de CFEnergía, Miguel Reyes, y André Canguçú, celebraron de un convenio que permitirá a las partes acordar los términos técnicos y comerciales para la ejecución de una expansión del gasoducto Mayakan.

8 EN RESUMEN Diciembre 2022/Enero 2023 Petróleo&Energía
04

Flory Dieck Moisés Cervantes
MICROBIOS E HIDRÓGENO
El objetivo de esta investigación trata de los avances tecnológicos que podrían ayudar al planeta a mitigar los efectos contaminantes del dióxido de carbono a partir del uso de combustibles fósiles.
Siempre se ha sabido que el petróleo es un recurso limitado y que por ende sus reservas también lo son. Existen en el mundo un gran número de pozos petroleros agotados, conteniendo sobrantes de petróleo crudo que sería demasiado caro extraerlo. Una lista de pozos agotados no existe, pero se calcula que existen más de 65 mil pozos petroleros agotados de diferentes tamaños en el mundo. Sin embargo, aproximadamente 94% del petróleo crudo se concentra en menos de mil 500 pozos de los más grandes campos petroleros. ¿Qué pasaría si se encontrara una tecnología capaz de volver a hacer productivos los pozos petroleros agotados?
En los últimos años ha surgido una teoría que parece inverosímil: hacer uso de los microbios en la industria energética. En forma unicelular o multicelular, los microbios existen en el planeta con el fin de realizar una específica labor a lo largo de toda la historia de la humanidad. Algunos se han convertido en apoyo para el ser humano, como lo son las levaduras.
El destacado científico, padre de la microbiología, Louis Pasteur, tenía fe en el uso de la microbiología para el bien de la humanidad, por ello no dudaba en aseverar que “la ciencia es el futuro de la humanidad”. Basado en sus conceptos es que ahora se busca cómo utilizar microbios para producir hidrógeno a partir de los residuos de petróleo que se encuentran en los pozos petroleros agotados. Se busca de esta forma diseñar una estrategia para salvar al planeta de una crisis ambientalista y revertir el cambio climático.
Inteligencia Artificial en la energía
La crisis en el sector de la energía requiere de una respuesta rápida de parte de los involucrados en la industria, tienen enfrente una serie de retos como precios fluctuantes de los energéticos, demanda creciente de energía y una inminente
DRA. FLORY ANETTE DIECK ASSAD
Autora del libro “Instituciones Financieras: estructura y regulación” Co-Autora del libro “Energy and Sustainable Development in Mexico”, Premio Nacional a la Ética, Profesora e Investigadora del Tec de Monterrey-Campus Monterrey.

necesidad de disminuir los impactos ambientales de sus procesos productivos. Todos estos retos requieren de soluciones innovadoras. La Inteligencia Artificial (IA) surge como una esperanza para una industria que tiene que enfrentar cambios geopolíticos y regulatorios en temas de contaminación.
Siempre se ha visualizado a la IA como la tecnología que facilita el análisis de grandes cantidades de información histórica, de clima, de pronósticos, de oferta y demanda, etc.
En este preciso caso, la IA será usada para la evaluación, desarrollo y estudio de los genes de los microbios. Con la posibilidad de realizar predicciones, la IA irá de la mano con el nuevo diseño de la estrategia energética de producir hidrógeno a partir de los residuos de petróleo crudo en los pozos agotados del mundo.
Granjas productoras de hidrógeno
Los microbios son entes muy trabajadores. Pasteur calculó que la levadura trabaja sobre la glucosa como si fuera el equivalente a la fuerza de una persona que pesa más de 90kg con la capacidad para cortar 907 mil 200 kg de madera en dos días. También aseveraba que los microbios tienen una impresionante capacidad de reproducción, ya que calculaba que 100 células de levadura bajo las circunstancias correctas podrían multiplicarse y convertirse en 400 mil millones de células en dos días.
Considerando el fundamento de la microbiología de Pasteur, los avances en la ingeniería genética y la IA, los científicos encuentran mayor facilidad para identificar el código genético responsable de los comportamientos deseados en los microbios para replicarlos en aplicaciones prácticas que pudieran incrementar su rendimiento donde estos microbios sean aplicados.
Cemvita Factory es una de las empresas que buscan un crecimiento sostenible con un enfoque inspirado en la natu-
10 COLUMNISTAS FLORY DIECK Diciembre 2022/Enero2023 Petróleo&Energía
raleza misma, tratando de encontrar soluciones tecnológicas que le permitan al hombre disminuir su huella contaminante en la lucha contra el cambio climático. Su modo de operar se define con una palabra: Innovación.
Uno de sus proyectos emblemáticos se refiere precisamente al uso de microbios que se alimentan de hidrocarburos, en particular de petróleo crudo, los fermentan y los productos que excretan son hidrógeno y dióxido de carbono. Esto es, los gases que eliminan estos microbios los emiten a través de las paredes mismas de sus células después de devorar el petróleo crudo.
Existen muchos pozos de petróleo agotados en los que ya no se puede extraer el petróleo residual porque los costos serían muy elevados. Por este motivo, estos pozos tienen petróleo crudo residual y la infraestructura ya colocada y disponible para explotarlos. El objetivo de Cemvita es transformarlos en granjas productoras de hidrógeno biológico, también llamado ‘Hidrógeno de Oro’.
El proceso es simple. Se inyectan estos microbios -vía agua reciclada con el que se les empuja al fondo- en los pozos petroleros agotados existentes que procederán a devorar el petróleo crudo residual; la excreta de estos microbios sería
hidrógeno que se atraparía y vendería y el dióxido de carbono que se separaría para darle un proceso de secuestro y almacenamiento del mismo.
Cemvita realizó este proceso en su laboratorio. Inició modificando los microbios genéticamente, pero con un cuidado tal que no fueran evaluados como genéticamente nuevos. La razón es que las agencias regulatorias están alertas y exigen muchas pruebas si acaso fueran así. El proceso genético es sólo para mejorar las habilidades naturales con las que ya cuenta el microorganismo.

La meta era lograr un objetivo económico de producción de hidrógeno cercano a un dólar americano por kilogramo. Sin embargo, la respuesta del microorganismo fue tan exitosa que excedió los pronósticos de su desempeño a más de tres veces lo proyectado por Cemvita.
Aplicación empírica
Cemvita buscó a una empresa texana que tuviera pozos petroleros agotados y logró un acuerdo con la compañía que opera pozos en la Cuenca Pérmica (Permian Basin, cuenca sedimentaria al oeste de Texas y el sureste de Nuevo México). Ahí se llevó a cabo el experimento: se inyectó una carga de
11 petroleoenergia.com Diciembre 2022/Enero2023
“Estoy absolutamente convencido que la ciencia y la paz triunfarán sobre la ignorancia y la guerra, que las naciones se unirán a la larga no para destruir sino para edificar, y que el futuro pertenece a aquellos que han hecho mucho por el bien de la humanidad”. Louis Pasteur
microbios de prueba en el pozo agotado, logrando extraer niveles de hidrógeno tres veces más grandes que lo estimado en su escenario básico. La respuesta de los microbios permite extrapolar un costo de producción de hidrógeno a un dólar americano o menos por kilogramo.

De este modo, el pozo agotado de petróleo, considerado en el balance general de los libros contables como un activo sin uso, se transforma en un activo fijo valioso de nuevo y una fuente barata productora de hidrógeno con muy poco esfuerzo.
Debate y Conclusiones
El experimento de la empresa Cemvita permite visualizar en el horizonte de la evolución de la humanidad, la forma más barata del mundo para producir hidrógeno. La proveeduría de la materia prima, los microbios, no sería una limitante.
¿Pero el desarrollo de microbios es seguro? ¿Acaso se va a permitir que las empresas desarrollen y cultiven microbios y los inyecten en la tierra? La clave del éxito de este importante descubrimiento estaría en documentar perfectamente que sean seguros para su uso en la tierra y que no desencadenarían consecuencias que pudieran llegar a dañar al ser humano o al medio ambiente.
Sin embargo, este hidrógeno no puede llamarse aún “hidrógeno verde” porque junto con el hidrógeno también se emite dióxido de carbono que tendría que ser secuestrado y almacenado para hacer viable este proceso. ¿Qué tan eficaz es el secuestro y almacenamiento de dióxido de carbono como para hacer de este hidrógeno un producto realmente verde?
El otro obstáculo en el proceso de producción de hidrógeno es que Cemvita no es dueño de los pozos petroleros
agotados. Cemvita debe platicar con las empresas petroleras y exponerles su innovación tecnológica. El resultado sería una posible asociación con las empresas petroleras, vendiéndoles la licencia de uso de esta innovación o asociándose con ellas para poner a trabajar los microbios en sus pozos. Para una empresa petrolera esto sería una gran noticia, ya que un activo en desuso se convertiría de pronto en un activo productor de hidrógeno en el mediano y largo plazo. Ésta sería una gran aportación para la estructura de los estados financieros de las empresas petroleras, donde ahora sus activos agotados se convierten de nuevo en activos productores de una materia prima susceptible de ser vendida en el mercado.
¿Qué piensan los defensores del medio ambiente y guerreros contra el cambio climático? El temor surge de nuevo, porque para que esta innovación de verdad contribuya con los objetivos de control de la contaminación pactados en Paris (Convención Marco sobre el Cambio Climático de las Naciones Unidas), las compañías petroleras deben comprometerse a secuestrar y almacenar el dióxido de carbono que es otro subproducto de esta innovación.
Resulta conveniente que, en un próximo artículo, como continuación de éste, se tratará de explicar el significado de secuestrar y almacenar dióxido de carbono, sus obstáculos y posible aplicación real.
Por lo pronto, lo que mantiene viva la esperanza y hace actual el pensamiento de Pasteur, es que esta innovación tecnológica nos muestra cómo la ciencia triunfa sobre la ignorancia y que gracias a ello podemos seguir utilizando recursos para el bienestar de la humanidad, cuidando del planeta y para que nos lleve a una paz que triunfe sobre la guerra en una deseable convivencia armoniosa de la humanidad.
12 COLUMNISTAS FLORY DIECK Diciembre 2022/Enero2023 Petróleo&Energía

CONSTRUYENDO DESDE EL ENTORNO LOCAL
Alejandro Baizabal, MiembrodelaReddeSolucionesparaelDesarrollo Sostenible,SDSN,ONU Moisés Cervantes
Generar epicentros de movilización donde el Desarrollo Sostenible sea pieza central, me parece una gran oportunidad para construir espacios donde se amplifiquen las voces y se construyan puentes de ideas. Comenzando desde el pulso más cercano que corresponde a los estados y ciudades.
Platicando con Alfredo González, titular de Agenda 2030 en el Gobierno de México, menciona que “muy pocos gobiernos locales se han tomado en serio el impulso al Desarrollo Sostenible en general… quienes ya lo hacen son un ejemplo para otros lugares”.

Plantear escenarios de sostenibilidad se vuelve un factor clave en el desarrollo de cualquier sector que pongamos sobre la conversación. Distintas aristas deben conjugarse para que esto sea factible y, mientras tanto, debemos trazar la ruta hacia este horizonte. Sobre esto quiero platicarles en esta ocasión.
Martha Delgado, Subsecretaria para Asuntos Multilaterales y Derechos Humanos de la SRE de México, nos comparte que “los municipios son estratégicos para incidir en los retos del desarrollo…tienen un gran potencial para traducir las agendas globales en acciones concretas, locales, con un carácter transformador”.
Es necesario entender y comprender los esquemas que nos han llevado a momentos complejos de todo tipo. Saber capitalizar las oportunidades y las alianzas es clave para detonar las redes de aprendizaje e intercambio de saberes que conduzcan a las soluciones desde el ámbito local.
Además, recordemos que nuestra salud depende también de la salud del planeta y basta con dar un vistazo a los nueve límites planetarios que se han planteado para diagnosticar
el estado que guarda nuestro entorno, traspasar estos límites significa aumentar el riesgo de generar cambios ambientales abruptos o irreversibles.
Conviene mencionar que para 2050, los escenarios muestran que cerca de siete de cada diez personas vivirán en las ciudades y esto conllevará un incremento en las estrategias de todo tipo. Para ello se requiere el esfuerzo colectivo que nos lleve a la solución en distintas problemáticas. Que nos acerque a entornos saludables, sostenibles y socialmente justos. Donde todas y todos quepamos en el mismo espacio.
En Córdoba, Veracruz, “renace la movilización de la Agenda 2030”, fue un espacio que congregó a distintos actores de México. Entre ellos, el liderazgo de la juventud, de escritores, académicos, funcionarios, por mencionar algunos. Esto generó la posibilidad de capitalizar alianzas que los llevarán a delinear rutas de mejora en distintas temáticas.
Como reflexión final, debemos seguir sumando actores que fortalezcan la conciencia y la acción colectiva, para hacernos virar hacia una mejor sociedad. No tiene sentido remar de forma individual sin tejer aliados que multipliquen los esfuerzos. Para trascender como humanidad, es necesario colocar estos temas al centro de la conversación, en todos los sectores y en todos los rincones.
14 COLUMNISTAS EXPERTOS
Notas Diciembre 2022/Enero 2023 Petróleo&Energía
DE P&E
El pasado 20 de noviembre en el Hotel Marquis Reforma, empresarios, servidores públicos y líderes destacados del sector nos reunimos para celebrar las dos décadas de esta publicación.

Durante el evento se presentó al nuevo Director Editorial de P&E, Jacobo Bautista, quien habló de la intención de la publicación de acompañar a la industria energética los siguientes 20 años y de hablar más en estas páginas del impacto que tiene el sector en todos los demás sectores de la economía y la sociedad.

El CEO de Líderes Mexicanos y P&E, Raúl Ferráez, hizo un recuento de las dos décadas de la publicación, de las relaciones con Pemex que dieron origen a un número especial de Líderes Mexicanos dedicado a la empresa estatal de la que nació El Mundo del Petróleo, como se llamó durante los primeros años la revista editada por Jorge Zarco durante los primeros siete años.

A Jorge Zarco siguió Milton Méndez y durante los últimos cuatro años la publicación fue responsabilidad de Raúl Cedeño. Entre ellos dieron seguimiento a las reformas y contra reformas que el sector ha tenido en estos años.
El Director Comercial de P&E, Javier Senderos, quien ha estado desde el inicio, habló de las alianzas de la revista con personajes y entidades claves del sector, anunció nuevas alianzas que nos llevarán al cono sur durante 2023 y a nuestra misión de seguir presentes en todos los eventos de la industria.
Cerró el evento Alicia Salgado, periodista y columnista, quien elocuentemente habló de la politización de las actividades de la industria, de las tendencias de nuevas energías y cómo países como Alemania han tenido que regresar al carbón ante la crisis energética en Europa. “Nada está escrito”, pareció decir Alicia, con emoción porque como periodista, sabe que nos tocará contar esa historia, analizarla y explicarla a nuestros lectores.
NUEVO LIBRO
David Enriquez y Yolanda Villegas -miembro del Consejo Editorial de esta revista- presentaron una lectura que se hace esencial en estos tiempos: Energía 2050. Tecnología, Mercados y Regulación, coordinada por ambos y editada por Tirant México.


El tema comienza por la tecnología y su impacto en el sector energético, ambos expertos abordan las aristas de esta historia que no es lineal, pues el cambio climático -causado por antiguas innovaciones- tiene que ser combatido por nuevas tecnologías, lo cual requiere financiamiento y un consenso amplio para ponerlas a trabajar.
Poniendo como fecha el año 2050, el texto es un referente instantáneo para entender las condiciones geopolíticas que van convirtiéndose en regulaciones, aceleradores u obstáculos del camino que queremos trazar a futuro.
15 EVENTOS PUBLICACIONES
Diciembre 2022/Enero 2023
petroleoenergia.com
01 RAUL FERRAEZ 02 ALICIA SALGADO 03 VISTA GENERAL 01 02 03
Redacción Óscar Agis
LA CIBERSEGURIDAD ES ESENCIAL EN LAS REDES ELÉCTRICAS INTELIGENTES
Las redes eléctricas están evolucionando impulsadas por la digitalización y la transición energética que requiere redes cada vez más conectadas e inteligentes que tengan mayor flexibilidad y velocidad de respuesta para ajustar la oferta y la demanda de energía eléctrica, manteniendo o incluso mejorando la calidad de la red; permitiendo la integración de múltiples generadores de energía.
Iñigo Segura, CEO ZGR México Cortesía Carlos Cuevas

Las redes interconectadas brindan muchos beneficios, una de las principales razones para adoptar soluciones inteligentes para las redes eléctricas es lograr la interoperabilidad entre los dispositivos asociados que permiten una mayor eficiencia.
Desde mi experiencia al frente de ZGR México he podido constatar la conveniencia que ofrecen las redes eléctricas inteligentes habilitadas de inteligencia artificial o conectadas mediante internet de las cosas, con la capacidad de monitoreo remoto y procedimientos automatizados para optimizar las operaciones de ajuste entre oferta y demanda de energía, o la velocidad de respuesta ante sus desajustes.
Sin embargo, la infraestructura interconectada basada en redes inteligentes también presenta desafíos debido a la vulnerabilidad por ataques de seguridad cibernética a la que esta expuesta cualquier red ciber-conectada; por ello los operadores de generación, transmisión y distribución de energía cuyo objetivo es brindar un
servicio confiable a sus clientes, requieren tomar medidas para hacer frente al entorno desafiante de la era digital.
En este sentido el reto de la ciberseguridad es un tema esencial que se debe incorporar a los planes estratégicos del sector de energía eléctrica y las empresas que operan al interior, como nosotros; ya que detener el suministro de electricidad de una ciudad por una vulnerabilidad, implicaría algo más allá de molestias a los usuarios, dado que los servicios de emergencia de atención médica, los sistemas de servicios comerciales y las industrias dependen de la disponibilidad de electricidad para sus operaciones.
Cómo contribuir a la ciberseguridad de las redes eléctricas Integrar soluciones de ciberseguridad para potenciar las redes eléctricas es vital para las empresas que forman parte del ecosistema de energía eléctrica, los operadores deben trabajar con expertos en seguridad cibernética e instituciones competentes para identificar las vulnerabilidades en sus redes y generar modelos que contribuyan a determinar el nivel de seguridad.
Comparto a continuación algunas recomendaciones desde la experiencia que nos brindan las acciones que estamos ejecutando en ZGR para contribuir a la ciberseguridad del sector, bajo la adherencia como CNA, Autoridad de Numeración de Vulnerabilidades y Exposiciones Comunes.
• Anticiparse
Estudiar las pautas y los marcos de seguridad cibernética de la industria, contribuye a anticiparse
16 COLUMNISTAS Diciembre 2022 / Enero 2023 Petróleo&Energía
para abordar las brechas e implementar soluciones de manera oportuna ante los riesgos de ciberseguridad y operativos.
Anticiparse también tiene que ver con darle visibilidad integral a los componentes de la red, identificar su disponibilidad, en dónde se encuentran las conexiones, los activos y saber cómo se comunican los sistemas en tiempo real.
Lo anterior permite garantizar el monitoreo oportuno de los equipos, y emitir informes de lectura de medidores que arrojan datos respecto a la calidad de la energía que reciben los usuarios y que contribuye a garantizar un suministro de energía ininterrumpido.
• Diagnóstico
Realizar un diagnóstico avanzado y continuo de amenazas resulta fundamental para determinar la eficiencia de los recursos.
Un diagnóstico permite evaluar los riesgos e identificar las áreas problemáticas potenciales desde una perspectiva de operaciones para tener los elementos adecuados que permitan desarrollar una estrategia de ciberseguridad.
La evaluación de riesgos operativos debe basarse en las mejores prácticas de seguridad cibernética y en los estándares de seguridad específicos de la industria de cada país. Nosotros, por ejemplo, al ser autorizados como CNA, tenemos la capacidad de hacer un diagnóstico y seguimiento de vulnerabilidades en equipos, siendo aptos para publicar y divulgar la vulnerabilidad que afecte al sector.
Este tipo de diagnóstico permite proteger a los sistemas de red inteligentes al identificar de forma avanzada amenazas y anomalías que afecten la eficiencia de la infraestructura, pero también cubren el aspecto de la integridad de los datos garantizando la autenticidad de la información asociada al suministro de energía.
• Acción
Una vez realizado el diagnóstico se requiere desarrollar un programa de ciberseguridad que permita definir cómo tratar las alertas que señalen riesgo cibernético o alguna anomalía en el comportamiento de la red.
Un plan de ciberseguridad contribuye a implementar estándares propios en los equipos que forman parte de la infraestructura, y a elegir aquellas soluciones que sean capaces de ofrecer eficacia y rentabilidad para el negocio.
Lo ideal es optar por soluciones que brinden interoperabilidad, monitoreo continuo, flexibilidad y que proporcionen informes y datos que permitan identificar posibles cambios en la red con el paso del tiempo.
Como parte del plan de ciberseguridad, recomiendo participar en proyectos de colaboración con otras empresas o instituciones que ofrezcan innovación y opciones que contribuyan a mitigar los retos en materia de ciberseguridad.
Un enfoque integrador será la clave para que las bondades de la era digital puedan ser habilitadas por un mayor número de jugadores del sector de manera segura, cumpliendo con las normas existentes y recursos.
Tener en cuenta los riesgos y anticiparse a ellos será el camino para no privarse de la conveniencia que ofrecen las redes eléctricas inteligentes. Todos los integrantes del entorno de energía eléctrica tenemos una oportunidad para ofrecer soluciones robustas que tengan a la ciberseguridad como un elemento esencial para operar.
ACERCA DEL AUTOR: IÑIGO SEGURA, ES CEO DE ZGR MÉXICO, CUENTA CON UNA INGENIERÍA INDUSTRIAL Y UN MBA POR IE BUSINESS SCHOOL, CON EXTENSA EXPERIENCIA EN DESARROLLO DE NUEVOS PRODUCTOS Y TECNOLOGÍAS.

17 petroleoenergia.com Diciembre 2022 / Enero 2023
EN CHILE YA SE PRODUCEN COMBUSTIBLES SINTÉTICOS
A
ESCALA INDUSTRIAL
Comenzó la producción de los primeros litros de combustibles sintéticos en Haru Oni -cerca de Punta Arenas al sur de Chile-, la primera planta totalmente integrada del mundo para la producción de combustibles neutros en CO2.
para llevar energía verde a áreas que aún dependen en gran medida de los combustibles fósiles. Esta es la clave para alcanzar los objetivos climáticos del sector del transporte. Los conocimientos adquiridos en este proyecto también contribuirán al desarrollo de soluciones amigables con el medio ambiente para muchas otras aplicaciones”.
La planta en la región de Magallanes estará totalmente terminada en marzo de 2023, en menos de dos años de construcción. Como co desarrollador e integrador de sistemas, Siemens Energy está desempeñando un papel clave en la configuración de este proyecto emblemático.

no y colaborará con la transición energética en Europa y en todo el mundo. La región ofrece hasta 6 mil horas de funcionamiento a plena carga para generar electricidad verde, alrededor de tres veces la cantidad disponible en Europa. Haru Oni está haciendo un trabajo pionero y puede ser un modelo a seguir para muchas otras regiones. La iniciativa, única en el mundo, cuenta además con el apoyo del Ministerio Federal de Asuntos Económicos y Protección del Clima de Alemania. En 2020, Haru Oni fue el primer proyecto de hidrógeno financiado como parte de la Estrategia Nacional de Hidrógeno en ese país.
La planta producirá hidrógeno verde a partir de energía eólica y agua, luego metanol a partir de CO2 capturado, y finalmente gasolina neutra en carbono. Siemens Energy diseñó esta planta piloto de HIF Global, y es responsable de la integración del sistema a lo largo de toda la cadena de valor.
La producción de e-Fuelsserá un componente decisivo en la descarbonización del sector del transporte, especialmente para aquellas áreas que son difíciles o no se pueden electrificar, como el transporte marítimo, el tráfico aéreo o los automóviles con motores de combustión interna.
Anne-Laure de Chammard, miembro de la Junta Directiva Global de Siemens Energy destacó que este proyecto “tiene como objetivo demostrar que los e-Fuels pueden comercializarse en grandes cantidades y a precios competitivos. Sienta las bases

El hidrógeno, que es la base de la síntesis del combustible, se produce con un electrolizador de Siemens Energy y un aerogenerador proveniente de Siemens Gamesa. El gran desafío del proyecto fue combinar los pasos del proceso para fabricar combustibles sintéticos que anteriormente solo se habían probado individualmente, y coordinarlos en una cadena de producción por primera vez de una manera eficiente y sin problemas.
Se espera producir 130 mil litros de e-Fuel al año para 2023. Después de la fase piloto, el proyecto se ampliará aún más: a mediados de la década, se espera que la capacidad de producción aumente a 55 millones de litros por año. Un par de años después, se prevé que la capacidad anual sea de 550 millones.
El proyecto impulsará el enorme potencial de las energías renovables en la Patagonia austral para la economía del hidróge-
Además, este proyecto utilizará por primera vez la solución Clean Energy Certification desarrollada por TÜV Süd y la Agencia Alemana de Energía DENA, junto con Siemens Energy. Este certificado digital demuestra de forma fehaciente si un producto merece ser considerado “verde”. Para este propósito, la huella de CO2 se documentará a lo largo de toda la cadena de producción, en este caso desde la turbina eólica hasta la carga del combustible en el tanque.
18 TECNOLOGÍA E INNOVACIÓN SIEMENS ENERGY Diciembre 2022/Enero 2023 Petróleo&Energía
Redacción Cortesía Luis E. González
ANNE-LAURE DE CHAMMARD MIEMBRO DE LA JUNTA DIRECTIVA GLOBAL DE SIEMENS ENERGY

Presentamos nuestra lista de Los 100 líderes más influyentes del sector energía en México en su edición 2022. Una fotografía del momento en la industria son los personajes más influyentes del último año.
Los listados siempre son complicados de hacer, no por la investigación, recopilación de datos y exhaustivo análisis de todos los actores de un sector en constante cambio, envuelto en los últimos años en asuntos políticos que van más allá de la eficiencia, renovación o cifras duras. Se trata sobretodo de un número finito (que pudieran ser 300 ó 101) en una inmensa cantidad de posibilidades porque la industria energética está llena, afortunadamente, de grandes talentos.
Este ejercicio siempre tiene como resultado el conocer nuevas personas, con cada nueva propuesta para incluir a un personaje en la lista, encontramos una nueva historia, una (o varias) innovaciones y un esfuerzo más para sumar a la creación, distribución y mejor consumo de energía.

Aquí están los 100 que en 2022 pasaron el corte.

PORTADA
20 Diciembre 2022/Enero 2023 P & E Petróleo&Energía

INNOVACIÓN/TECNOLOGÍA / PRIVADO JUAN ACRA LÓPEZ
PRESIDENTE DEL CONSEJO MEXICANO DE LA ENERGÍA
Ingeniero Mecánico Eléctrico porla Universidad Anáhuac | Curso AD2 en IPADE | Diplomado de tecnología e innovación en Kellog School of Management
FUNDÓ SECNER, empresa de servicios para el sector energético asociada con Endress and Hauser (E+H), corporación suiza líder en Automatizacion en procesos industriales. Ha sido electo Presidente del COMENER, organismo cúpula del sector energético nacional. En el periodo 2016 al 2018 fue miembro del Capítulo Mexicano del Energy Business Council que depende del dialogo de alto nivel entre USA y MX. Es Presidente del Nodo Energético del Centro, empresa subsidiaria de Grupo Valoran.

www.comener.org Juan Acra (Oficial) @juanc_acra
RODOLFO ALFONSO ESQUIVEL
DIRECTOR GENERAL DE GRUPO ROALES


Ingeniero Industrial Administrador de la Universidad Del Valle de Bravo | Maestrías, una en Administración y otra en Administración Pública
DIRIGENTE ESTUDIANTIL en su juventud, actualmente es delegado Sindical del Sindicato Autónomo Nacional de Trabajadores y Empleados de las industrias de Hidrocarburos y Energías y sus Actividades Relacionalas General Lázaro Cárdenas del Río en Campeche. Forma parte del Consejo Mexicano para la proveeduría del Sector Energía como delegado de la organización en Campeche, donde preside las relaciones gubernamentales y es secretario de la comisión de gas de dicha institución.
www.gruporoales.com Rodolfo Alfonso Esquivel @GrupoRoales
RENOVABLE/ALTERNATIVA / PRIVADO ENRIQUE ALBA CARCELÉN
CEO DE IBERDROLA MÉXICO
Ingeniero industrial por la Universidad Politécnica de Madrid | Programa de Dirección General por la Universidad de Navarra (IESE)
TIENE EXPERIENCIA en el sector eléctico que se extiende por dos décadas. En 1999, se incorporó a Iberdrola, donde ha tenido distintos responsabilidades, hasta que en 2014 fue nombrado Director General de Iberdrola México. La empresa es productora de electricidad con una capacidad de operación de más de 7,000 MW en ciclos combinados, cogeneraciones, parques eólicos y fotovoltaicos. Para 2018, fue nombrado CEO de Iberdrola México

www.iberdrolamexico.com Iberdrola México @iberdrolamex
GAS / PÚBLICO ABRAHAM DAVID ALIPI MENA
DIRECTOR GENERAL DEL CENTRO NACIONAL DE CONTROL DEL GAS NATURAL
Licenciado en Comercio Exterior y Aduanas en la Universidad Olmeca | Maestría en Administración de Empresas| Doctorante en Políticas Públicas orientado a Energía
CON UNA sólida trayectoria de 20 años en la administración pública laborando para Pemex desde 2001 hasta 2021.Fue nombrado por el Presidente de la República como Director General del Centro Nacional de Control del Gas Natural (Cenegas) en febrero de 2021. Cuenta con una amplia experiencia en la industria petrolera, en las áreas de procura, planeación e inteligencia de mercado.
www.gob.mx/cenagas Abraham David Alipi Mena @CENAGAS_mx
22 Diciembre 2022/Enero 2023 P & E Petróleo&Energía
N 1
N 2
HIDROCARBUROS / PRIVADO
N 3
N 4
HIDROCARBUROS /
PRIVADO
GRACIELA ÁLVAREZ HOTH
 DIRECTORA GENERAL DE NRGI BROKER
DIRECTORA GENERAL DE NRGI BROKER
Contador Público ITESM |Certificación en grandes riesgos para la industria petrolera | Asesora en seguros para entidades federales y estatales
RECONOCIDA COMO una de las mujeres más destacadas del sector oil & gas. Cuenta con una trayectoria de más 30 años en la administración de grandes riesgos del sector de energía y actual Coordinadora del Comité de Seguros Marítimo de la Cameintram. Líder de opinión consolidada a través de su iniciativa ‘Visión Energética’, así como ‘Voces de Energía’ donde reúne periódicamente a empresarios, autoridades y líderes de organizaciones para analizar diversos temas del sector hidrocarburos. Reconocida por las revistas Forbes y Expansión como una de las mujeres más poderosas de México
www.nrgibroker.com Graciela Álvarez Hoth @AlvarezHoth
SANTIAGO FABIAN ARROYO SEGUEDO
DIRECTOR Y GENERAL DE URSUS ENERGY
Licenciado en Derecho por la Universidad Autónoma de Querétaro
ESPECIALISTA EN energía, regulación y desarrollo de negocios en la materia con más de una década de experiencia en el sector. Egresado de la Universidad Autónoma de Querétaro como Licenciado en Derecho y diversos estudios adicionales en Administración Pública, Mediación y Desarrollo de Negocios. Fue candidato a Diputado Federal por el Distrito 4 de Querétaro.
sarroyo.net/ursus-energy Santiago Fabian Arroyo Seguedo @SarroyoSi
ELÉCTRICA / PRIVADO JOSÉ APARICIO
PRESIDENTE Y CEO DE SIEMENS ENERGY MÉXICO, CENTROAMÉRICA Y EL CARIBE

Ingeniería Eléctrica y Electrónica Tennessee Technological University | Diplomado en Liderazgo y gestión organizacional
SU EXPERIENCIA en el sector eléctrico se remonta a 1988 cuando comenzó su carrera en Westinghouse Electric Company. Se unió a Siemens en 2011 como Director General de Soluciones para la región de Mesoamérica, ha ejercido el liderazgo operativo para el desarrollo exitoso de negocios en el sector energético.
new.siemens.com/mx José Aparicio @Siemens_Energy

ENERGÍA / PÚBLICO ERMILO BARRERA NOVELO
DIRECTOR GENERAL DE LA AGENCIA DE ENERGÍA DEL ESTADO DE PUEBLA
Licenciado en Relaciones Internacionales por el ITAM | Programa de Fortalecimiento de la Función Pública de la Fundación Botín

CON EXPERIENCIA lo mismo en la iniciativa privada (sector regeneración renovable) que en la pública (fue Subdirector en la CRE), tiene la clara convicción de convertir a Puebla en referente del combate a la pobreza energética, así como de innovación, atracción de inversiones y electromovilidad.
agenciadeenergia.puebla.gob.mx Ermilo Barrera Novelo @Milo_barrera
23 Diciembre 2022/Enero 2023 P & E Petróleo&Energía
N 5
N 6
HIDROCARBUROS / PRIVADO
N 7
R 8
HIDROCARBUROS / PRIVADO ROSANETY BARRIOS BELTRÁN
Licenciada en Finanzas por la Universidad Tecnológica de México | Maestría en Finanzas por la UNAM(mención honorífica) | Maestría en Regulación Económica de Industrias de Red por la Universidad de Barcelona


EXPERTA EN finanzas y energía con una experiencia profesional de más de 30 años. Estuvo a cargo de parte del diseño del nuevo modelo energético mexicano y fue responsable de la política pública para el desarrollo de los mercados de gas natural y petrolíferos. Tiene además más de 15 en el sector financiero mexicano. Consejera Fundadora del grupo Voz Experta, colectivo de mujeres de alto perfil que tiene como objetivo la visibilización de mujeres en los foros de energía.
www.opinion51.com Rosanety Barrios Beltrán @RosanetyBarrios
ANDRÉS BAYONA INSIGNARES
Ingeniero Industrial | MBA | Especialista en mercadeo
COMO PRESIDENTE de la AMGNV trabaja en el crecimiento y fortalecimiento del gas natural en México, posicionándolo como una de las personalidades más influyentes de la industria energética nacional. Ingeniero industrial, MBA y especialista en mercadeo, Andrés Bayona es reconocido por su incansable promoción y desarrollo del gremio, lo que ha llevado a este hidrocarburo a cobrar mayor importancia como una de las fuentes energéticas más seguras, económicas y amigables con el medio ambiente.


www.energeticae3.com Andres Alfonso Bayona Insignares @energeticae3
DE LA AMGNV
ELÉCTRICA / PÚBLICO MANUEL BARTLETT DÍAZ
DIRECTOR GENERAL DE LA COMISIÓN FEDERAL DE ELECTRICIDAD
Licenciado en Derecho por la UNAM | Posgrado en Derecho Público Université Paris 2 | Diplomado en Administración Pública en la Universidad Victoria de Manchester
ACTUALMENTE AL frente del proyecto del fortalecimiento de CFE en la administración federal. De acuerdo a su Direccionamiento Estratégico con miras a 2023, el objetivo es convertir a la CFE de empresa eléctrica a una energética y tecnológica.
www.cfe.mx
@ManuelBartlett
HIDROCARBUROS / PRIVADO ANDRÉS BRÜGMANN
VICEPRESIDENTE DE HOKCHI ENERGY
Ingeniero Químico por la UNAM (graduado Magna Cum Laude) | Maestría en Administración de Empresas del IPADE
HOKCHI ENERGY forma parte de Pan American Energy, su Vicepresidentre cuenta con 20 años de experiencia en la industria (lo mismo en la iniciativa privada como en la función pública), especializándose en desarrollo de negocios, procura y fianzas.
hokchienergy.com Andres Brügmann @AndresBrugmann
24 Diciembre 2022/Enero 2023 P & E Petróleo&Energía
ESPECIALISTA INDEPENDIENTE EN TEMAS DE ENERGÍA Y CONSEJERA FUNDADORA DE VOZ EXPERTA
N 9
N 10
GAS / PRIVADO
SOCIO FUNDADOR DE PROMOTORA ENERGÉTICA E3 / PRESIDENTE
R 11
N 12
ENERGÍA / PRIVADO
MARIUZ CALVET ROQUERO
DIRECTORA DE FINANZAS SUSTENTABLES EN HSBC MÉXICO Y CENTROAMÉRICA
Licenciada en Relaciones Internacionales por la UNAM | Abogada con especialidad en Derechos Humanos por la Anáhuac
INTEGRANTE DEL grupo fundador de los Principios para la Banca Responsable y forma parte del Comité Latinoamericano para los Principios de la Inversión Responsable. Desde el campo académico como profesor de Derecho y Derechos Humanos, hasta miembro de la Junta de ONG, los últimos 16 años se han centrado en las estrategias, el desempeño y las divulgaciones de sostenibilidad corporativa del sector privado especializado en el sector financiero.
www.hsbc.com.mx
Mariuz Calvet
@MariuzCalvetR
ELÉCTRICA / PRIVADO JESÚS CARMONA
Ingeniería Eléctrica | MBA Ejecutivo Global de la Universidad de Duke | Programa de Educación Ejecutiva en Harvard Business School.
SU RELACIÓN con la empresa inició hace más de 20 años en Venezuela en cargos en las áreas de Marketing de Producto y Desarrollo de Negocios. Ocupó importantes puestos en Canadá y en Estados Unidos durante nueve años. En 2009 se mudó a Brasil para desempeñarse como director general de APC por y en 2018 llegó México liderar la transformación rentable del negocio de Energía en México y Centroamérica. Ocupa su actual puesto desde abril de 2022.

www.se.com/mx
Jesús Carmona
@SchneiderMX
/ PRIVADO RUBÉN CAMARILLO ORTEGA
CONSULTOR
EN TEMAS DE ENERGÍA
Ingeniero Químico por el Instituto Tecnológico de Aguascalientes | Licenciado en Derecho por el Centro de Estudios Superiores del Estado de Aguascalientes | Maestría en Ciencias Tecnológicas del Petróleo y la Petroquímica por el Instituto Tecnológico de Ciudad Madero
EN EL ámbito político el Partido Acción Nacional lo postuló como Diputado local en la 59 legislatura del Congreso de Aguascalientes. Fue fundador del Instituto Mexicano de Ingenieros Químicos y Consejero de la Confederación Patronal de la República Mexicana (Coparmex), en el estado y en el 2006 fungió como Senador y de 2012 a 2015 como Diputado Federal.
Rubén Camarillo Ortega
ENERGÍA / PRIVADO ARTURO CARRANZA GUERECA
DIRECTOR DE PROYECTOS DE ENERGÍA EN AKZA ADVISORS

Relaciones Internacionales en la Universidad Iberoamericana | Estudios de maestría en administración pública por el INAP
DESDE SU posición desde donde impulsa proyectos públicos y privados en las industrias de los hidrocarburos y eléctrica. Recientemente se desempeñó como asesor principal para un consejero independiente de la CFE. Fue socio consultor en Solana Consultores, donde apoyó al presidente de la firma en la instrumentación de estrategias de negocio en el sector energético. Trabajó como jefe de la Oficina de Presidencia en el INAP.
akza.com
Arturo Carranza

@Art_Carranza

25 Diciembre 2022/Enero 2023 P & E Petróleo&Energía
R 13
HIDROCARBUROS
14 N
PRESIDENTE DE ZONA PARA MÉXICO Y CENTROAMÉRICA DE SCHNEIDER ELECTRIC
15 R
R 16
HIDROCARBUROS
MIGUEL CARREÓN
Economista por el ITAM | Maestría en Política Pública y Gobierno por la Universidad Panamericana | Maestría en Finanzas Internacionales por la Universidad de Columbia
CON GRAN experiencia tanto en la iniciativa privada como el la administración pública, en donde comenzó su carrera, tiene tres años en Baker Hughes y desde julio de 2022 en su actual responsabilidad, en donde es responsable de impulsar el desarrollo y crecimiento comercial en esta región.
www.bakerhughes.com
Miguel Carreón @CarreonMiguel
ENERGÍA / PÚBLICA
EFRAIM CASTELLANOS FRAYRE
DIRECTOR DE ENERGÍA EN SECRETARÍA DE DESARROLLO ECONÓMICO DE DURANGO



Ingerniero Eléctrico por el Instituto Tecnológico de Durango | Maestría en Administración de Energía en el ITESM
ENTUSIASTA DEL uso eficiente de la energía, sistemas de gestión de energía y las energías renovables, promotor de las buenas prácticas en la construcción de instalaciones eléctricas. Es también Director General de Inhor, empresa enfocada en el diseño y realización de proyectos de generación y ahorro de energía eléctrica empleando fuentes renovables de energía.
sedeco.durango.gob.mx
Efraim Castellanos Frayre @IngeCastellanos
ENERGÍA / MEDIO AMBIENTE / PÚBLICA ÁNGEL CARRIZALES LÓPEZ
DIRECTOR EJECUTIVO DE LA AGENCIA DE SEGURIDAD, ENERGÍA Y AMBIENTE
Ingeniero Químico egresado de la Instituto Tecnológico de Ciudad Madero, Tamaulipas
DESDE EL 21 de noviembre de 2019 se desempeña como Director Ejecutivo de la ASEA. A partir del inicio de su gestión, se planteó la importancia de que las actividades del sector se realizaran con pleno respeto al medio ambiente e impulsó el Programa de Compensaciones mediante el cual se busca que los proyectos contribuyan a la protección de los recursos naturales de nuestro país, a través de la asignación de recursos a las Áreas Naturales Protegidas.
www.gob.mx/asea/
HIDROCARBUROS / PRIVADO SONIA CASTELLANOS
DIRECTORA GENERAL SLB MÉXICO Y CENTROAMÉRICA
Licenciatura en Ingeniería Petroquímica por la Universidad América en Bogotá | Maestría en Administración de la Industria del Petróleo y Gas por la Universidad Heriot-Watt en Edimburgo
DIRECTORA GENERAL de SLB México y Centroamérica desde octubre de 2019. Es una líder en el sector de energía con más de 20 años de experiencia en diferentes geografías. Es responsable de las operaciones de la empresa en cuatro países de esta geografía, administrando el conjunto de soluciones de exploración, perforación y extracción para la industria del petróleo y el gas.

www.slb.com
Sonia Castellanos
26 Diciembre 2022/Enero 2023 P & E Petróleo&Energía
/ PRIVADO
REGIONAL LEADER MEXICO & CENTRAL AMERICA EN BAKER HUGHES
R 17
R 18
R 19
R 20

KARLA GRACIELA CEDANO VILLAVICENCIO
 SECRETARIA DE GESTIÓN TECNOLÓGICA Y VINCULACIÓN DEL IER-UNAM
SECRETARIA DE GESTIÓN TECNOLÓGICA Y VINCULACIÓN DEL IER-UNAM
Ingeniera en Sistemas Electrónicos | Maestra en Ciencias Computacionales con especialidad en Sistemas Asistidos por Computadora por el ITESM | Medicina Genómica en el Instituto Nacional de Medicina Genómica | Doctora en Ingeniería y Ciencias Aplicadas con especialidad en Materiales por la UAEM
FUE DIRECTORA Ejecutiva del Grupo Prolaif-Lamothe; Directora General de Desarrollo Científico-Tecnológico del Gobierno del Estado de Morelos; Directora de Proyectos en la empresa Corrosión y Protección Ingeniería y Directora General del Centro Lavín para el Desarrollo de Innovación y Transferencia Tecnológica. Actualmente labora para el Instituto de Enegías Renovables de la UNAM Campus Morelos.
www.ier.unam.mx
Karla Cedano @kcedano
HIDROCARBUROS / PRIVADO SANTIAGO CORONA
DIRECTOR DE ALTOS ENERGETICOS MEXICANOS


Licenciado en Administración de Empresas por la Universidad Anáhuac
SOCIO FUNDADOR de AEMSA, fue uno de los primeros cinco importadores de hidrocarburos bajo la nueva Reforma Energética Mexicana. Ha posicionado a AEMSA como un referente en el mercado por sus precios, servicios y logística. Logró consolidar a AEMSA como un supplier de los grandes distribuidores a nivel nacional, con una cadena de suministro directa con refinerías y traders globales.

www.altosenergeticos.com
Santiago Corona @santiagocoronaa
HIDROCARBUROS / ASOCIACIÓN/CONSEJO MERLIN COCHRAN
DIRECTOR GENERAL DE LA AMEXHI
Ingeniero Civil por el ITESM| Diplomado en Liderazgo de Harvard Business School | Maestrías en Administración de Empresas por London Business School y Columbia Business School
LABORÓ EN la Secretaría de Energía en donde fungió como Director General Adjunto de Análisis y Seguimiento del Sector Hidrocarburos. Previo a unirse a la Secretaría, Merlin trabajó administrando plataformas petroleras terrestres y marinas. Empezó su carrera en Brunei como ingeniero en entrenamiento y de ahí se movió dentro de las filas de SLB por los países de Venezuela, Omán, Emiratos Árabes Unidos, Irak y Arabia Saudita trabajando para clientes como Shell, BP, ENI, ExxonMobil, PDVSA y Saudi Aramco.
www.amexhi.org Merlin Cochran @Cochran_Merlin
HIDROCARBUROS / PRIVADO MARCO ANTONIO COTA VALDIVIA
DIRECTOR GENERAL DE GRUPO TALANZA
Economista por el ITAM | Master en Políticas Públicas por la Universidad de Mánchester
EXPERTO EN hidrocarburos con una destacada carrera en sector público y privado, nacional e internacional. Fundador y director de Talanza Energy, empresa líder en consultoría para el cumplimiento regulatorio especializado, y fundador y director de Eminent, primera empresa en México dedicada a la detección y cuantificación de emisiones de metano. En el plano internacional, es consultor para el Programa de Medio Ambiente de Naciones Unidas y del gobierno colombiano para el diseño e implementación de regulación de emisiones de metano.
talanza.energy
Talanza Energy @TalanzaEnergy
28 Diciembre 2022/Enero 2023 P & E Petróleo&Energía
ALTERNATIVA
PÚBLICO
RENOVABLE /
/
21 N
N 22
23 R
24 N
HIDROCARBUROS / PRIVADO
ALBERTO DE LA FUENTE PIÑEIRUA
PRESIDENTE Y DIRECTOR GENERAL DE SHELL MÉXICO
Licenciatura en Economía y Relaciones Internacionales en el Instituto Tecnológico Autónomo de México (ITAM) | Maestría en Economía e Historia en la Oxford School | Maestría en Administración de Empresas en la Australian School of Business
TRABAJÓ EN la Oficina de Presidencia, Secretaría de Energía y en la Comisión Reguladora de Energía. En 2006 comenzó su carrera en Shell como Gerente de Mercadotecnia en North West Shelf Gas en Perth, Australia; para 2009 recibió el nombramiento de Representante y Asesor de Negocios de Shell en Oman LNG y en Qalhat LNG en Dubai. Desde 2021 es el Presidente el Consejo Ejecutivo de Empresas Globales.
www.shell.com.mx Alberto De La Fuente @Shell
ALDO DÍAZ NUÑO
PRESIDENTE DE LA CÁMARA NACIONAL DE PROFESIONALES EN ENERGÍA FOTOVOLTAICA
Licenciatura en Administración de Empresas y Marketing por el ITESO Universidad Jesuita de Guadalajara | Maestría en Energía y Edificios Solares por la Université Savoie Mont Blanc
SOCIO NOMBRADO de Argos Technology, empresa de seguridad tecnológica, así como socio fundador de Petitte Chérie, marca global de ropa para mascotas. Además es Presidente de Vinculación Empresarial del Centro de Estudios Científicos y Tecnológicos del Estado de Jalisco y Presidente de Toastmaster Club Global.


www.cpef.org.mx
Aldo Díaz Nuño @Aldodiaz
HIDROCARBUROS / PRIVADO ROBERTO DÍAZ DE LEÓN
DIRECTOR GENERAL DE COMBURED
Licenciatura en Administración de Empresas, por el Tecnológico de Monterrey y en la IPADE Business School
MIEMBRO DE Gasored desde 2017, mismo año en que fue nombrado Presidente de la Organización Nacional de Expendedores de Petróleo, la unión de asociaciones de gasolineros más grande de México, con representación en todos los estados en la Repúbica Mexicana. Actualmente también es Director de Combured.
www.onexpo.com.mx Roberto Díaz de León @robertoddel

HIDROCARBUROS / PRIVADO GUILLERMO DIÉZ CEO DE G500
Contaduría en la Universidad Panamericana | MBA en el IPADE | Global Energy Leadership Program en la Rice University en Houston, Texas.
EN SEPTIEMBRE fue nombrado CEO de la cadena de estaciones de servicio G500. Anteriormente, sdes 2015, fue Director General de Corporación G500, gestión durante la cual lanzó de diferentes líneas de negocio, creando múltiples empresas de productos y servicios, así como la campaña social del grupo. Fue parte del equipo negociador con Glencore para la creación de G500 Network, del cual es miembro del consejo directivo.
g500network.com guillermo-diez-barroso

29 Diciembre 2022/Enero 2023 P & E Petróleo&Energía
N 25
N 26
RENOVABLE/ALTERNATIVA / PRIVADO
N 27
28 R
HIDROCARBUROS / PRIVADO
MARIE DJORDJIAN
 DIRECTORA GENERAL TOTALENERGIES MÉXICO
DIRECTORA GENERAL TOTALENERGIES MÉXICO
Master Degree en Finanzas por la Universidad de la Sorbona en París
DE 2007 al 2015 estuvo en la sede parisina de la empresa, alcanzando posiciones directivas en el negocio francés de combustibles de Total, encargándose tanto del tema de fijación de precios como de la optimización del modelo de negocio de la empresa, aportaciones que contribuyeron con el crecimiento de la dirección de Combustibles y Red en Francia. En México (a donde llegó en 2019) ha consolidado la red de gasolineras con casi 400 estaciones de servicio.
totalenergies.mx Marie Djordjian @MDjordjian
JOSÉ ALFONSO DOMÍNGUEZ GIL
PRESIDENTE DE LA UNIÓN MEXICANA DE ASOCIACIONES DE INGENIEROS A.C.


Ingeniero Civil por la UNAM | Cursos y Capacitaciones en el Centro de Educación Continua de la Facultad de Ingeniería de la UNAM
COMENZÓ A participar hace más de 40 años de diversas asociaciones y sociedades de Ingeniería Civil desde su época de estudiante. Ha elaborado varias decenas de Atlas de Riesgo para la Salud en diversas Instalaciones terrestres, embarcaciones, y plataformas marinas, de Pemex Exploración y Producción, así como de empresas del sector privado. Entre otros diversos proyectos. Esrá al frente de la UMAI en el periodo 2020-2023.
www.umai.org.mx
HIDROCARBUROS / PRIVADO HÉCTOR DOMIGUEZ CAMPA
DIRECTOR GENERAL DE SAMSON

Ingeniero en Electrónica y Comunicaciones por el IPN
DIRIGE LA filial de la empresa alemana (con más de 100 años de experiencia en válvulas). Con sede en el Estado de México, coordina la importación, venta y distrubución a todo el país.
www.samson.com.mx
@samsoncontrol
ENERGÍA / PRIVADO STEPHAN DROUAUD
TRION PROJECT DIRECTOR,
WOODSIDE ENERGY
Ingeniero Químico por la Universidad de Nantes, Francia
TIENE MÁS de 28 años de experiencia en la industria de Oil & Gas, especializándose en el desarrollo y ejecución de proyectos costa afuera y en tierra. Se incorporó a BHP en el 2006 luego de una carrera de 12 años en Technip. Es parte del equipo de liderazgo de grandes proyectos de Woodside Energy. Actualmente tiene la posición de Vicepresidente / Director del Proyecto de Trion, primer desarrollo de aguas profundas en México. Fue designado en esta posición en el 2019 y es el responsable de llevar el proyecto de Trion a una decisión de inversión final y su posterior ejecución de acuerdo al plan de negocios.
www.woodside.com Stephan Drouaud
Licenciatura en Economía y Relaciones Internacionales en el ITAM | Maestría en Economía e Historia en la Oxford School | Maestría en Administración de Empresas en la Australian School of Business
30 Diciembre 2022/Enero 2023 P & E Petróleo&Energía
29 N
30 R
HIDROCARBUROS / PRIVADO
@UMAI2016 R 31
R 32
ENERGÍA / PRIVADO LUIS FRANCISCO FLORES
MANAGING DIRECTOR Y LOCAL SALES MANAGER HITACHI ENERGY MÉXICO
Ingeniero Eléctrico por la Universidad LaSalle | Maestría en Administración por la UNAM | Maestría en Dirección de Empresas por el IPADE
LUEGO DE una exitosa carrera de casi una década en ABB, en 2020 se unió a Hitachi Energy, en donde -desde 2021- es el Country Manager, empresa con el ambicioso plan de cuadriplicar el uso de la energía renovable para 2030. En 2020, Hitachi y el negocio de Power Grids de ABB se unieron en una empresa conjunta para crear un nuevo líder mundial en tecnologías energéticas.
www.hitachienergy.com/mx/es Luis Flores @hitachienergy
HIDROCARBUROS / PRIVADO CONSTANTINO APOSTOLOS GALANIS MATZAVINOS
DIRECTOR GENERAL DE QUÍMICA APOLLO
Ingeniero Ambiental por la Rutgerts University de Nueva Jersey | Maestría en Administración de Empresas por la Rutgerts University
A LOS 14 años de edad, Constantine Galanis salió de su natal Grecia hacia los Estados Unidos, donde realizó sus estudios y posteriormente al residir en México ocupó la Dirección General de Química Apollo, empresa fabricante de compuestos orgánicos industriales para el sector energético de México y del resto del mundo, donde es Director General desde 2003, con una consolidación nacional e internacional de la compañía.
www.quimica-apollo.com.mx
Constantine Galanis
RENOVABLE/ALTERNATIVA / PRIVADO RAFAEL GARCÍA GUTIÉRREZ
PRESIDENTE DE LA ASOCIACIÓN NACIONAL DE ENERGÍA SOLAR

Ingeniero Químico con doctorado en Física de Materiales
PROFESOR TITULAR de Física Estadística y Nanotecnología en el Departamento de Investigación en Física de la Universidad de Sonora. Su área de investigación son los Materiales Optoelectrónicos nano-estructurados enfocados en la generación de energías limpias y desarrollo sustentable.
www.anes.org.mx
Rafael Garcia-Gutierrez



/ ACADÉMICO/INVESTIGACIÓN GUILLERMO GARCÍA ALCOCER
PROFESOR DEL ITAM
Licenciado en Economía y Maestría en Finanzas por el ITAM
PROFESOR DE tiempo completo en el Departamento de Economía en el ITAM , miembro del Consejo Consultivo del EPRI y de Comexi. Cuenta con más de 13 años de experiencia en el sector energético, se ha especializado en regulación técnica y económica, diseño de políticas públicas, así como evaluación y desarrollo de proyectos industriales. Estuvo al frente de la Comisión Reguladora de Energía de México (CRE) entre abril de 2016 y junio de 2019, donde impulsó regulaciones para fomentar la adopción de energías limpias, ampliar las opciones de suministro, y generar mejores condiciones de acceso, precio y calidad para los consumidores.
www.itam.mx/ Guillermo I. García Alcocer @garcialcocer
31 Diciembre 2022/Enero 2023 P & E Petróleo&Energía
R 33
34 N
35 R
RENOVABLE/ALTERNATIVA
36 N
GAS / PRIVADO
JOSÉ GARCÍA SANLEANDRO
PRESIDENTE DE LA ASOCIACIÓN MEXICANA DE GAS NATURAL |PRESIDENTE DE NATURGY BAN

Ingeniería Industrial y cuenta con diversos estudios de especialización directiva en el Instituto de Estudios Superiores de Empresa (IESE)
SANLEANDRO ES Ingeniero industrial, nacido en España, inició su carrera en Naturgy hace más de 30 años y desempeñó diversos cargos y posiciones en España y en Latinoamérica, donde desarrolló una trayectoria en los distintos mercados en los que Naturgy Energy Group está presente. Este año fue ratificado al frente de la AMGN y designado en Naturgy responsable de los negocios de redes para Latinoamérica, estando a su cargo la operación de Naturgy Energy Group en México, Panamá, Chile, Brasil y Argentina.

www.amgn.mx
Asociación Mexicana de Gas Natural @AMGNMx
/ PRIVADO RAFAEL
GARCÍA CORDOVA
VICEPRESIDENTE DE RELACIONES DE GOBIERNO Y GRUPOS DE INTERÉS TC ENERGÍA
Licenciatura en Economía por el ITAM | Maestría en Políticas Públicas por la Universidad de Georgetown | Maestría en Ingeniería Industrial y Economía del Petróleo por el Instituto Francés del Petróleo | Programa de Liderazgo por la Universidad de Harvard
ESTÁ AL frente del equipo más gramde de relación con gobierno y grupos de interés en el país. Fue Líder del Comité de Asuntos Externos de AMEXHI, donde encabezó la tarea de coordinar las relaciones entre Gobierno Federal y actores del sector. Anteriormente y durante 14 años, ocupó diversos puestos en Pemex.
www.tcenergia.com
Rafael Garcia

HIDROCARBUROS / PRIVADO CARLOS GARCÍA DIRECTOR GENERAL DE VALERO MÉXICO
Licenciatura en Contabilidad de la Universidad de Indiana | Maestría en Administración de Empresas de la Universidad de Michigan, Ross School of Business
TAMBIÉN VICEPRESIDENTE de Operaciones Comerciales en América Latina, cuenta con más de 25 años de experiencia profesional en el sector energético. Antes de incorporarse a Valero, se desempeñó como Vicepresidente de Comercialización de Gas Natural de BP para México, y fue Director General de Frontera Energy, despacho de consultoría en energía la cual fue fundador.
valero.com.mx Carlos Garcia @ValeroEnergy
CONSULTORÍA / PRIVADO ENEIDA GÓNGORA SÁNCHEZ
DIRECTORA GENERAL DE OPTIMUM PROJECTUS CONSULTING

Economista por la Universidad Juárez Autónoma de Tabasco | Master en Economía Aplicada por la Universitat Pompeu Fabra
TAMBIÉN COLSULTORA de Talanza, ha trabajado en México, Estados Unidos, Canadá, Colombia, Perú, Argentina, Chile, Brasil y Uruguay mayormente en el sector privado. Relevante experiencia profesional en el subsector de hidrocarburos (upstream y midstream). Tiene amplia experiencia en Dirección de Proyectos, Inteligencia Comercial y Competitiva y Desarrollo de Negocios para Latinoamérica.
optimumcs.com
Eneida G
32 Diciembre 2022/Enero2023 P & E Petróleo&Energía
N 37
N 38
GAS
N 39
40 R
MIRIAM GRUNSTEIN DICKTER
SENIOR PARTNER BRILLIANT ENERGY CONSULTING
Licenciada en Derecho por el ITAM | Licenciada en estudios latinoamericanos por la Universidad de Nuevo México | Maestra y Doctora de la Escuela de Ciencias y Artes de New York University
DENTRO DEL sector energético inició como asesora en la Comisión Reguladora de Energía, donde formó parte de importantes equipos de trabajo dedicados al análisis jurídico de disposiciones legales y reglamentarias en materia energética y administrativa. También realizó trabajos relacionados con instrumentos de regulación de directivas y otros instrumentos contractuales como Términos y Condiciones Generales de Contratación y Condiciones Generales de Servicio para proyectos energéticos de gran escala (de Petróleos Mexicanos, Shell, Chevron-Texaco, Sempra).
INNOVACIÓN/TECNOLOGÍA / PRIVADO PABLO
GUALDI
PRESIDENTE Y CEO DE ATIO GROUP
Licenciado en Análisis de Sistemas por la Universidad de Buenos Aires | Especialización en Alta Dirección del IPADE
RECONOCIDO POR el liderazgo alcanzado en la automatización de gasolineras de marcas nacionales e internacionales, desde hace más de 26 años. Hoy en día, más de 5 mil gasolineras de diferentes marcas, 43% del total en México, utilizan ControlGAS. Asimismo, 100% de los 62 aeropuertos comerciales del país utilizan FuelGATE para automatizar el despacho de combustible a pie de avión, al igual que los nueve principales aeropuertos de Colombia y Perú.
www.atiogroup.com.mx Pablo Gualdi @ATIOGroup
/ PRIVADO
IGOR GUILARTE LÓPEZ
MANAGING DIRECTOR MEXICO ZEECO THERME



Ingeniería Electrónica en la Universidad Simón Bolivar | Maestría en Disciplina académica MBA, Finanzas Programa de Gestión Avanzada Nota (PAG XXI) | Programa de Gestión Financiera
LÍDER DE Negocios con MBA y estudios de Ingeniería, 30 años de experiencia en Proyectos de Automatización e Ingeniería en la región de América Latina en los sectores Industrial y Energético (NOC, Oil Majors, IPP); Funciones de presidente, director general, representante legal y desarrollo comercial en México para empresas globales.
www.zeeco-therme.com.mx/
Igor Guilarte López @IgorGuilarte
HIDROCARBUROS / ASOCIACIÓN/CONSEJO ANDRÉS GUTIÉRREZ TORRES
PRESIDENTE DE LA ASOCIACIÓN MEXICANA DE PROVEEDORES DE ESTACIONES DE SERVICIO (AMPES)

Ingeniero Químico Industrial por la Escuela Superior de Ingeniería Química e Industrias Extractivas (ESIQIE) del Instituto Politécnico Nacional | Maestro en Nanociencias y Nanotecnología por la Universidad de Córdoba, España
CUENTA CON 14 años de experiencia en el desarrollo, análisis e investigación de la calidad de los petrolíferos. Director General de CIEFSA, laboratorio especializado en análisis químicos de productos petrolíferos. Es también miembro del Instituto de Equipos de Petróleo PEI, de la Asociación Mexicana de Metrología, AMMAC y de la Asociación Mexicana de Proveedores de Estaciones de Servicio en la cual es actual Presidente del Consejo Directivo desde 2020.
www.ampes.mx Andreés Gutiérrez Torres @AmpesMx
33 Diciembre 2022/Enero 2023 P & E Petróleo&Energía
ACADÉMICO/INVESTIGACIÓN
HIDROCARBUROS /
41 N
Miriam Grunstein
42 N
HIDROCARBUROS
43 R
44 N
RENOVABLE/ALTERNATIVA / PRIVADO
ISRAEL HURTADO ACOSTA
PRESIDENTE DE LA ASOCIACIÓN MEXICANA DE HIDRÓGENO

Abogado por la UANL | Finanzas en el ITESM
HA COLABORADO para los sectores público y privado en posiciones estratégicas de alto liderazgo, entre las que destacan: jefe de la Unidad de Asuntos Jurídicos de la Secretaría de Energía; secretario de los Consejos de Administración de Petróleos Mexicanos y de la Comisión Federal de Electricidad; y comisionado de la Comisión Reguladora de Energía. Fue Director Ejecutivo de la Asociación Mexicana de Energía Solar. Actualmente es Presidente Ejecutivo de la Asociación Mexicana de Hidrógeno, y coordinador académico del Diplomado en Derecho Energético en la Escuela Libre de Derecho.
h2mex.org/ Israel Hurtado @israelhurtadoa
HIDROCARBUROS / PRIVADO SANDRA JAHNSEN
CEO DE JAHNSEN BUSINESS CONSULTING & CORPORATE

Mercadotecnia Internacional London school of Marketing
HA DESTACADO por ser una de las primeras mujeres en promover la tecnología, capacitación y prevención de accidentes en el sector energético, autora del taller ‘Alza la voz la Seguridad inicia contigo (MR)’ impartido en Pemex y en el sector privado, tiene estudios diversos en seguridad industrial por el país Estados Unidos, Noruega, Reino Unido y México, siendo una especialista con amplia experiencia en esta área.
www.jbc.no Sandra Jahnsen @sjahnsen
RENOVABLE/ALTERNATIVA /
PÚBLICO
GEORGINA IZQUIERDO MONTALVO
 DIRECTORA GENERAL DEL INSTITUTO NACIONAL DE ELECTRICIDAD Y ENERGÍAS LIMPIAS (INEEL)
DIRECTORA GENERAL DEL INSTITUTO NACIONAL DE ELECTRICIDAD Y ENERGÍAS LIMPIAS (INEEL)

Licenciatura en Química, Universidad Nacional Autónoma de México | Cursos de la Maestría en Cerámica, Facultad de Química, UNAM | Doctorado en Química del Estado Sólido (Ph D), Universidad de Aberdeen, Escocia
INVESTIGADORA DE la Gerencia de Geotermia del Instituto Nacional de Electricidad y Energías Limpias desde 1981. Responsable del laboratorio de rayos-X y emisión, así como del laboratorio de petrografía y microtermometría. Participó en los proyectos macro apoyados por fondos Conacyt-Sener: CEMIEGeo y GEMex. Fungió como encargada del despacho de la Gerencia de Geotermia del INEEL. Miembro permanente del Comité de Ética del INEEL, 3 periodos. Miembro del Sistema Nacional de Investigadores desde la primera generación.
www.ineel.mx Instituto Nacional de Electricidad y Energías Limpias @INEEL_MX
HIDROCARBUROS / PRIVADO NICOLÁS JARAMILLO PARRA
Abogado por la Universidad del Rosario, Bogotá
LIDERA LAS inversiones y operaciones de MNJ Capital, organización con más de un cuarto de siglo de experiencia en la originación, estructuración y gestión de cartera en proyectos del sector energético. Es responsable de las recomendaciones de inversión y las relaciones con las contrapartes Navix y Axis.
www.mnjcapital.com.mx Nicolás Jaramillo Parra
34 Diciembre 2022/Enero 2023 P & E Petróleo&Energía
45 N
N 46
N 47
CEO DE MNJ CAPITAL
N 48

HIDROCARBUROS / PRIVADO MARTIN JUNGBLUTH
DIRECTOR GENERAL WINTERSHALL DEA MÉXICO
Geólogo por la Universidad de Kiel
CUENTA CON 25 años de experiencia en el sector de extracción y producción y es desde 2021 Director General de Wintershall Dea México, habiendo sido antes (2019-21) Vicepresidente Senior de Gestión Integrada de Yacimientos y anterior a ello (2017-19) Gerente de Nuevas Empresas en México

wintershalldea.com Martin Jungbluth @jungbluthmartin
/ PÚBLICO ANDRÉS LANKENAU MARTÍNEZ
CHAIRMAN & CEO AT GRUPOELEFANTE
Licenciado en Ciencias Jurídicas en Universidad Cervantina | Diplomado en Derecho Fiscal en la Facultad Libre de Derecho de Monterrey |LLMK Maestría en derecho y negocios en la Northwestern University School of Law & Kellogg School of Management

FUE UNO de los empresarios que fomento la creación del Mercado Eléctrico Mayorista desde que se encontraba como iniciativa de ley. De 2020 a 2022 fue Presidente de la Asociación de Comercializadores de Energía y hasta septiembre 2022 fue tambiénPresidente y Director General de Enicon Energy, primer Comercializador no suministrador del país, así como uno de los Suministradores de Servicios Calificados líderes en México.
www.grupo-elefante.com
Andres Lankenau

@LankenauAndres
ELÉCTRICA / PÚBLICO INDIRA KEMPIS MARTÍNEZ
SENADORA POR NUEVO LEÓN E INTEGRANTE DE LA COMISIÓN DE ENERGÍA DEL SENADO DE LA REPÚBLICA
Maestra en Administración Pública y Política Pública

SECRETARIA DE la Comisión de Desarrollo Urbano, Ordenamiento Territorial y Vivienda e integrante de las comisiones de Economía, para la Igualdad de Género, de Turismo y de Asuntos Fronterizos y Migratorios. Es una de las legisladoras más activas en la cámara alta de nuestro país.
www.senado.gob.mx Indira Kempis @IndiraKempis
/ PRIVADO STEFAN LEPECKI
DIRECTOR GENERAL BRASKEM IDESA
Ingeniero Mecánico por la Universidad Federal del Río de Janeiro | MBA por la Fundación Getulio Vargas de Brasil
DURANTE SUS 30 años de experiencia en el negocio petroquímico, ha incursionado en actividades de las áreas de ingeniería, planeación, finanzas y tecnología de la información. Fue responsable por la implementación del Proyecto del Complejo Petroquímico de Braskem Idesa desde su inicio en 2010 hasta el inicio de operaciones en 2016. Braskem Idesa opera el mayor complejo petroquímico de México, localizado en el sureste de Veracruz.
ww.braskemidesa.com.mx
Stefan Lepecki
@BraskemIdesa
36 Diciembre 2022/Enero 2023 P & E Petróleo&Energía
49 R
50 N
INNOVACIÓN/TECNOLOGÍA
51 R
RENOVABLE/ALTERNATIVA
52 R

/ PRIVADO RODRIGO LOBO MORALES
PRESIDENTE DEL CONSEJO DE GRUPO PROTEXA
Licenciado en Administración Industrial por la Universidad Estatal de Luisiana
INGRESÓ AL Grupo en 1978 y asumió las riendas de Protexa en 2016; desde entonces impulsa la transformación de esta firma regiomontana que participa en los sectores energético, industrial e inmobiliario. Bajo su presidencia han desarrollado los proyectos más importantes de infraestructura petrolera costa afuera, han regresado a la perforación ejecutando proyectos en tiempo récord, como el semisumergimiento de embarcaciones y estructuras para la instalación costa afuera. En 2020 dejó la Dirección General para solo estar al frente del Consejo.
www.protexa.mx Protexa Oficial @protexa
ELÉCTRICA / PRIVADA ANA LAURA LUDLOW ECHEVERRÍA
Licenciatura y de Maestría en Administración en el ITESM


CUENTA CON más de 22 años de experiencia en el sector energético en México y EUA. Haocupado diversos cargos en el mercado del gas natural, tanto en la distribución, transporte y comercialización así comoen el mercado eléctrico, tanto en la generación como en el suministro. Su posición actual incorpora la vinculación institucional, la comunicación & branding, responsabilidad social y sustentabilidad de ENGIE México.
www.engiemexico.com ludlowanalaura
HIDROCARBUROS / PÚBLICO PAOLA ELIZABETH LÓPEZ CHÁVEZ
SUBDIRECTORA DE MANTENIMIENTO, LOGÍSTICA E INFRAESTRUCTURA COMPLEMENTARIA PEMEX EXPLORACIÓN Y PRODUCCIÓN

Ingeniera Petrolera por la UNAM
CUENTA YA con una amplia trayectoria en el sector energético de nuestro país, su área es clave en el desarrollo de la producción de hidrocarburos y de desarrollo e implementación eficaz de programas sociales a través de sus mecanismos contractuales tal como lo es el Programa de Apoyo a la Comunidad y Medio Ambiente.
www.pemex.com
Paola Elizabeth López Chavez

HIDROCARBUROS / PÚBLICO NÉSTOR MARTÍNEZ ROMERO
COMISIONADO DE LA COMISIÓN NACIONAL DE HIDROCARBUROS (CNH)
Doctor en Ingeniería Petrolera egresado de la Facultad de Ingeniería, de la UNAM, con mención honorífica
CON 42 años de experiencia laboral en áreas operativas, de regulación técnica, administrativas, de investigación científica y de docencia. Ocupó posiciones importantes en el IMP, Pemex PEP y la UNAM. Desde 2012 es Comisionado por nombramiento del Ejecutivo Federal. Fue Presidente Nacional del CIPM, Presidente de la Comisión de Especialidad de Ingeniería Petrolera de la Academia de Ingeniería, miembro de la Academia Panamericana de Ingeniería y Presidente Nacional de la Asociación de Ingenieros Petroleros de México.
www.gob.mx/cnh Néstor Martínez Romero @CNH_MX
38 Diciembre 2022/Enero 2023 P & E Petróleo&Energía
HIDROCARBUROS
53 N
54 R
VICEPRESIDENTA DE ASUNTOS GUBERNAMENTALES Y SUSTENTABILIDAD ENGIE MÉXICO
55 R
56 N
LEOPOLDO VICENTE MELCHI GARCÍA
COMISIONADO PRESIDENTE DE LA COMISIÓN REGULADORA DE ENERGÍA
Ingeniero Químico, por la Universidad Veracruzana | Diplomados en Administración Directiva D-2 en el IPADE | Instrumentos de Política Ambiental y Protección Ambiental en la UAM |Uso eficiente del agua y Control de Calidad en la UNAM
RECONOCIDO POR su trabajo como asesor de seguridad industrial para la puesta en marcha de la Planta Derivados Clorados III y encargado de despacho de la Subgerencia de operaciones, ambos en el Complejo Petroquímico de Pajaritos. En el Complejo Petroquímico La Cangrejera, ha sido auditor de Seguridad Industrial y Protección Ambiental, Superintendente de inspección y Seguridad.
www.gob.mx/cre
Leopoldo Vicente Melchi García
@CRE_Mexico
MONROY
CONSULTOR CON 18 años de experiencia en el sector energético. Especializado en regulación, legislación, logística, desarrollo y operación de proyectos, así como análisis económico y de riesgos. Inició su trayectoria en el sector energético con la consultoría IPD Latin America donde desarrollo un enfoque matemático riguroso para la elaboración de modelos analíticos y estructurales de demanda y oferta de hidrocarburos. En 2008, se incorporó a la Subsecretaría de Hidrocarburos en la Secretaría de Energía como Director General Adjunto de Planeación. En 2010, empezó a desarrollar proyectos pioneros de energía eólica. En 2012, fundó GMEC, donde ha asesorado a empresas nacionales e internacionales para participar en el nuevo mercado energético mexicano.
www.gmec-ee.com
Gonzalo Monroy GMonroyEnergy
PRIVADO ÓSCAR MENDOZA REBOLLEDO
 DIRECTOR
MÉXICO
DIRECTOR
MÉXICO
Doctor Honoris Causa, Maestría en Gestión de Proyectos Energéticos por la UVM Ingeniería Civil por la UABC|Administrador de Empresas por el CESJVN|Diplomado en Dirección de Proyectos por Innovatium | Diplomado en Alta Dirección de Nuevos Negocios por la UVM |Diplomado en Administración y Gestión de Proyectos Energéticos en laUANL

DESDE HACE más de 15 años funge como Director Gas México de la Compañía Gasoductos y Estaciones del Norte; el pasado 6 de junio de 2019 fue nombrado Director de Gas México & Centroamérica, consiguiendo la exclusividad en el país para la Distribución de Equipo Especializado de varias empresas internacionales. En el pasado fue Gerente de Fabricaciones y Compras en Schlumberger y Gerente de Planta en Actaris Metering Systems.
www.gensa.com.mx Oscar Mendoza @GENSAenergia
HIDROCARBUROS / PRIVADO CARLOS MORALES GIL
DIRECTOR GENERAL PETROBAL
Ingeniero Petrolero por la UNAM | Maestría en Ingeniería Petrolera por la Universidad de Stanford | Curso de especialización en Administración y Evaluación de Proyectos por la Universidad de Harvard
ES UNO de los ingenieros más experimentados que conoce a la perfección las reservas petroleras de México. Fue Director de Pemex Exploración y Producción de 2004 a 2014. Fue colaborador en el Instituto Mexicano del Petróleo, y en el sector privado trabajó como Gerente de Operaciones en Transportación Marítima Mexicana. Además fue miembro del Consejo Directivo de la Society of Petroleum Engineers, y líder del Colegio de Ingenieros Petroleros de México y de la Asociación Mexicana para la Energía y Desarrollo Sustentable.


www.petrobal.com.mx
Carlos A Morales Gil @PetroBalOficial
39 Diciembre 2022/Enero 2023 P & E Petróleo&Energía
HIDROCARBUROS / PÚBLICO
57 N
GAS /
DE GAS MÉXICO GENSA Y VICEPRESIDENTE EJECUTIVO DE LA ASOCIACIÓN DE INDUSTRIALES UNIDOS POR
N 58
HIDROCARBUROS / PRIVADO GONZALO
SOCIO DIRECTOR EN GMEC
Economista por el ITAM
N 59
N 60
HIDROCARBUROS / PÚBLICO HÉCTOR MOREIRA RODRÍGUEZ
COMISIONADO DE LA COMISIÓN NACIONAL DE HIDROCARBUROS
Licenciado en Ciencias Químicas e Ingeniería Química por el ITESM | Doctorado por la Universidad de Georgetown | Diplomado en Administración Universitaria en la Universidad de Warwick
LE RESPALDA una carrera de década y media en el sector energético, como Subsecretario de Planeación Energética y Desarrollo Tecnológico y luego como Subsecretario de Hidrocarburos en la Secretaría de Energía. Fue también Consejero Profesional en el Consejo de Administración de Pemex, así como Consejero del Instituto Mexicano del Petróleo, del Instituto de Investigaciones Eléctricas, del Centro de Investigaciones y Docencia Económicas, y autor de varias publicaciones de planeación del sector energético.
www.gob.mx/cnh
Comisión Nacional de Hidrocarburos @CNH_MX
ELÉCTRICA / PÚBLICO
RICARDO OCTAVIO MOTA PALOMINO

 DIRECTOR DEL CENTRO NACIONAL DE CONTROL DE ENERGÍA
DIRECTOR DEL CENTRO NACIONAL DE CONTROL DE ENERGÍA
Ingeniero Electricista por la Escuela Superior de Ingeniería Mecánica y Eléctrica del IPN | Maestro en Ciencias en Ingeniería Eléctrica por el IPN | Doctor en Ingeniería Eléctrica por la University of Waterloo
SE HA destacado como director de la Escuela Superior de Ingeniería Mecánica y Eléctrica (ESIME, Unidad Zacatenco) del IPN, donde también fungió como jefe de la Sección de Posgrado e Investigación y Subdirector Académico. Asimismo, en la Comisión Federal de Electricidad (CFE) fue jefe de la Oficina de Operación a Corto Plazo y encargado de Despacho en el Cenace.
www.gob.mx/cenace
@CenaceMexico
HIDROCARBUROS / PRIVADO ABRIL MORENO
SOCIA DIRECTORA DE PERCEPTIA21

Licenciatura en Periodismo por la escuela de periodismo Carlos Septién García | Maestría en Responsabilidad Social por la Universidad Anáhuac del Norte | Maestría en Comportamiento Político por la Universidad de Essex
SOCIA FUNDADORA y Directora General de Perceptia21, y tambiénsocia Fundadora y Directora de Relaciones Públicas de la empresa Worldwide Education Experience. Encabezó el área de Cumplimiento y Relaciones con Gobierno la Dirección Jurídica de Grupo Martí y como cabeza de Relaciones Públicas y Responsabilidad Social de Abbott Laboratories de México. Durante poco más de seis años se desempeñó como asesora de la Dirección General de Pemex. Coordinadora de Comunicación de Xóchitl Gálvez cuando buscaba la gubernatura de Hidalgo. www.perceptia21.com.mx Abril Moreno @Abril_More
ENERGÍA / PÚBLICO ROCÍO NAHLE GARCÍA
SECRETARIA DE ENERGÍA
Ingeniero Química por la Universidad Autónoma de Zacatecas | Diplomado en Ingeniería Química en Procesos por la UNAM | Diplomado en Viabilidad Económica en Procesos Industriales por la Universidad Veracruzana
TIENE BAJO su responsabilidad la política energética del país, donde, si bien la Refinería Olmeca roba los reflectores, hay otras tantos proyectos en su cartera, lo mismo de electrificación como de gas natural y petroquímica. Los movimientos políticos la podrían llevar a abandonar la SRE en busca de una candidatura a la gobernatura de su estado natal.
www.gob.mx/sener Rocío Nahle
@rocionahle

40 Diciembre 2022/Enero 2023 P & E Petróleo&Energía
N 61
N 62
63 R
64 N
ELÉCTRICA / PRIVADO
JOSÉ LUIS NAVARRO HERMOSO
COUNTRY MANAGER DE MANAGER ENEL MÉXICO
Ingeniería Industrial por la Universidad de Extremadura | Ingeniería Mecánica por la VIA University de Dinamarca | PhD en Ingeniería Electrónica Industrial y en Telecomunicaciones y Máster en Electrónica por la Universidad de Sevilla
CON 10 años de trayectoria profesional, se incorporó al Grupo en 2018 a través de Enel Green Power España, al frente de Enel México, tiene el objetivo de liderar la transición energética en el mundo mediante la sinergia con las instituciones estatales para garantizar el acceso a energía con un coste adecuado para los ciudadanos y empresas mexicanas.
www.enel.mx
Jose Luis Navarro Hermoso
TANIA ORTIZ MENA LÓPEZ NEGRETE
PRESIDENTA DE SEMPRA INFRAESTRUCTURA PARA MÉXICO
Licenciada en Relaciones Internacionales por la Universidad Iberoamericana | Maestría en Relaciones Internacionales por la Universidad de Boston
PRESIDENTA DE Sempra Infraestructura para México y Presidenta de Grupo, Energías Limpias e Infraestructura Energética. Tania lidera las actividades de la empresa relacionadas con la generación de energía limpia, así como con el transporte y distribución de gas natural y almacenamiento de productos refinados en América del Norte. Antes fue directora general de IEnova ( subsidiaria de Sempra en México) de 2018 a 2021, y miembro del Consejo de Administración desde 2019.

semprainfrastructure.com
Sempra Infraestructura
@SempraInfra_MX
HIDROCARBUROS / PRIVADO RICARDO ORTEGA LÓPEZ
Licenciatura en Mercadotecnia
NACIÓ EN Poza Rica, Veracruz, es el menor de siete hijos del empresario Noe Ortega. Es considerado uno de los más jóvenes en este giro en México. A partir de la reforma energética, tuvo la oportunidad de desarrollar estrategias que presentó en distintas ocasiones a diferentes directores y empresarios líderes de la industria, desde Oil & Gas Alliance fomenta la inversión, los negocios y vínculos en 11 industrias del sector energía.

www.oilandgasalliance.com Ricardo Ortega @enmerka
HIDROCARBUROS / PÚBLICO MARCO ANTONIO OSORIO BONILLA
DIRECTOR GENERAL DEL INSTITUTO MEXICANO DEL PETRÓLEO

Escuela Superior de Ingeniería Química e Industrias Extractivas del Instituto Politécnico Nacional | Diplomado en Administración de Proyectos por la Universidad Nacional Autónoma de México | Diplomado en Cogeneración por el Colegio Universitario México
HA OCUPADO diversos puestos directivos en el Instituto Mexicano del Petróleo; como director de Tecnología del Producto, encargado de la Dirección Regional Centro y Gerente de Atención a Clientes en las áreas de Proceso, Ingeniería de Proyecto, Proceso y Catalizadores. Hoy está al frente de una de las joyas de innovación e investigación de todo el sector.
www.gob.mx/imp
Marco Osorio Bonilla
@IMPetroleo

41 Diciembre 2022/Enero 2023 P & E Petróleo&Energía
65 R
DIRECTOR GENERAL EN OIL AND GAS ALLIANCE Y PRESIDENTE DE LA COMEXPRO
N 66
ENERGÍA / PRIVADO
N 67
N 68
GAS / PRIVADO
ALEJANDRO PEÓN PERALTA
 DIRECTOR GENERAL DE NATURGY MÉXICO
DIRECTOR GENERAL DE NATURGY MÉXICO
Ingeniero Industrial por la UNAM
EN JULIO del 2020, fue nombrado Director General de Naturgy en México, en donde ha sido responsable de la gestión y desarrollo de proyectos de generación de electricidad y sistemas de distribución de gas natural, promoviendo el desarrollo de este importante energético en más de 52 ciudades donde la compañía tiene presencia. Su gestión al frente de Naturgy México permite impulsar la transformación de la compañía y crear valor a todos los grupos de interés.
www.naturgy.com Alejandro Peón Peralta @NaturgyMx
LUIS GUILLERMO PINEDA BERNAL
COMISIONADO DE LA COMISIÓN REGULADORA DE ENERGÍA
Licenciatura en Derecho por la UNAM | Maestría en Gestión Pública Aplicada por el ITESM | Doctorado en Administración pública por la Atlantic International University
HA DESARROLLADO estudios de posgrado en el Centro de Investigaciones y Docencias Económicas y en el IPADE. Es una de las voces más influyentes dentro del sector pues tiene la visión no solo de la actual administración federal sino un gran sentido de innovación bien aterrizada en las necesidades y posibilidades del país en materia energética.
www.gob.mx/cre
Luis Guillermo Pineda Bernal @G_Pineda_Bernal
 GAS / PRIVADO
GAS / PRIVADO
JENNIFER PIERCE
PRESIDENTA DE TC ENERGÍA


BS por la Universidad de Boston | Maestría en Administración Pública por la Universidad George Wasington | MBA en Rice Business - Jones Graduate School of Business
LA EJECUTIVA canadiense ha ocupado varios cargos ejecutivos a nivel internacional con empresas energéticas de Canadá, Estados Unidos, así como de Chile, Argentina y Brasil. Consolidó a TC Energía como el principal inversionista canadiense en México al concretar una alianza con CFE para la construcción de un gasoducto marítimo por 4 mil 500 mmdd.
www.tcenergia.com Jennifer Pierce @TCEnergia
HIDROCARBUROS / PÚBLICO ALMA AMÉRICA PORRES LUNA
COMISIONADA DE LA COMISIÓN NACIONAL DE HIDROCARBUROS
Ingeniería Geofísica por la UNAM | Maestría y Doctorado en Geofísica Aplicada por la Universidad de Bordeaux
FUE COORDINADORA en el desarrollo de estrategias y rutas tecnológicas para las principales actividades en exploración y explotación de los yacimientos en México. Durante su estancia en la CNH ha sido ponente de temas relacionados con la Evaluación de Pozos Exploratorios en Aguas Profundas, Proyectos de Exploración, Evaluación de Permisos en Exploración Superficial, Regulaciones de Recursos Prospectivos y Soporte Técnico en Exploración para la definición de la Ronda 0 y Ronda 1.
www.gob.mx/cnh
Comisión Nacional de Hidrocarburos
@AlmaAPorresLuna
42 Diciembre 2022/Enero 2023 P & E Petróleo&Energía
N 69
70 R
HIDROCARBUROS / PÚBLICO
71 N
N 72

ELÉCTRICA / PRIVADO SALVADOR PORTILLO ARELLANO
PRESIDENTE DE LA CÁMARA NACIONAL DE MANUFACTURAS ELÉCTRICAS
Ingeniero en Comunicaciones y Electrónica por el IPN
ESTÁ AL frente de las Relaciones Institucionales de Conductores Monterrey así como consultor en proyectos de infraestructura eléctrica y de transporte como de evaluación de empresas de manufactura. Ha ocupado cargos directivos en Alstom, Alstom Transport y Siemens. Su periodo al frente de la Caname concluye en 2023.
caname.org.mx
Salvador Portillo Arellano @canamemx
ROCHA
Licenciatura en Administración y Finanzas por el ITAM | MBA por la NYU Stern School of Business
EMPRENDEDOR, CONSTRUCTOR e inversionista en múltiples sectores. Siempre se ha enfocado en negocios con impacto social y climático, incluida la movilidad limpia, el financiamiento inclusivo, la atención médica y la tecnología. Cuenta con experiencia en identificar tendencias clave del mercado, formar equipos, aportar capital y conectar todas las piezas para transformar grandes ideas en negocios exitosos e impactantes.
www.vemovilidad.com
Roberto Rocha


ELÉCTRICA / PRIVADO VÍCTOR FLORENCIO RAMÍREZ CABRERA
VOCERO DE LA PLATAFORMA MÉXICO CLIMA Y ENERGÍA Y SOCIO DIRECTOR DE PECEPTIA 21 ENERGÍA

Licenciado en Biomedicina por la BUAP | Doctor en Ciencias Biomédicas por la UNAM
DEDICADO AL sector energético y a gestión ambiental y cambio climático. Ha colaborado como asesor en el Senado, así como en la fundación Liberal para el Desarrollo Sustentable. Fue Director Ejecutivo de la Asociación Nacional de Energía Solar y cuenta con experiencia en el sector público y privado en el sector ambiental en gobiernos estatales y municipales; ha participado en diarios como Sexenio, 24 Horas, Diario El Guardian, El Economista, SDP Noticias, la Revista Pensamiento Libre y actualmente colabora semanalmente con la revista Nexos.
www.pmce.mx
Victor Florencio Ramirez Cabrera @vicfc7
HIDROCARBUROS / PÚBLICO MANUEL RODRÍGUEZ GONZÁLEZ
PRESIDENTE DE LA COMISIÓN DE ENERGÍA DE LA CÁMARA DE DIPUTADOS
Licenciado en Derecho | Maestría por la Universidad Juárez Autónoma de Tabasco
POLÍTICO TABASQUEÑO, abogado de profesión y defensor de la ecología y del medio ambiente. Durante tres administraciones estatales fue parte del gobierno local, incluyendo la gestión del actual Secretario de Gobernación.

www.manuelrodriguez.mx
Manuel Rodríguez González @manuel_rdgn
44 Diciembre 2022/Enero 2023 P & E Petróleo&Energía
73 R
74 N
RENOVABLE/ALTERNATIVA / PRIVADO ROBERTO
CEO DE VEMO
N 75
N 76
HIDROCARBUROS
/ PÚBLICO
OCTAVIO ROMERO OROPEZA
DIRECTOR GENERAL DE PETRÓLEOS MEXICANOS
Ingeniero Agrónomo por el Colegio Superior de Agricultura Tropical de Cárdenas | Académico en el Colegio de Ciencias y Humanidades, y de la Universidad Juárez Autónoma de Tabasco
ANTIGUO MIEMBRO del PRD, partido por el cual fue Diputado Federal, hoy está al frente de la mayor empresa del estado, la cual cumplió en 2022 su meta de producción de 1.875 millones de barriles diarios, así como en pago a proveedores por lo cual su ambición de enderezar el barco parece ir por buen camino.

www.pemex.com Pemex @OctavioRomero_O
HIDROCARBUROS / PRIVADO ANGÉLICA RUIZ CELIS
PRESIDENTA Y DIRECTORA GENERAL DE BP EN MÉXICO
Licenciada en Economía por el ITAM | Maestría por el IPADE
ESTÁ AL frente de una empresa en cuto Consejo Directivo tienen mayoría las mujeres. Anterior a su llegada a BP en 2018 fue Vicepresidenta y Directora General para México y Latinoamérica de Vestas; además de Directora Financiera de Petrofac y de Grupo Mexicana de Servicios Subacuáticos.

www.bp.com/es_mx/mexico
Angélica Ruiz @aruiz_celis
GAS
/ PRIVADO
GERARDO ROSAS ORTEGA

 DIRECTOR GENERAL DE COMBUGAS
DIRECTOR GENERAL DE COMBUGAS
FUNDADA EN 1950 por Salomón Issa Murra bajo el nombre de Combustibles y Gases de Torreón, desde 2010 tiene una nueva administración es parte de Grupo SIMSA dentro de su división de Gas LP. Son la única empresa con báscula portátil -verificada por Profeco- en todos sus camiones de reparto de cilindros para pesarlo en presencia del cliente.
www.combugas.com.mx @CombugasOficial
ENERGÍA / ASOCIACIÓN/CONSEJO PAOLO SALERNO
MANAGING PARTNER EN SALERNO Y ASOCIADOS
Licenciado en Derecho por la Universidad Alma Mater Studiorum de Bologna | Estudios de Posgrado en la Universidad Complutense de Madrid | Doctor en Derecho por la Universidad Carlos III de Madrid
SU DESPACHO se ocupa de todos los asuntos relativos a la parte legal, de negocio, infraestructura, descarbonización y capacitación del sector energético, contando con casi 15 años de experiencia en el mismo. Es Consejero de Energía de Index Nacional, Vice-Coordinador del Comité de Derecho Energético de Anade Nacional, Consejero de Relaciones Institucionales del Clúster Energético de Querétaro, Vocal del Comité de Energía de la Cámara Española de Comercio, Profesor - Investigador del Centro ITAM Energía y Recursos Naturales y Profesor del Diplomado de Energía del Instituto de Investigaciones Jurídicas de la UNAM.
www.saenergia.com Paolo Salerno @Paolo_Salerno
45 Diciembre 2022/Enero 2023 P & E Petróleo&Energía
N 77
N 78
N 79
N 80
ENERGÍA / PRIVADO PAUL ALEJANDRO SANCHEZ CAMPOS
SOCIO DIRECTOR PERCEPTIA 21/CFO DE OLEUM
Economista por la UNAM | Maestro en Estudios de América del Norte por la Universidad Autónoma de Sinaloa | Doctor en Política Pública por el ITESM
EN SUS 12 años de trayectoria en el sector energético ha trabajado en los sectores público, privado, académico y social. Ocupó diversas posiciones dentro de Pemex. Su especialidad son las políticas públicas, la planeación estratégica y la gobernanza corporativa en el sector energético abarcando las áreas de electricidad, hidrocarburos y desarrollo social y sustentable.
oem.org.mx
Paul Alejandro Sanchez Campos

 PaulAlejandros
PaulAlejandros
OSCAR
SCOLARI
ROMERO
PRESIDENTE Y DIRECTOR GENERAL DE RENGEN ENERGY SOLUTIONS
Ingeniero por la UNAM
CUENTA CON más 40 años de experiencia en el sector, en los que ha realizado diversos proyectos de ingeniería, procura y construcción para los sectores públicos (CFE, Pemex, Conagua, Gobierno de la CDMX) y privados como Peñoles, Polioles, Marsori. Es representante en México de: MTU Maintenance, PW Power Systems, Powerphase LLC, Babcok & Wilcox, Allen-Sherman-Hoff/Diamond Power, HPI Inc, Chromalox y Vericor Power Systems. También es miembro de la Ampespac y la AMIPE y ha publicado artículos en revistas especializadas además de Strategy Magazine, Forbes y Time Magazine.
www.rengen.com.mx
@RengenEnergy
RENOVABLE / ALTERNATIVA / PRIVADO LUIS GERARDO SÁNCHEZ STONE
DIRECTOR GENERAL EN ERGOSOLAR
Ingeniero en Mecatrónica por el ITESM | Maestría en Biomedicina por la UPAEP | Desarrollo Ejecutivo por el IESDE School of Management
ES EL propietario fundador de ErgoSolar, empresa de sistemas solares fotovoltaicos y eficiencia energética desde 2010, su liderazgo ha llevado a ErgoSolar a ganar el Premio Nacional para el ahorro de energía y a posicionarla dentro de las diez principales compañías de energía solar en México.
www.ergosolar.mx

Luis Gerardo Sanchez Stone
HIDROCARBUROS / PÚBLICO JOSÉ RAMÓN SILVA ARIZABALO COMISIONADO DE ENERGÍA DE TAMAULIPAS
Biólogo por la Universidad del Noreste | Especialista en Geociencias y Bioestratigrafía por el IMP | Maestría en Ingeniería Ambiental por el UNE
SE HA desempeñado exitosamente por más de 18 años en empresas como Pemex Exploración y Producción, el IMP, así como en diversas empresas privadas donde ha sido director general. Como titular de la Comisión de Energía de Tamaulipas tiene la encomienda de tranformarla en la Secretaria de Desarrollo Energético.
www.tamaulipas.gob.mx jose-ramon-silva-arizabalo@JRSAENERGIA

46 Diciembre 2022/Enero 2023 P & E Petróleo&Energía
81 R
R 82
HIDROCARBUROS / PRIVADO
N 83
R 84
ENERGÍA / PRIVADO ALFONSO SOLÍS HACES
Licenciatura en Economía y Licenciado en Derecho por el ITESM| Estudios de Maestría en Administración Pública y Política Pública por la Escuela de Graduados de Administración Pública del ITESM|Especialista en Administración Energética por la EGADE Business School | Maestría en Derecho por la UNAM
CUENTA CON diez años de experiencia en el sector energético en donde ha participado en proyectos emblemáticos de la industria petrolera. Se ha desempeñado como abogado de empresas nacionales y extranjeras liderando equipos jurídicos en México para el establecimiento de sus operaciones. Desde el área de asuntos externos ha sido el encargado de la estrategia de relacionamiento con los gobiernos y las comunidades promoviendo la creación de valor social. Actualmente lidera el equipo de asuntos corporativos de Woodside Energy en México. Desde Junio de 2022, Woodside Energy, empresa de energía Australiana, tiene presencia en México al ser Operador del Campo Trion, en sociedad con Pemex.
www.woodside.com
Alfonso Solis Haces
@WoodsideEnergy
ELÉCTRICA / PRIVADO
MARÍA JOSÉ TREVIÑO
COUNTRY MANAGER DE ACCLAIM ENERGY MÉXICO
MBA del IPADE Business School | Licenciatura en Administración de Negocios de Trinity University | Maestría en Chino Mandarín, en la Universidad de Fudan en Shanghái
MIEMBRO DE COMEXI, miembro del Consejo Consultivo de BBVA para el Estado de Nuevo León, Secretaria del Consejo Fundador de Women’s Energy Network Mexico Chapter, miembro de Voz Experta y miembro del comité de sustentabilidad de la CMIC. También es consejera independiente del Consejo de Administración de Cox Energy Américas, primera empresa de energías renovables que cotiza en bolsa en Latinoamérica.

acclaimenergy.com.mx
Maria Jose Treviño @MariaJoseTrevin
BENJAMÍN TORRES-BARRÓN
Licenciado en Derecho por el Tecnológico de Monterrey | Maestría en Leyes por la Georgetown University Law Center

RECONOCIDO COMO “altamente respetado” por IFLR, y recomendado por Who’s Who Legal para oil & gas y financiamiento de proyectos en México. Es uno abogados líderes del país en el área de energía y recursos naturales por Chambers y Legal 500. Ha sido integrante del Comité de Recursos y Energía Natural del Colegio de Abogados México-Estados Unidos y profesor de Derecho en el Tecnológico de Monterrey. Catedrático de la Maestría de Derecho Energético y Sustentabilidad. Presidente de la Comité de Energía de la American Chamber Of Commerce en México.
www.bakermckenzie.com Benjamín Torres-Barrón @btorresbarron

LUIS VÁZQUEZ SENTÍES
PRESIDENTE DE DIAVAZ

Ingeniería Química en Ryerson University en Toronto, Canadá
SOCIO FUNDADOR y miembro del Consejo de Administración de Diavaz desde 1982 a la fecha. Ha jugado un papel muy destacado en el desarrollo del segmento de servicios profesionales de alta especialización y la proveeduría de insumos y productos que acompaña el crecimiento del sector energético de México. Gracias a su impecable trayectoria profesional y empresarial, Luis Vázquez ha sido invitado a participar en los consejos de diversas empresas nacionales y trasnacionales relacionadas con la industria energética, y adicionalmente participa activamente en distintas Cámaras, Asociaciones y Organismos profesionales y empresariales.
www.diavaz.com DiavazOficial @diavazoficial
47 Diciembre 2022/Enero 2023 P & E Petróleo&Energía
PRINCIPAL CORPORATE AFFAIRS WOODSIDE ENERGY & CHAIR OF EXTERNAL AFFAIRS COMMITTEE IN AMEXHI
R 85
HIDROCARBUROS / PRIVADO
SOCIO DE BAKER & MCKENZIE MÉXICO Y LÍDER DEL PLAN SECTORIAL DE ENERGÍA MINAS E INFRAESTRUCTURA
N 86
N 87
HIDROCARBUROS / PRIVADO
N 88
HIDROCARBUROS / PRIVADO
JUAN PABLO VEGA ARRIAGA
PRESIDENTE DEL CONSEJO DE ADMINISTRACIÓN DE NAVIERA INTEGRAL
Licenciado en Administración de Empresas por la UVM
CUENTA CON una condecoración en Holanda como Oficial en la Orden de Orange-Nassau por su apoyo en las relaciones comerciales entre México y los Países Bajos. Fue miembro Fundador del Consejo Mexicano de la Energía y es también Vicepresidente de Armadores de la Cámara Mexicana de la Industria del Transporte Marítimo. Fue Presidente del Consejo Mexicano del Transporte y Consejero Empresarial de la Universidad de las Américas Puebla.
www.navinsa.com.mx
Juan Pablo Vega


EVELYN VILCHEZ
PRESIDENTE DE AMEXHI / COUNTRY MANAGER DE CHEVRON MÉXICO
Licenciatura en Ciencias de la Información por la Universidad de Tulane | Maestría en Finanzas Corporativas de la Universidad del Zulia en Venezuela.
DIRECTORA GENERAL de Chevron Energía de México, desde marzo del 2017. Promueve las relaciones clave de Chevron en México para ayudar a impulsar el sector de hidrocarburos del país y los intereses de la compañía. Con más de 30 años de experiencia en la industria del petróleo y gas, ocupó posiciones en las áreas de desarrollo de negocios, planificación estratégica y gerencia comercial con Chevron en Venezuela, Angola y Estados Unidos.

www.chevroncontechron.com
Evelyn Vilchez
@AMEXHI_Oficial
HIDROCARBUROS / PRIVADO LUIS VIELMA LOBO
CEO DE CBMX SERVICIOS INGENIERIA PETROLERA
Ingeniero Petrolero y Maestro en Ciencias por la Universidad de Tulsa | Maestría en Gerencia de Procesos por la Universidad de Tennessee
ES UN ejecutivo petrolero con 40 años de experiencia en la rama de negocios en exploración y producción de hidrocarburos. En diciembre de 2020 creó CBM Servicios Ingeniería Petrolera para ampliar su oferta de servicios técnicos a la cadena de negocio mid y downstream. Miembro de la Sociedad Americana de Ingenieros Mecánicos, ASME, Sociedad de Ingenieros de Petróleo, SPE.
www.luisvielmalobo.com Luis Vielma Lobo @ChapopoteNovela
RENOVABLE/ALTERNATIVA / PRIVADO
ELIÉ DAVID VILLEDA OROZCO
HEAD OF LATINAMERICA EN FIRST SOLAR

Relaciones Internacionales por el ITESM | Maestría en Sustentabilidad y Energía por la Universidad de Monash en Australia
LUEGO DE tres años en Fist Solar, en noviembre de 2022 fue nombrado cabeza de América Larina para la empresa. Es experto en energías renovables y medio ambiente. Antes, era el encargado de negocios para México para Emergya Wind Technologies, desarrollando el mercado de turbinas eólicas de gran escala para proyectos de abasto aislado en México.Fue el encargado de energías renovables y medio ambiente para la sección comercial de la Embajada Británica en México.
www.firstsolar.com/es-CSA/
Elie David Villeda Orozco
@Elie_Villeda
48 Diciembre 2022/Enero 2023 P & E Petróleo&Energía
N 89
N 90
HIDROCARBUROS / PRIVADO
R 91
R 92
ELÉCTRICA / PRIVADO
YOLANDA ALICIA VILLEGAS GONZÁLEZ


SOCIA FUNDADORA DE OLEUM SERVICIOS Y DICTAMINACIÓN TÉCNICA, S.A. DE C.V./ DIRECTORA JURÍDICA DE VEMO
Licenciatura en Derecho por el ITESM| Maestría en Derecho Internacional por EGAP del ITESM | Doctora en Ciencia y Tecnología por el ITESM|Diplomados en Cornell University Georgetown University Université de la Sorbonne y Harvard University
DIRECTORA JURÍDICA de VEMO y Socia Fundadora de Oleum. Este año coordinó el libro Energía 205o, Tecnologías Mercados y Regulación, su tercero además de otro en materia de Derechos Humanos, y uno más en temática del agua. Actualmente es Presidenta Nacional de los EXATECs, Consejera de la Universidad Autónoma de Nuevo León. Cuenta con más de 15 años de experiencia en derecho corporativo, internacional, energético, de propiedad intelectual.
www.oleumserviciosdictaminaciones.com
Ph.D. Yolanda Villegas @YolandaVGzz
AIDEÉ
ZAMORA ESPINOLA
CEO GRUPO AMERALI
Ingeniera en Energías Renobables por la UNAM
SOCIA FUNDADORA de Grupo Amerali y Sale Energy Academy, empresas especializadas en proyectos solares y capacitación en ventas de energía. Se enfoca en estrategia comercial en energía solar. Ha liderado proyectos solares fotovoltaicos en generación distribuida, solares térmicos, líneas de proceso para la industria, en el último año ha capacitado a más de 120 personas en ventas solares y asesorado a PYMES en Latinoamérica.
grupoamerali.com Aidee Zamora @az_espinola
RENOVABLE / ALTERNATIVA / PRIVADO JULIAN
WILLENBROCK AHUMADA
CO FUNDADOR Y CEO DE ENLIGHT


Ingeniero Industrial por el ITESM | MEDEX en el IPADE
ENLIGHT TIENE 10 años de experiencia en generación distribuida en México y su CEO cuenta con más de 13 años en la industria fotovoltaica en Alemania, España y México. En 2011 fundó Enlight y hoy en día es la compañía líder en el segmento de generación distribuida fotovoltaica en México, operando actualmente en cinco países en Latinoamérica.
www.enlight.mx Julian Willenbrock @@jwillenbrock
HIDROCARBUROS / PRIVADO PABLO ZÁRATE
DIRECTOR DE PRÁCTICAS ENERGÉTICAS DE COMUNICACIONES ESTRATÉGICAS EN MÉXICO, FTI CONSULTING
Licenciatura en Economía por el ITAM | Licenciatura en Ciencias Políticas por el ITAM | Maestría en Medios y Asuntos Públicos de la Universidad George Washington
DIRIGE LA práctica de Energía Estratégica de Comunicaciones de FTI Consulting en la oficina de la Ciudad de México. Es también Director de Información de Pulso Energético y articulista en El Economista. Antes de unirse a FTI (hace nueve años), se desempeñó como asesor y redactor principal de discursos del Secretario de Energía de México, Jordy Herrera, así como asesor del subsecretario de Planificación Energética, Carlos Petersen.
www.fticonsulting.com
Pablo Zárate @pzarater
49 Diciembre 2022/Enero 2023 P & E Petróleo&Energía
N 93
R 94
RENOVABLE / ALTERNATIVA / PRIVADO
R 95
N 96
HIDROCARBUROS / PRIVADO JOSÉ LUIS ZAVALA SOLÍS
PRESIDENTE CORPORATIVO DE CEMZA

Ingeniería Industrial y de Sistemas por el ITESM | MBA por la Escuela Superior de Comercio de Niza
FUNDADOR Y accionista de la compañía para CEMZA Group Soluciones integrales para la industria Offshore: Petronaval, Marinsa, Bistro, Presco, Enenmar, Oceamar, Martel, Maren. Accionista y asesor de; Reparaciones Navales Zavala S.A. de C.V. y Júpiter Suministros y Servicios. Fue también Gerente General de 1997 a 1998 en Reparaciones Navales Zavala de Ciudad del Carmen, Campeche.
www.cemza.com
@JosLuisZavalaS2
ABRAHAM ZEPEDA REYNA
GRUPO HOSTO es un contratista EPC mexicano. Destaca por su participación en concursos y licitaciones, como el consorcio operativo en un bloque de la Cuenca de Burgos y su implicación en el desarrollo de la Refinería Olmeca.
www.grupohosto.com.mx
@GrupoHOSTO
HOSTO
HIDROCARBUROS / PRIVADO ALICIA ZAZUETA PAYAN
DIRECTORA GENERAL DE EQUIPOS Y SERVICIOS INDUSTRIALES GENERALES Y VICEPRESIDENTA DE AMPES

Licenciada en Derecho por la Universidad Humanitas
ESPECIALISTA EN el cumplimiento normativo con los distintos órganos que regulan a estaciones de servicio en Mexico. Trabaja dentro de su empresa y de la AMPES por la mejor capacitación de todo el sector gasolinero y de su cadena de valor.
ampes.mx
Alicia Zazueta
@AliciaZtaPayan
RENOVABLE / ALTERNATIVA / PRIVADO
SIMON ZHAO
CEO DE SOLAREVER
Licenciado en Ciencias, Ingeniería en Manufactura por la Universidad de Ciencia y Tecnología de Huazhong

CON LA intención de ser el ‘Tesla de la energía solar’, Solarever es uno de los más importantes actores en este sector, desde donde han saltado a la industria automotriz y a la vital preparación de profesionales en este rubro.
solarever.com.mx
Simon Zhao
@Solarever

50 Diciembre 2022/Enero 2023 P & E Petróleo&Energía
N 97
R 98
GAS / PRIVADO
DIRECTOR DE DESARROLLO DE NEGOCIOS DE GRUPO
R 99
R 100


EL HIDRÓGENO
VERDE,
CLAVE DE IBERDROLA PARA LOGRAR UNA TRANSICIÓN ENERGÉTICA
Iberdrola México es una empresa comprometida con la innovación tecnológica como eje central de la transición energética en nuestro país, desarrollando soluciones que permitan una mayor eficiencia económica y de procesos en la industria.
Hace más de 20 años, Iberdrola inició operaciones en México, con el objetivo estratégico de contribuir al desarrollo energético sostenible del país, invirtiendo con fuerza para el aprovechamiento de los recursos naturales, y reducir el impacto ambiental.
Actualmente, nuestras instalaciones de energía renovable suman 7 parques de energía eólica (693MW), y 3 parques fotovoltaicos (470MW), con ubicaciones estratégicas en los estados de Oaxaca,

Puebla, Guanajuato, Sonora, y San Luis Potosí, y que suministran a industrias tan diversas como la automotriz, minería, manufactura y retail, entre otras.
Además de la generación de energía aprovechando las energías renovables, Iberdrola está trabajando en procesos de innovación tecnológica para apoyar a la industria a alcanzar sus objetivos de descarbonización, con un enfoque sensible al desarrollo sostenible, e identificando las oportunidades y necesidades actuales.

52 RENOVABLES IBERDROLA Diciembre 2022/Enero 2023 Petróleo&Energía
F. Izquierdo
Redacción Cortesía
En este sentido, Iberdrola está invirtiendo en el desarrollo de proyectos para la obtención de hidrógeno verde, es decir, con cero emisiones de CO2.
El hidrógeno es el elemento más abundante en la Tierra, es un combustible universal, ligero y muy reactivo, pero difícilmente se encuentra aislado. Los procesos industriales empleados hasta el día de hoy para obtener este gas son poco sostenibles, sin embargo, el hidrógeno verde se posiciona como una gran alternativa, alineada con los objetivos de descarbonización industrial.
El hidrógeno verde se llama así porque durante el proceso para obtenerlo no se emite dióxido de carbono al ambiente. Su producción se lleva a cabo mediante la electrólisis, un proceso químico en el cual se separa el hidrógeno del oxígeno que hay en el agua.
La electrólisis necesita de electricidad (como su nombre lo indica), y ésta se puede generar a través de sistemas eólicos y fotovoltaicos. Como resultado de este proceso, en el que no hay emisiones contaminantes, obtenemos hidrógeno y oxígeno. El hidrógeno se puede emplear en diferentes industrias como combustible, mientras que las partículas de oxígeno se liberan al ambiente o, de requerirlo, se utilizan en otros procesos industriales. Además, el hidrógeno es de fácil almacenamiento, y puede transportarse por los mismos canales e infraestructura que el gas natural.
Iberdrola ya tiene proyectos avanzados en la materia en América y Europa, y pretende posicio-

narse como líder mundial de esta tecnología. El grupo se sitúa así al frente del nuevo reto tecnológico que supone la producción y el suministro de hidrógeno a partir de fuentes de energía limpias, utilizando electricidad 100 % renovable en el proceso de electrólisis.
En México ya nos encontramos en la fase de investigación y estudio de proyectos para empresas interesadas en descarbonización, tanto para la utilización de hidrógeno verde como combustible, así como para proyectos de movilidad.
Iberdrola México trabaja diariamente para que nuestro país se una al esfuerzo global de aprovechar al máximo las energías renovables, y así entregarles a las siguientes generaciones un futuro mucho más limpio.



53 petroleoenergia.com Diciembre 2022/Enero 2023
JORGE ANCHEYTA
GERENTE
DE
PRODUCTOS PARA LA TRANSFORMACIÓN DE CRUDO EN EL IMP
Poco antes de cerrar esta edición, el Instituto Mexicano del Petróleo hizo público el desarrollo del Catalizador IMP-DSD-30 capaz de producir diésel de ultra bajo azufre (DUBA), necesario para las regulaciones que entrarán en vigor próximamente.

Ancheyta nos relató que este catalizador “comenzó su desarrollo con proyectos financiados por el fondo Conacyt-Sener-Hidrocarburos, ahora extinto, con investigadores de aquí del instituto, de la Dirección de Investigación en Transformación de Hidrocarburos”.

Al término de esos proyectos, se identificó que aquellos proyectos habían sido exitosos y la Dirección a cargo de Jorge comenzó a tener reuniones y escalamientos con las áreas que correspondían.
Año y medio tardaron en dar con el producto correcto, después de pruebas y errores, “porque a nivel laboratorio pueden resultar bien las cosas, pero para su aplicación industrial se introducen más variables, una de ellas era un reactivo que se usó en laboratorio no estaba permitido utilizar a nivel industrial”.

El resultado después de todas las pruebas no solamente fueron exitosos a nivel que se producía azufre ultra bajo de azufre sin sacrificar la cantidad de producción e incluso más: a precios competitivos.
La Normativa que Viene
La gran mayoría de las plantas de Pemex fueron diseñadas a presiones medianas, de acuerdo al requerimiento de ese momento, el Diesel Zinc tenía 500 partes por millón de azufre; después pasaron al Diesel Desulfurado que es de máximo 300 partes por millón y se ajustaron las plantas para ello, “así están operando muchas de ellas en la actualidad”.
En enero de 2025 entrará en vigor la norma NOM-016-CRE-2016, con la cual se regula el contenido de azufre a 15 partes por millón máximo para su uso en todo el país. La preocupación era “¿cómo en esas plantas que fueron diseñadas para 500 partes por millón ahora produzcan Diésel con 15 partes por millón? ¡Es muy bajo! Mientras más le baje uno, más difícil se va haciendo el proceso.
Hasta ahora esto se podía lograr, así como están las plantas, sacrificando producción “siempre existe un compromiso entre calidad y cantidad, lo que están haciendo es producir menos. Nuestro catalizador”, presume con orgullo, “puede producir Diésel UBA así como están las plantas, en las condiciones de diseño original”.
En un caso de libro de texto por lo exitoso, “tenemos la ventana de oportunidad de aquí a principios de 2025, es un producto que entra oportunamente en la necesidad”. Generalmente la labor cotidiana es la de resolver un problema que existe adaptando tecnologías que ya se tienen a la mano, mejorando lo que se tiene, “es raro que tengamos algo que se anticipa”.
El siguiente paso
Al ya tener el catalizador probado en condiciones de mundo real, el siguiente paso fue maquilar a nivel industrial “y sucedió que el producido a nivel industrial resultaba mejor que el de laboratorio, hay razones técnicas, pero aquí resultó mejor, verificado y validado”.
El paso que sigue es introducirlo en una unidad y ahí hay un obstáculo “el mecanismo actual para participar en las licitaciones de Pemex, es que los catalizadores que se oferten tengan una experiencia industrial mínima en los últimos tres años”.
Para poder cumplir con ese requisito de experiencia el IMP está promoviendo una prueba en una planta de Petróleos Mexicanos, concluyendo esa prueba, la cual confían en que salga positiva, “ya se empieza a masificar su uso en todas las plantas, esa es la intención”.
Al ser presentada con esta innovación, la Secretaria de Energía, Rocío Nahle, propuso que el catalizador fuera elaborado en México en una planta nacional “y se ha elegido provisionalmente un lugar ya en Hidalgo”, señala Ancheyta, con lo cual el Catalizador IMPDSD-30 podría tener un impacto positivo mayor a sólo producir Diésel Bajo en Azufre.
54 ENTREVISTAS INSTITUTO MEXICANO DEL PETRÓLEO Diciembre 2022/Enero 2023 Petróleo&Energía
01 EL LABORATORIO 02 EL CATALIZADOR 01 02
Jacobo Bautista F. Izquierdo

TODO LO QUE NECESITAS SABER PARA CONTRATAR GAS NATURAL EN TU EMPRESA
Cada vez son más las empresas que buscan migrar al Gas Natural por sus cualidades amigables en costo, ambiente y seguridad además de ser un pilar para la matriz de generación eléctrica y para las actividades industriales en México y el mundo.
Los precios asequibles del Gas Natural, gracias al auge de la producción en Estados Unidos, específicamente en Texas, así como las bajas emisiones de gases de efecto invernadero (GEI), han incrementado la demanda de este combustible en la última década en el mundo, especialmente en el sector industrial. Entre sus ventajas se encuentran:
• Bajo costo. Es el combustible más competitivo pues representa ahorros de hasta un 40% en comparación al Gas L.P.
• Seguridad. La instalación, distribución y transporte están regulados por las más estrictas normas internacionales que garantizan un alto estándar en cuanto a calidad y seguridad. Además, al ser más ligero que el aire, puede disiparse con mayor velocidad en caso de perdida y dificulta que se genere una concentración con potencial explosivo.
• Menor costo de operación y mantenimiento. El Gas Natural posee una combustión más limpia que no emite residuos sólidos como el hollín.
¿Cómo acceder al Gas Natural?

Debido a su estado gaseoso, el medio de transporte más eficiente del Gas Natural es a través de ductos subterráneos. En nuestro país existe una amplia red de dichos ductos y para los casos donde el volumen de consumo es significativo, la opción ideal es una interconexión directa.
Puedes buscar una conexión directa al Sistema Nacional de Gasoductos a través de Cenegas
56 Diciembre 2022/Enero 2023 Petróleo&Energía
HIDROCARBUROS GAS
Redacción Cortesía Luis E. González
o bien identificar si en la zona existe algún permisionario de transporte o distribución, información que puedes consultar en la página de la Comisión Reguladora de Energía (CRE).
Otra manera de simplificar este paso es consultando el listado de las comercializadoras con permiso por parte de la CRE y solicitar que te presenten una propuesta con todo lo necesario para tener acceso al suministro de gas natural.

Aspectos a tomar en cuenta para la firma de un contrato
• Esquema de consumo de molécula. Dependiendo de cada proceso, es posible conocer cuánto gas se consume diariamente, semanal o mensualmente, así como la estabilidad o variación del consumo. Al recibir una oferta es primordial que esta se ajuste de la mejor forma posible a los hábitos de consumo de la planta donde se va a suministrar, a fin de brindar la mayor certeza o flexibilidad en el suministro. La elección del esquema de consumo de molécula depende de la empresa y su posibilidad de conocer su uso diario o mensual. Para las empresas que tienen certeza de su consumo diario, mensual o anual es recomendable la opción de nominar con anticipación o fijar el mayor porcentaje de sus consumos de Gas Natural. De esta forma pueden acceder a mejores precios. Por el otro lado, también es posible elegir un esquema variable, para tener la flexibilidad de pagar únicamente el gas consumido, sin mínimos de consumo o topes. A mayor flexibilidad de consumo, el precio del gas se va incrementando.
• Costos de transporte y distribución. Al ser costos regulados, se cobran con tarifas públicas que dependen del volumen de consumo. Dichas tarifas pueden ser consultadas en la página de la CRE o de tu distribuidor.
Los costos de transporte son los que aplican por utilizar la red de ductos que llevan el Gas Natural hasta el “City Gate” más cercano y los costos de distribución aplican por llevar el Gas Natural desde el “City Gate” hasta el punto de conexión con su empresa.
Asimismo, es importante considerar la posibilidad de necesitar un nuevo desarrollo de infraestructura para llevar el Gas Natural hasta tu empresa. En este caso es importante tener en cuenta que pueden generarse costos de conexión y el tiempo que tomará la obtención de permisos para hacer esas extensiones. Acércate a tu proveedor de Gas Natural para saber si aplican estos costos y las opciones de pago.
•Plazo del contrato. En el caso de distribución los plazos varían dependiendo del monto de la inversión en infraestructura. Estos plazos pueden estar entre 5 y 10 años. Para el caso de la comercialización de molécula los plazos son más flexibles y de libre negociación entre la empresa y el comercializador. Generalmente van de 1 a 3 años, con opción a renovación.
• Garantías. Existen dos tipos de garantía; una es por consumo y la otra por conexión. La garantía por consumo suele ser equivalente al monto de facturación de los 2 meses de mayor consumo en un año mientras que la garantía de conexión es equivalente al monto de la inversión en infraestructura que hace la distribuidora. Dichas garantías pueden ser una fianza o depósito en efectivo/transferencia.
No olvides que para poder iniciar con el suministro deberás contar además de con la conexión a la red externa con una instalación de aprovechamiento especialmente diseñada para el consumo del gas natural. Seguramente el distribuidor o comercializador podrá sugerirte una lista de instaladores certificados que puedan apoyarte.

Esta instalación debe construirse de acuerdo a la NOM002-ASEA2019 y debe ser aprobada por una Unidad Verificadora acreditada por la CRE. El costo puede variar mucho considerando la distancia entre la estación de regulación y medición que tendrás y los equipos que consuman el gas natural dentro de tu instalación.
Sin embargo, el payback de este tipo de inversiones suele ser menor a un año dado los ahorros que se obtendrán con la migración al gas natural.
Notas
57 petroleoenergia.com Diciembre 2022/Enero 2023
SI ESTÁS LISTO PARA SUMARTE A LA TRANSICIÓN ENERGÉTICA Y REQUIERES EL ACOMPAÑAMIENTO DE UN EXPERTO, UTILIZA EL CÓDIGO QR PARA TENER ACCESO A UNA ASESORÍA PERSONALIZADA
30 AÑOS DE AMPES
La Asociación Mexicana de Proveedores de Estaciones de Servicio A.C. (AMPES) agrupa a los fabricantes y distribuidores en materia de equipo y tecnología especializados, con la finalidad de dotar a los expendedores de combustibles los elementos necesarios para enfrentar los constantes cambios y retos en el sector energético.




Tras acumular 30 años de experiencia, la AMPES replantea el modelo de negocios de las gasolineras en palabras del recién electo Mario Alberto Zamudio, presidente de la Asociación para el período 2022-2023: “El pasado nos ha dejado grandes aprendizajes para ser transformados en acciones contundentes, que nos permiten replantearnos el futuro de las estaciones de servicio en modelos de negocios diferentes a como hoy se conocen”.
A partir de 2023 entran en vigor nuevas especificaciones técnicas para las estaciones de servicio, lo que se traduce en una gran oportunidad para trazar de manera diferente el modelo de negocio tanto para las gasolineras como plantas de abastecimiento y los tanques de almacenamiento en beneficio siempre del servicio que se le brinda al consumidor final.
Por ello, las estaciones de servicio están en marcha de dar cumplimiento a estas nuevas reglamentaciones, lo que ha permitido tener un sector más dinámico y en constante crecimiento, el reto como proveedores de estaciones de servicio es brindar soluciones acordes a las necesidades de los empresarios gasolineros, como la operación
58 HIDROCARBUROS AMPES Diciembre 2022/Enero 2023 Petróleo&Energía
Redacción Cortesía AMPES Luis E. González
Capacitación

• AMPES realiza continuamente seminarios, webinars y distintos eventos para que todo el personal de sus agremiados estén al día en materia de tecnología, seguridad y regulaciones.
diaria, la automatización de los procesos operacionales, el control, la seguridad y la administración del negocio desde la óptica de la innovación, la tendencia para los siguientes años es las estaciones multiservicio con un perfil alto en tecnología y valores agregados.
AMPES está conformada por más de 68 empresas que brindan productos y servicios al empresario del sector energético, bajo los más altos estándares de calidad. Los mismos van desde instituciones bancarias hasta distribuidores de equipo, negocios alternos, software, seguridad, textiles, aditivos y lubricantes, así como constructoras especializadas en el rubro.
El sector de la proveeduría representa 82% de las pymes que da empleo a familias en todo el país.
Constituida como Asociación Civil el 6 de diciembre de 1992, representa además a más de 95% de los proveedores mexicanos de diseño, construcción, equipamiento, tecnologías de informática, constructores y distribuidores de tanques, tuberías, dispensarios, así como empresas de estudios ambientales, consultoría y terceros autorizados del sector de Estaciones de Servicio, entre otras actividades industriales en nuestro país, con una membresía de más de 68 empresas voluntariamente asociadas, de distintos tamaños y segmentos como:
Relaciones cercanas
• La AMPES busca en todo momento estar cerca de los actores relevantes en su sector, estableciendo relaciones con autoridades como la Profeco, la Secretaría del Medio Ambiente, pero también con organismos de vanguardia como el Instituto Mexicano del Petróleo y otras instancias claves como la Secretaría de Hacienda y el SAT (entre otras muchas).

• Constructoras y Servicios Integrales
• Software y Sistemas Administrativos
• Imagen, Señalización y Techumbres
• Análisis químicos de productos petrolíferos
• Servicio e instalación y mantenimiento (plomería, gas, electricidad)
• Fabricantes de Equipos y Tanques
• Distribuidores de Equipos e Instaladores

AMPES se consolida como participante clave de la industria, que aporta la experiencia y conocimiento en áreas de especialidad de sus asociados para el desarrollo y éxito de las estaciones de servicio de nuestro país.
ampes.mx contacto@ampes.mx
55 5687 4888 Y 55 56874802

59 petroleoenergia.com Diciembre 2022/Enero 2023
“El pasado nos ha dejado grandes aprendizajes para ser transformados en acciones contundentes, que nos permiten replantearnos el futuro de las estaciones de servicio en modelos de negocios diferentes a como hoy se conocen”.
A PRUEBA DE TODO
Las industrias petroleras, de gas y minera tienen en común la dificultad de los terrenos donde se realizan las actividades de campo e incluso las oficinas locales (ya que son actividades poco centralizadas por naturaleza) suelen tener ubicaciones poco convencionales.

En un mundo que pretende estar conectado, en estas industrias -y otras tantas parecidas como la pesca o el transporte- las comunicaciones suelen ser complicadas, la cobertura de los carriers que operan en México tienen sus grandes huecos fuera de las grandes masas urbanas y peor aún, equipos más grandes y sofisticados que un celular (tabletas y laptops) suelen quedar desconectadas de la red o peor alguno, estar en peligro de sufrir daños físicos.
Por ello, aquí dos opciones, tanto de telecomunicación como de hardware, que podrían solucionar los problemas de llevar la tecnología de punta a donde las cosas suceden.
Alestra Móvil

Lo más notorio de las soluciones que la compañía mexicana ha puesto en su portafolios es la red multi-operador, es decir, dependiendo de la región, la fuerza de la señal y la necesidad de cada aparato, este se conectará a una de tres redes que tiene disponible, esto sin que el usuario lo note.
Sucede incluso en edificios en las ciudades, cuando hay un piso, una oficina, una región de cubículos donde ‘hay mala señal’ para uno u otro carrier, incluso estas pequeñas lagunas son cosa del pasado con esta innovación.
Y como la redundancia de redes y de respaldo de la información es crítica, Alestra ofrece también servicio de respaldo en la nube, plataformas de misión crítica e inteligencia artificial en sus productos de comunicación móviles, así como herramientas colaborativas (a la carta) y tres niveles de seguridad.
Las capacidades de esta empresa tecnológica se han volcado en este servicio en que las corporaciones pueden asegurar la mejor conectividad de su personal, eficientando los datos en sus operaciones.
Getac

La empresa con sede en Taiwan es líder mundial en equipo robusto. Sus equipos, especialmente tabletas y laptop son fabricados con el objetivo de resistirlo todo, para operaciones en situaciones de exploración, extracción, ya sea de gas, minerales o hidrocarburos, el tener el campo equipos sofisticados cuyo diseño obedece a necesidades estéticas pone en riesgo no solo a los equipos sino a las comunicaciones y operaciones.
Expertos en materiales, se han abastecido de los mejores procesadores en el mercado y su diseño responde al uso rudo que puedan recibir estos componentes en el campo. Todas las conexiones tienen una cubierta para cuando no son usadas, cada ángulo está cubierto, reforzado, hay varias formas de cargar el aparato según las condiciones. No son muy atractivos pero compensan con resistencia el asunto estético.
Getac tiene un amplio portafolios, con productos pensados lo mismo para la contrucción o plataformas marítimas, el rango no solo está en el tipo de industria sino en la capacidad obvia de los aparatos, su procesador y memorias, pero el rango lo da la capacidad informática, no la de protección, pues está siempre está garantizada.
Más información: www.getac.com/latam
60 TECNOLOGÍA E INNOVACIÓN TELECOMUNICACIONES Y EQUIPO Diciembre 2022/Enero 2023 Petróleo&Energía
Más Información:
www.alestra.mx/soluciones/alestra-movil
Jacobo Bautista Cortesía F. Izquierdo

REDUCIR LAS EMISIONES Y EL IMPACTO AMBIENTAL CON SOLUCIONES PRÁCTICAS Y COMPROBADAS CUANTIFICABLEMENTE SIN COMPROMETER EL DESEMPEÑO, EL ENFOQUE DE SLB
La industria energética, las partes interesadas del sector del petróleo y el gas, los inversores y las comunidades globales y locales exigen ver reducciones más tangibles e inmediatas de la huella de carbono.
Elegir soluciones que reduzcan su huella de manera demostrable pero que a la vez impulsen un alto desempeño es un proceso desalentador. Los tomadores de decisiones deben diferenciar lo que es verdaderamente significativo de lo que se considera como “greenwashing”.
Ya sea que recién esté comenzando o que ya esté descarbonizando, SLB tiene el conocimiento para ayudarlo a alcanzar su objetivo.
Tecnologías de reducción de impacto probadas cuantificablemente SLB ha desarrollado un portafolio de tecnologías que pueden reducir considerablemente el impacto ambiental de las operaciones de petróleo y gas.
Usando una metodología científica desarrollada por nuestros ingenieros, los impactos de estas tecnologías han demostrado reducir la huella carbónica. Su método clasifica los atributos ambientales de estas tecnologías de transición y las asocia con los universalmente reconocidos Objetivos de Desarrollo Sostenible (ODS) de las Naciones Unidas.
• Su metodología de cuantificación científica demuestra el impacto de nuestras tecnologías.

• La metodología SLB define atributos ambientales que se asocian con los ODS de la ONU.
• Cuentan con tecnologías calificadas están respaldadas por cálculos para tomar mejores decisiones.
62 TECNOLOGÍA E INNOVACIÓN SLB Diciembre 2022/Enero2023 Petróleo&Energía
Redacción Cortesía Moisés Cervantes
SLB
Es una empresa global de tecnología, impulsando la innovación energética por un planeta equilibrado. En SLB crean tecnología que desbloquea el acceso a la energía en beneficio de todos.

Mostrar un impacto tangible
Reducir la huella ambiental es un esfuerzo complejo que hemos trazado meticulosamente para descarbonizar nuestras propias operaciones. Nuestras capaces tecnologías pueden hacerlo más fácil.
Al aprovechar impactos medibles, esta transparencia añadida fortalece sus esfuerzos de sostenibilidad frente al mandato de reducción de emisiones, el cual cada vez tiene mayor importancia.
• Cumplir con las metas de cero emisiones.
• Priorizar y medir las emisiones de alcance 1, 2 y 3.
• Defiende sus objetivos climáticos. Mostrar un progreso significativo para un planeta más equilibrado.
• Fortalecer la credibilidad con los stakeholders.
• Demuestre su impacto con seguridad frente a su comunidad, empleados e inversores.
• Gana una posición competitiva. Reduzca la exposición a los costes relacionados con las emisiones y aumente el valor de sus productos.
Reduzca su huella en ocho dimensiones
SLB se asocia con clientes que buscan formas de descarbonizar las operaciones, reducir el impacto ambiental físico, reducir los desechos y utilizar mejores soluciones de agua.
Sus capacidades en expansión se centran en las reducciones que contribuyen a revertir el cambio climático y, en consecuencia, se alinean con los impulsores clave de la industria energética.
• Reducir las emisiones de gases de efecto invernadero de las operaciones.
• Electrificar la infraestructura y permitir el acceso a fuentes de energía renovables.
• Reducir los materiales peligrosos y usar productos químicos más limpios.
• Minimizar los residuos.
¿Quieres sumergirte más profundo en este tema y leer las opiniones expertas de nuestros empleados? Visita www.slb.com.
63 petroleoenergia.com Diciembre 2022/Enero2023


LAS 100 EMPRESAS MÁS IMPORTANTES DEL SECTOR ENERGÉTICO EN MÉXICO 2022

Esta es la décima lista de las empresas más importantes del sector energético, tanto privadas como públicas. No se trata solamente de empresas de generación de energía, ya sea por medios tradicionales o renovables (hay un creciente número de empresas de generación de energía vía solar y eólica), recorremos toda la cadena de valor, desde empresas que prestan servicios a las gigantescas Pemex y CFE por ejemplo, incluimos a ests mismas, vitales para la sociedad mexicana y otras tantas dedicadas a la tecnología que hace que nuestra red eléctrica siga funcionando o de nuevos métodos de distribución de la misma.
Al igual que con los 100 líderes, el buscar año con año a las que serán parte de esta lista nos hacen apreciar el inagotable panorama de esfuerzos que hay en nuestro país.

PORTADA
66 Diciembre 2022/Enero2023 P&E Petróleo&Energía
GAS / PRIVADO
ACCLAIM ENERGY
LÍDER tecnológico global pionero en redes eléctricas, equipos de electrificación, automatización industrial y robótica y cinemática dirigidas a clientes del servicio público, industrias, transportes e infraestructuras. Tienen más de 130 años dedicados a la innovación, y el futuro de la digitalización industrial al hacer llegar la electricidad desde cualquier planta de generación de energía a cualquier toma de corriente, y al automatizar las industrias desde la gestión de los recursos naturales hasta la entrega del producto final.
new.abb.com/mx
ABB Industrial Automation @ABBMexico ABBenMexico ABB

CONSULTORA independiente que opera en México, Canadá y Estados Unidos, donde impulsa a los negpcios a minimizar sus costos totales de energía y a generar valor a través de enfoques probados e integrados de gestión energética. Fundada en 2003 y gestiona un portafolio de clientes con un gasto total anual de electricidad y gas natural de más de $2.5 miles de millones de dólares, más de 30 mil medidores y más de 500 clientes comerciales e industriales.
acclaimenergy.com.mx Acclaim Energy México @AcclaimEnergyMx Acclaim Energy México


ALFA
HOLDING diversificado de negocios: Alpek, grand productor a nivel mundial de poliéster (PET, PTA, fibras y rPET). Sigma, compañía multinacional líder en la industria de alimentos. Nemak, proveedor líder de soluciones de aligeramiento para la industria automotriz. Axtel, dedicada a tecnologías de información y comunicación (TIC) y Newpek, que realiza operaciones en la industria de hidrocarburos en EE.UU. y México.
ALTERPRAXIS
DESPACHO de consultoría estratégica enfocada en proponer una mezcla de pensamiento fresco, creativo y orientada en resultados. A través de metodologías propias, promueve la competitividad de sus clientes en mercados altamente regulados, apoyándolos en la consecución de sus objetivos de negocio. Alterpraxis ha acompañado- exitosamente a empresas del sector energético, a través del diseño e implementación de programas y estrategias de comunicación, sostenibilidad y asuntos públicos que promueven el posicionamiento de marca, el desarrollo participativo y la sostenibilidad.
ATIO GROUP
EMPRESA dedicada a la provisión de tecnología para la automatización y control del suministro de combustibles, incluyendo para vehículos y dispositivos que lo consumen. El grupo opera en toda América Latina desde sus corporativos en la Ciudad de México, tienen oficinas regionales de Miami, Buenos Aires y una red de 20 distribuidores autorizados en toda la región.
alfa.com.mx ALFA Corporativo @ALFA_MX ALFA_MX
alterpraxis.com alterpraxis

@Alterpraxis Alterpraxis
atiogroup.com.mx ATIO Group @ATIOGroup ATIO Group


BAKER & MCKENZIE
BAKER McKenzie tiene presencia en México desde hace medio siglo, con oficinas en la Ciudad de México, Guadalajara, Juárez, Monterrey y Tijuana. Es la firma de servicios jurídicos más recomendada a nivel mundial en todas sus áreas de práctica, con oficinas que participan de manera continua en asuntos importantes de fusiones y adquisiciones y transacciones financieras sofisticadas, que involucran a varias jurisdicciones. La red internacional se compone de 77 oficinas en 47 países.
EMPRESA de tecnología energética con una cartera diversa de equipos y capacidades de servicio que abarcan toda la cadena de valor industrial y energética. Sus cuatro empresas de productos, o segmentos operativos, se organizan en función de la naturaleza de los mercados y clientes.
bakermckenzie.com Baker McKenzie México @bakermckenzie Baker McKenzie México

bakerhughes.com Baker Hughes @bakerhughesco

BERISTAIN ABOGADOS

FIRMA legal de especialistas en defensoría, integrada por especialistas que atienden grandes áreas como: litigio civil, mercantil, administrativo, regulatorio, fiscal, penal y amparo. Su área corporativa atiende las necesidades de empresas nacionales y extranjeras proporcionándoles una solución integral a sus problemas y previniendo eventuales responsabilidades.
COMPAÑÍA de energía dedicada principalmente al petróleo y al gas natural con sede en Londres, Reino Unido, con presencia en México desde hace más de 50 años. Desde esos tiempos su presencia se ha incrementado con las oportunidades que se ofrecen en este mercado dinámico y en crecimiento. BP México maneja el mercado de lubricantes sintéticos, y también del comercio de gas natural, gas natural licuado, líquidos de gas natural, petróleo crudo y petroquímicos.
beristain-abogados.com @somosberistain Somos Beristain
bp.com/es_mx BP
@BP_MEX BPMexico bp_mex

HIDROCARBUROS / PRIVADO
BRASKEM - IDESA
ASOCIACIÓN creada en 2010 entre Braskem (75% de la participación), la mayor productora de resinas termoplásticas y Grupo Idesa, uno de los principales grupos empresarios mexicanos. El proyecto representa un importante avance para la industria petroquímica de México pues agrega valor a toda la cadena productiva en el país
www.braskemidesa. com.mx braskemidesa @BraskemIdesa braskemidesa
petroleoenergia.com Diciembre 2022/Enero2023
67
EMPRESAS
INNOVACIÓN / TECNOLOGÍA / PRIVADO
HIDROCARBUROS / PRIVADO
ELÉCTRICA / PRIVADO
BAKER HUGHES
HIDROCARBUROS / PRIVADO
HIDROCARBUROS / PRIVADO
RENOVABLE/ALTERNATIVA / PRIVADO
BP
HIDROCARBUROS / PRIVADO
INNOVACIÓN/TECNOLOGÍA / PRIVADO
CARSO ENERGY
HIDROCARBUROS / PRIVADO
CHEVRON
CARSO Energy es la subsidiaria que participa en las actividades propias de la industria del petróleo, en la exploración, localización, producción, explotación, refinación, transporte, compra y venta de todo tipo de hidrocarburos y minerales, en la prestación de servicios de transportación de gas natural y en la exploración, producción y explotación de energía geotérmica.
EMPRESA petrolera estadounidense creada en 1911 en California, llegaron a México en agosto de 2017 con su división de combustible, inaugurando su primera estación de servicio en Hermosillo, Sonora. Hoy, hay más de 200 estaciones de servicio en el país, donde además comercializan sus lubricantes Techron.
chevron.com Chevron @Chevron Chevron Chevron

CIEFSA

LABORATORIO de control de calidad de combustibles que presta sus servicios en toda la República Mexicana, con el objetivo de apoyar con el cumplimiento de la NOM-005-ASEA-2016, NOM-004-ASEA-2017 y NOM-005-SCFI-2017 especificaciones de calidad de los petrolíferos. Ofrece servicios de calidad respaldados por la competencia técnica de su equipo de expertos, con una capacidad de análisis que supera las mil 800 estaciones por semestre, lo que les permite cubrir toda la República Mexicana con total apego normativo.
CIPRO
EMPRESAS
ELÉCTRICA / PÚBLICO
COMBUGAS
DESARROLLAN proyectos en el sector energético enfocados en estudios de gran visión, ingeniería básica de detalle, diseño y supervisión de centrales hidroeléctrica y balance de plantas. El sistema purgatorio es uno de los más importantes, donde se realizó el diseño eléctrico, hidráulico y mecánico de la planta de bombeo de 6.5 m3/s de capacidad, el cual incluyó la línea de transmisión de energía eléctrica con capacidad de 160 MW, para dar una respuesta a las necesidades de la zona metropolitana de Guadalajara.
COMBUGAS es una marca registrada para la distribución y venta de gas licuado de petróleo por parte de sus empresas de Grupo Simsa. Es una empresa con gran arraigo en la zona lagunera, líder en servicio contando con el respaldo de más de 30 años de experiencia.
ciefsa.com CIEFSA
Ciefsa SA de CV
cipro.mx
CIPRO

@CIPRO_MX
combugas.com.mx

@CombugasOficial combugas
COMISIÓN FEDERAL DE ELECTRICIDAD
EMPRESA productiva del estado mexicano encargada de controlar, generar, transmitir y comercializar energía eléctrica en todo el país. Abastece a casi 27 millones de clientes e incorpora anualmente más de un millón. Es la empresa más grande del sector eléctrico de Latinoamérica y es propietaria de la única central nucleoeléctrica existente en el país, la Central Nuclear de Laguna Verde, Veracruz.
cfe.mx Comisión Federal de Electricidad @CFEmx CFE Nacional cfe_mx

CONDUMEX
CON más de 60 años de experiencia, es la empresa mexicana de mayor participación en el mercado de cables y desde hace varios años tiene la capacidad instalada más grande del país. Participa en proyectos con alta especificación técnica, de la mano de un gran equipo de trabajo; son parte de Grupo Carso, uno de los consorcios industriales, comerciales y de servicio más grandes de América Latina
grupocondumex. com.mx Grupo Condumex @Condumex Cables Condumex

COX ENERGY AMÉRICA

FUNDADA en 2014, tiene presencia en Chile, México, Centroamérica & Caribe, Colombia, España y Portugal. La compañía desarrolla su actividad en Generación de energía solar fotovoltaica con proyectos propios, comercialización de electricidad cien por cien renovable y autoconsumo. La empresa refuerza de esta forma la cadena de valor con tecnología solar fotovoltaica.
coxenergy.com Cox Energy @Cox_Energy

demar.com.mx

DEMAR
EMPRESA mexicana constituida en 1990, dedicada al diseño, construcción, instalación, mantenimiento y servicios para la industria petrolera, en tierra y costa fuera. Inicialmente sus trabajos se enfocaron a la rehabilitación, instalación y puesta en operación de equipos ubicados en la parte continental del país. Posteriormente se extendió al área marina, y a otras instalaciones de Pemex Gas, Petroquímica y Pemex Refinación.
DIAVAZ
SOCIEDAD empresarial 100% mexicana que inició operaciones como una compañía de buceo profesional en 1973. A través de su evolución ha adquirido un amplio conocimiento del sector de la energía, y actualmente ofrece soluciones integrales con productos y servicios de alta especialización, haciendo uso de las tecnologías más avanzadas disponibles en el mercado. Hoy, orienta su misión hacia la creación de valor ofreciendo servicios con estricto apego a la ética empresarial, altos estándares de calidad y un riguroso sentido de seguridad laboral y protección ambiental, consolidándose como una Empresa Socialmente Responsable.
Demar Instaladora y Constructora S.A. de C.V.
DemarOficial
www.diavaz.com
DiavazOficial @diavazoficial DiavazOficial

68 Diciembre 2022/Enero2023 P&E Petróleo&Energía
carso.com.mx
/ PRIVADO
HIDROCARBUROS
ELÉCTRICA / PRIVADO
HIDROCARBUROS / PRIVADO
RENOVABLE/ALTERNATIVA / PRIVADO
INNOVACIÓN/TECNOLOGÍA / PRIVADO
HIDROCARBUROS / PRIVADO
GAS / PRIVADO
HIDROCARBUROS / PRIVADO
E-SERVICES
 HIDROCARBUROS / PRIVADO
HIDROCARBUROS / PRIVADO
ECLIPSE SOLUTIONS

CUENTAN con un equipo de trabajo multidisciplinario, especialista en el cumplimiento normativo con los distintos órganos reguladores del sector, atienden todo tipo de gestión, tanto de expendio, almacenamiento, distribución, transporte e importación con las autoridades que regulan a este rama, tanto local y federal.
SE estableció en 2012 con el apoyo de abogados, consultores y empresarios profesionales de transporte y energía, así como miembros de las comunidades militares y de inteligencia de Estados Unidos. Los servicios de la compañía han crecido para incluir evaluación y auditoría de riesgos, protección personal, investigaciones, respuesta a víctimas y mitigación de riesgos adaptados a los sectores internacionales de energía, manufactura y transporte.
EDF RENEWABLES

COMPAÑÍA productora de energía filial de EDF Energies Nouvelles y proveedora de servicios líder en el mercado con más de 30 años de experiencia en energía renovable. Ofrece también energía a escala de red, carga de EV y gestión de energía y optimización de activos: habilidades técnicas, operativas y comerciales para maximizar el rendimiento de los proyectos de generación.
eservicesmx.com
@EServices_mx Eservicesmx eservicesmx
eclipse-risk.com
EMINENT
CON su eje revitalizado en dos plataformas comerciales básicas (soluciones de automatización y soluciones comerciales y residenciales), enfretan los desafíos de un mercado cada vez más complejo e impredecible desde una posición de fortaleza. Esto les permite generar valor tanto a corto como a largo plazo. Cuenyan una una gran reputación como único socio de confianza en los sectores de procesos, industrial, comercial y residencial.
PRIMERA empresa mexicana en ofrecer servicios de detección y cuantificación de emisiones de metano a nivel Tier 3 del IPCC y Nivel 4 del OGMP 2.0. Gracias a la exitosa integración tecnológica de Optical Gas Imaging y procesamiento de datos, entrega videos y reportes de emisiones con su valor económico en menos de 48 horas después de su detección, tiempo que incluye aseguramiento de calidad por expertos en Canadá. Hoy en día, es la opción más eficiente para la elaboración de PPCIEM con medición directa.
edf-re.com/es/mx/ EDF Renewables North America
@EDF_Renewables EDF Renewables North America edf_renewables_na
emerson.com/es-mx/ Emerson

@EMR_Auto_Latam Emerson Automation Latam
www.eminent.energy Eminent CH4

@eminent_CH4
EMPRESA que contribuye al desarrollo sostenible ya que en su operación, las fuentes renovables son una importante herramienta para promover la competitividad del sistema y asegurar el suministro de energía. La generación de energía a través del agua, el sol, el viento y la tierra otorgan una mayor independencia energética a las naciones y cuida el medio ambiente.
enelgreenpower.com

Enel Green Power @enelgreenpower Enel Green Power enelgreenpower
ENERFLEX
EMPRESA de origen canadiense que ofrece soluciones integradas llave en mano de compresión, procesamiento y energía eléctrica de gas natural en régimen de compra o alquiler, además de un completo servicio posventa, con ubicaciones en toda América Latina, desde México hasta Argentina. El equipo de América Latina tiene su sede en Houston, Texas.
www.enerflex.com enerflex-ltd@enerflexltd EnerflexLtd

ÉNESTAS
EEMPRESA especializada en crear acceso competitivo a materias primas y combustibles a través de la infraestructura y logística necesarias para llevarlas de manera segura, ecológica y eficiente a todo México.
EMPRESA que atiende la demanda energética de miles de hogares, comercios e industrias, lo que hace posible el desarrollo de actividades esenciales, tanto para la vida cotidiana de las personas como para la dinámica productiva. En su actual plan, busca destinar inversiones por un monto de más de 2mil millones de dólares en diversos proyectos de expansión del negocio de gas natural y proyectos renovables, en medio de los desafíos globales más importantes, como la lucha contra el calentamiento global, y el acceso a la energía para todos o la movilidad sustentable.
ENTE Nazionale Idrocarburi es una empresa energética italiana, creada en 1953 como empresa pública, propiedad del Estado italiano y convertida en Sociedad Anónima en 1992. Sus actividades están ligadas al sector petrolero y de gas natural, petroquímica, producción de energía eléctrica e ingeniería de construcción. Es una de las compañías que se mantiene a la vanguardia mundial en servicios de ingeniería offshore y onshore para la industria petrolera.
www.enestas.com ÉNESTAS Enestas enestas.naturalgas

engie.com

ENGIE
@ENGIEgroup ENGIE México
eni.com Eni @eni Eni
petroleoenergia.com Diciembre 2022/Enero2023

69
EMPRESAS
HIDROCARBUROS / PRIVADO
ENEL GREEN POWER
RENOVABLE/ALTERNATIVA / PRIVADO
HIDROCARBUROS / PRIVADO
RENOVABLE/ALTERNATIVA / PRIVADO
HIDROCARBUROS / PRIVADO
EMERSON
INNOVACIÓN/TECNOLOGÍA / PRIVADO
ENGIE
RENOVABLE/ALTERNATIVA / PRIVADO
INNOVACIÓN/TECNOLOGÍA / PRIVADO
ENI INTERNATIONAL
HIDROCARBUROS / PRIVADO
ESEASA
INNOVACIÓN/TECNOLOGÍA / PRIVADO
EVERGO
EMPRESA 100% mexicana fundada en 2014 enfocada a proporcionar servicios de construcción, mantenimiento y reparación para la rama offshore dentro del sector energético. Cuenta con dos patios al margen del Río Pánuco: uno en Tamaulipas y el segundo en Veracruz, ambos con infraestructura de primera clase.
PLATAFORMA de estaciones de carga para vehículos eléctricos que llegó a México a través de la adquisición mayoritaria de E-Drive, empresa líder en México en soluciones de infraestructura para la carga de vehículos eléctricos. Con una inversión de USD$ 200 millones prevista para los próximos cinco años, su objetivo es la instalación de más de 15,000 nuevas estaciones de carga en entornos residenciales, comerciales y públicos durante los próximos años.
EXXONMOBIL
LA marca Mobil como empresa nació en 1931; en 1999, cuando Exxon y Mobil se unieron para formar Exxon Mobil Corporation. Sus lubricantes Mobil han estado en México por más de 70 años, y desde 2017 contamos con estaciones de servicio de esta empresa, cuando el mercado del petróleo y la gasolina se abrieron al sector privado.
eseasaconstrucciones.com eseasa construcciones
ESEASA Construcciones

evergo.com evergo-emobility @evergo_emob evergo_mx

mobil.com.mx
ExxonMobil @exxonmobil ExxonMobil México ExxonMobil

FIELDWOOD ENERGY

EMPRESAS
GENERAC OTTOMOTORES

OOPERADORA del Área Contractual 4 en el territorio mexicano del Golfo de México y su área de operaciones de 58km2 está ubicada en aguas poco profundas frente a la costa de Campeche. Desde febrero pasado , el 100% de las acciones de la empresa mexicana Fieldwood Energy E&P México, están bajo el control de Lukoil International Upstream.
EMPRESA de Generac Power Systems Inc, cuya mística empresarial está basada en la importancia de brindar a sus clientes soluciones integrales para el desarrollo total de sus proyectos. Ofrece a través de una amplia gama de equipos provistos con la tecnología más avanzada, diversas soluciones destinadas a la generación de energía eléctrica; y combinan lo mejor de la tecnología e ingeniería para la entrega de resultados óptimos a sus clientes.
fieldwoodenergy.com Fieldwood Energy LLC
generaclatam.com Generac Power Systems @Generac Generac Latam
/ PRIVADO
gensa.com.mx

GENSA
GASODUCTOS del Norte está, desde 1989, dedicado a la fabricación de conexiones, elevadores, transiciones de acero-polietileno y módulos para la instalación de medidores; así como consultoría, ingeniería, diseño, construcción, mantenimiento de sistemas de medición y regulación.
GRANNEMAN LOBEIRAGLOBE
CREADA para satisfacer la demanda y necesidad de las empresas en México de contar con especialistas en la seguridad técnica en los sectores industrial (gas, petróleo, eléctrico, energías renovables) y marítimo.
globe.mx Grannemann Lobeira S. de R.L. de C.V. Grannemann Lobeira - Globe

GRUPO ALTAVISTA

NACIÓ como una empresa especializada en la atención y desarrollo de sistemas tecnológicos diseñados a la medida de las necesidades de pequeñas y medianas empresas. Con más de 25 años de existencia, ha brindado soluciones y servicios integrales de la más alta calidad y valor agregado a sectores estratégicos para el desarrollo económico del país, lo que le da una ubicación de solidez y liderazgo en los diversos sectores en los que participa.
GRUPO HOSTO
EMPRESA con 30 años de experiencia en el diseño, ingeniería, construcción, mantenimiento, desarrollo industrial y de infraestructura, al servicio del gobierno a nivel federal, estatal y municipal, así como a la industria de iniciativa privada. Está integrada por un cuerpo de técnicos especializados en diversas ramas de ingeniería, lo que le permite desarrollar cualquier proyecto solicitado por sus clientes los cuales se administran mediante la gerencia de proyectos, interviniendo directamente en la ejecución e integración de los trabajos, tomando en cuenta todas las variables que afectan a mediano y corto plazo en el desarrollo del proyecto.
GRUPO MÉXICO
ES una empresa líder en la producción de cobre, transporte ferroviario e infraestructura con 80 años de historia. Al ser la cuarta empresa más importante del país, sus operaciones impactan en desarrollo de varios sectores de la economía. Grupo Méxicolleva a cabo operaciones de infraestructura, transportes y minería en países como Perú, Estados Unidos, Argentina, Chile, Ecuador y España. Tiene una capitalización de mercado de más de 17 mil millones de dólares, con una planta laboral de más de 30 mil trabajadores.
grupoaltavista.com GRUPO ALTAVISTA @GrupoAltavista_ GrupoAltavistaMx
grupohosto.com.mx

@grupoHOSTO Grupo Hosto
gmexico.com Grupo México @Gmexico_oficial Grupo México gmexico_oficial

70 Diciembre 2022/Enero2023 P&E Petróleo&Energía
HIDROCARBUROS / PRIVADO
HIDROCARBUROS
HIDROCARBUROS / PRIVADO
HIDROCARBUROS / PRIVADO
INNOVACIÓN/TECNOLOGÍA / PRIVADO
HIDROCARBUROS / PRIVADO
HIDROCARBUROS / PRIVADO
ELÉCTRICA / PRIVADO
HIDROCARBUROS / PRIVADO
GRUPO ROALES
 HIDROCARBUROS / PRIVADO
HIDROCARBUROS / PRIVADO
HALLIBURTON

ORGANIZACIÓN líder a nivel regional en el suministro de servicios de asistencia técnica especializada y administrativa para la supervisión, ingeniería, entrenamiento, capacitación en seguridad industrial, protección ambiental, confiabilidad, pruebas no destructivas e integridad mecánica y comercialización de equipos e insumos, de la industria petrolera y energética; ayudando a incrementar la productividad, crecimiento sostenido y fortaleciendo la satisfacción de sus clientes.
ES uno de los principales proveedores de servicios de campos petroleros del mundo. Fundada hace 100 años, es actualmente una compañía global con más de 60 mil empleados que brindan servicios y productos a clientes en aproximadamente 80 países. Su especialización es el estudio de los datos para ubicar petróleo y el gas natural, así como las soluciones para determinar su extracción.
www.gruporoales. com/home Grupo Roales @GrupoRoales gruporoales
halliburton.com Halliburton @Halliburton Halliburton
heliservicio.com
HELISERVICIO CAMPECHE
EMPRESA de transporte aéreo regional enfocada en el sector de hidrocarburos, cuya necesidad de transportar de forma segura, eficiente y a veces de emergencia, personal y carga a puntos remotos. Cuenta con una flota de 24 helicópteros, y en los últimos cinco años ha realizado más de 150 mil horas de vuelo, transportando a a más de 2.5 millones de pasajeros.
HITACHI ENERGY
LÍDER global en tecnología energética sostenible. Atienden clientes en los sectores de servicios públicos, industria e infraestructura, con soluciones y servicios innovadores a lo largo de toda la cadena de valor. Se han distinguido por ser pioneros en tecnología y facilitar la transformación digital necesaria para acelerar la transición energética hacia un futuro neutro en carbono. Hitachi Energy tiene presencia en más de 140 países. Con sede en Suiza, emplea 38.000 personas en 90 países y genera un volumen de negocio de aproximadamente 10.000 millones de dólares.
HOKCHI
HIDROCARBUROS / PRIVADO
HOTHED
/ PRIVADO
EMPRESA de exploración y extracción de petróleo y gas. Se enfocan a la energía con una visión internacional enfocada en la innovación tecnológica, la seguridad operativa y la preservación natural del medio ambiente. En consorcio con la empresa E&P Hidrocarburos y Servicios, operan el área marina Hokchi, ubicada en la Cuenca Salina del Istmo, en el Golfo de México, frente al litoral del Estado de Tabasco.
www.hitachienergy.com
Hitachi Energy @hitachienergy Hitachi Energy hitachienergy

hokchienergy.com hokchi-energy

hothedmexico.com.mx

EMPRESA que cuenta con una extensa línea de herramientas en renta de perforación y pesca en el país, complementada con operadores calificados y servicios de ingeniería. Dedicada también a la fabricación de molinos y zapatas con la más alta calidad en la industria a nivel internacional, además de importar carburo de tugsteno, pastillas y otros materiales para dar óptimos resultados como lo demuestran los récords de molienda que han obtenido en México.
EMPRESA constituida en 2014 ne Ciudad del Carmen, Campeche. Para el desarrollo de ideas y soluciones de ingeniería innovadoras, y proveer servicios de Posicionamiento GNSS, Mapeos Submarinos e Inspección con Sonar Mesotech a clientes de la industria petrolera-marina, satisfaciendo siempre con óptima calidad sus requerimientos a través de la inversión en el desarrollo de nuestra gente y en la tecnología de vanguardia.
IBERDROLA
FILIAL de la empresa petrolera del mismo nombre que en los últimos años ha incrementado sus inversiones y operaciones en México, país al que considera como estratégico en su proceso de internacionalización que lleva a cabo desde 1990. Iberdrola México tiene una capacidad instalada en el país de más de 6 mil Megawatts en cinco parques eólicos y su producción de energía es tan grande que puede dotar de servicio eléctrico a por lo menos 20 millones de personas.
Hot Hed México
www.hpsoffshore.com hps-offshore-services


Grupo TMM
iberdrolageneracionmexico.com
Iberdrola México @iberdrolamex

Iberdrola México iberdrolamex
EMPRESA líder en construcción y operación de infraestructura en México, fundada en 1947 y con experiencia en trece países, siete sectores y un sólido portafolio de activos. El grupo está conformado por tres divisiones y especialidades en construcción civil e industrial, concesiones y aeropuertos.
ica.com.mx @ICAMexico ICA México

IMAGEN CORPORATIVA
IMAGEN Corporativa Gasolinera comenzó con la fabricación de señalamientos en calcomanía y PVC espumado. Incursionaron en la rotulación de lonas para anuncios los cuales consisten en lavar, pintar, cambiar lámparas, etc. Atienden de forma efectiva a la evolución y demandas de los anuncios de las estaciones de servicios.
imagencorporativagasolinera.com.mx
Imagen Corporativa Gasolinera imagencorporativagasolinera

71
EMPRESAS
petroleoenergia.com Diciembre 2022/Enero2023
/ PRIVADO
HIDROCARBUROS
HPS OFFSHORE SERVICES
HIDROCARBUROS
HIDROCARBUROS / PRIVADO
RENOVABLE/ALTERNATIVA / PRIVADO
INNOVACIÓN/TECNOLOGÍA / PRIVADO
ICA
HIDROCARBUROS / PRIVADO
HIDROCARBUROS / PRIVADO
HIDROCARBUROS / PRIVADO
JAGUAR EXPLORACIÓN Y PRODUCCIÓN
HIDROCARBUROS / PRIVADO
KAS OIL INTEGRATED SERVICES

COMPAÑÍA 100% mexicana de exploración y producción de hidrocarburos, creada para maximizar el potencial de las oportunidades derivadas de la actual política energética en el país. Es la empresa con el mayor número de contratos de licencia para la exploración y producción de hidrocarburos en campos petroleros ubicados en los estados de Tamaulipas, Veracruz y Tabasco.
EMPRESA especializada en el suministro de soluciones integrales asociadas a los procesos de la cadena de valor del petróleo. Especialistas en el desarro de proyectos técnicos operacionales y de desarrollo humano que incorporan soluciones y mejores prácticas internacionales al servicio de la industria petrolera mexicana.
jaguar-ep.com
Jaguar Exploración y Producción
www.kasoil.com.mx
KASOIL INTEGRATED SERVICES @kas_oil
FIRMA multidisciplinaria que desde hace más de medio siglo otorga soluciones al mercado social y financiero a través de asesorías, auditorias y medición y valoración de impuestos. Su trabajo se concentra en empresas nacionales y multinacionales, y cuenta con 190 socios y unos 3 mil profesionales estratégicamente distribuidos en 18 oficinas ubicadas en las ciudades más importantes de la República Mexicana.
LUKOIL INTERNATIONAL UPSTREAM HOLDING B.V.
EMPRESAS
MARATHON PETROLEUM CORPORATION (MPC)


ES la compañía petrolera más grande de Rusia y el mayor productor de aquél pais. A nivel mundial es la segunda mayor compañía junto con ExxonMobil en cuanto a reservas de crudo. Controla desde ferbrero de 2022 el 100% de las acciones de Fieldwood Energy E&P México.
home.kpmg.com/mx KPMG México @KPMGMEXICO KPMG MÉXICO kpmgtalento_mx
upstreamwest.lukoil. com/en/Activities/Mexico
LUKOIL International Upstream Holding B.V.

OPERA el sistema de refinación más grande de los Estados Unidos, con sede en Findley, Ohio, que expandió su presencia al mercado mexicano a través de sus marcas Arco y Tesoro posicionándose rápidamente como la opción de preferencia de los consumidores. Operan más de 300 estaciones suministradas por MPC en siete estados del país donde distribuyen su producto llamado Top Tier.
marathonpetroleum.com; arco.com/es-mx/mexico/ Marathon Petroleum Corporation

ARCO México; Marathon Petroleum Corporation
marinsa.com.mx
MARINSA
PROVEE barcos especializados para la industria offshore, donde se incluyen barcos loderos, de mantenimiento, floteles, barcos escolta y barcos de inspección, entre otros. Transporta materiales, personal, equipos y diesel offshore. Su base de operaciones se encuentra en el puerto de Ciudad del Carmen, donde ofrece atención en todos los puertos del Golfo de México. Cuenta con una gran experiencia en la atención de todo tipo de embarcaciones y plataformas.
MCDERMOTT INTERNATIONAL INC.

EMPRESA de ingeniería, adquisición, construcción e instalación de primer nivel, globalmente aguas arriba y aguas abajo. También es un proveedor establecido de tecnologías petroquímicas, de refinación, gasificación y procesamiento de gas líderes en la industria, y es una compañía que abarca toda la cadena de valor desde el concepto hasta la puesta en servicio.
Marinsa Specialized Vessels MX @MarinsaOnline Marinsa Specialized Vessels
mcdermott.com McDermott International Inc. McDermott International Inc.
mnjcapital.com.mx
MNJ CAPITAL
MNJ Capital es una Financiera Mexicana enfocada en el sector petrolero que administra los recursos de los inversionistas para financiar e invertir en infraestructura, suministros de bienes y servicios y compra de activos estratégicos. La empresa busca ser el punto de encuentro entre empresas con experiencia en la industria y conocimiento del sector energético con los mercados de capitales, que buscan un socio financiero que salvaguarde su inversión.
MOODY´S
MOODY’S Corporation, fundada en 1909, es la sociedad matriz de Moody’s Investors Service, agencia de calificación de riesgo que realiza la investigación financiera internacional y el análisis de las entidades comerciales y gubernamentales. La compañía también califica la solvencia de los prestatarios mediante una escala de calificaciones estandarizadas. Es considerada una de las tres agencias de calificación de crédito más grandes e importantes del mundo globalizado, junto a Standard & Poor’s y Fitch Ratings y, apenas en el 2013, acumulaban entre las tres; una cuota de mercado de 95%.

MNJ Capital Management

moodys.com
Moody’s Corporation @MoodysCorp
Moody’s Analytics
murguia.com


MURGUIA
EMPRESA de consultoría dedicada a proporcionar soluciones financieras en seguros y administración de riesgos, gracias a un servicio personalizado, eficaz e íntegro. Es una empresa considerada altamente productiva y comprometida con el beneficio de las personas y de la sociedad, al promover un modelo de negocio sustentable y siempre con un sentido ético que lo soporta; el cual impacta positivamente en los aspectos sociales, ecológicos y económicos de los grupos de interés.
Murguia Consultores
@MurguiaMx Murguia
72 Diciembre 2022/Enero2023 P&E Petróleo&Energía
HIDROCARBUROS / PRIVADO
HIDROCARBUROS / PRIVADO
HIDROCARBUROS / PRIVADO
KPMG
INNOVACIÓN/TECNOLOGÍA / PRIVADO
HIDROCARBUROS / PRIVADO
HIDROCARBUROS / PRIVADO
HIDROCARBUROS / PRIVADO
HIDROCARBUROS / PRIVADO
HIDROCARBUROS / PRIVADO

NATURGY
HIDROCARBUROS / PRIVADO
NAVIERA INTEGRAL
HIDROCARBUROS / PRIVADO
GRUPO multinacional líder en el sector energético, pionero en la distribución del gas natural y generación de electricidad, siendo garantía de suministro constante y con alta oferta de valor añadido. Presentes en 20 países. Más de 16 millones de clientes. Tienen una potencia instalada de 16,9 GW y un mix diversificado de generación de electricidad.
EMPRESA de servicios de transporte marítimo de pasajeros, abastecimientos de materiales y equipos a plataformas petroleras. Cuenta también con servicios de remolque de estructuras y barcazas, y la operación de buques tanque petroleros e incluye una flota de embarcaciones convencionales, con lanchas rápidas y abastecedores rápidos.
naturgy.com.mx Naturgy
@NaturgyMx Naturgy México naturgy
navinsa.com.mx NAVIERA INTEGRAL
Naviera Integral

www.nexoilcombustibles.com
NEXOIL
FUNDADOS en 2006 en el Estado de México, dedicados a la comercializacón y distribución de hidrocarburos derivados del petróleo en todo México (diesel y gasolina). Brindan servicios de suministro de combustible a transportes de carga y urbanos, minería, industria.
EMPRESAS
OLEUM SERVICIOS Y DICTAMINACIÓN TÉCNICA, S.A. DE C.V.
FORMA parte de un grupo de empresas y profesionales líderes en seguros y fianzas que se han especializado en la atención de empresas privadas, tanto mexicanas como multinacionales, que se desempeñan como contratistas, proveedores y operadores de la industria petrolera y energética de México. Durante más de 30 años, han asesorado y asegurado a armadores y operadores de toda clase de embarcaciones, empresas de geo-ciencias, perforación de pozos, manejo de gas, tendido de ductos, construcción costa afuera y mantenimiento de plataformas marinas, optimización de campos maduros, así como trabajos de buceo.
EEMPRESA autorizada como Tercero Autorizado por la Agencia Nacional de Seguridad Industrial y de Protección al Medio Ambiente del Sector Hidrocarburos, en materia de exploración y extracción de hidrocarburos en yacimientos convencionales y no convencionales. Poseen un sistema de calidad aplicable a los procesos de evaluación técnica y emisión de dictámenes técnicos, así como de auditorías.
Nexoil Combustibles y Lubricantes Nexoil nexoilcombustibles

nrgibroker.com

NRGI Broker / Energy Insurance Broker @NRGIBroker

oleumserviciosdictaminaciones.com
OLEUM SERVICIOS Y DICTAMINACIÓN TÉCNICA, S.A. DE C.V.

OXXO GAS
 HIDROCARBUROS / PÚBLICO
HIDROCARBUROS / PÚBLICO
PEMEX
 / PRIVADO
/ PRIVADO
PARTE de Grupo Femsa, cuyo core business es embotellar productos Coca-Cola y de su brazo comercial, Oxxo. En sus estaciones de servicio distribuye productos Pemex Aditec. Actualmente tienen 540 estaciones en 15 estados de la república.
oxxogas.com oxxogas @oxxogas oxxogas oxxogas
ES la empresa estatal por excelencia. Produce, transporta, refina y comercializa petróleo y sus derivados. Se rige por un régimen individual constitucional denominado Empresa Productiva del Estado para la explotación de los recursos energéticos en territorio mexicano, aunque también realiza diversas operaciones en el extranjero.
pemex.gob.mx Pemex @Pemex Pemex
PETROBAL

EMPRESA enfocada en la exploración y producción de hidrocarburos constituida en marzo de 2015. Forma parte de Grupo BAL, que es un conglomerado mexicano de empresas con actividades industriales en minería, seguros, sector financiero y operaciones comerciales; cuenta con una plataforma tecnológica integrada y una cartera sólida de posibles inversiones.
petrobal.com.mx PetroBal
@PetroBalOficial PetroBal
PETROGAS
BRINDAN servicios de construcción, equipamiento, mantenimiento y remodelación para estaciones de servicio y terminales de abastecimiento, así como una amplia gama de productos para la contención, distribución y transportación de hidrocarburos y diversos productos.
www.petrogas.com.mx Petrogas Corporation @PetrogasMX Petrogas Corporation petrogascorporation

petronas.com
PETRONAS

PC Carigali Mexico Operaciones S.A. de C.V. es una compañía mexicana de exploración y producción de petróleo y gas propiedad de la corporación multinacional de petróleo y gas Malasia Petroliam National Berhad (Petronas). Opera principalmente con proyectos y accionistas para operaciones en México relacionadas con el tema petrolero. En 2016 PC Carigali obtuvo contratos por 35 años para dos bloques de exploración en aguas profundas en el Golfo de México.
PETRONAS @Petronas Petronas México petronas
74 Diciembre 2022/Enero2023 P&E Petróleo&Energía
GAS / PRIVADO
HIDROCARBUROS / PRIVADO
HIDROCARBUROS
NRGI BROKER / ENERGY INSURANCE BROKER
HIDROCARBUROS / PRIVADO
HIDROCARBUROS / PRIVADO
HIDROCARBUROS / PRIVADO
HIDROCARBUROS / PRIVADO
PETROSEVEN
HIDROCARBUROS / PRIVADO
PIFUSA OIL & GAS
OPERAN más de 250 estaciones de servicio en siete estados del país; es uno de los brazos de las tiendas de conveniencia 7-Eleven México que desde 2017 ofrece aceites y lubricantes de marca propia.
COMPAÑÍA que se enfoca en la medición de diferentes productos y en la transferencia de custodia. Ofrecemos consultoría técnica y regulatoria. Realizan lo mismo ingeniería básica y de detalle, diseño de proyectos de llave en mano, fabricación y construcción de sistemas de medición, así como operación y mantenimiento. Son una empresa 100% nacional con más de 50 años de experiencia especializada en el sector energético y manufacturero.
www.petro-7.com.mx petro-7 @petro7gas Petro7Gas petroseven

pifusaoyg.com.mx pifusa @PifusaG pifusaoyg
PPG COMEX
EMPRESA de origen estadounidense, con fuerte presencia en México, dedicada a proveer pinturas, recubrimientos, productos de óptica, materiales especiales, vidrio y fibra de vidrio. Se consolidó comercialmente en nuestro país al realizar la compra de Comex por 2 mil 300 millones de dólares. Cuenta con 42 mil 600 empleados en todo el mundo, de los cuales 1.800 laboran en América Latina.
ppg.com PPG Industries @PPG PPG México

www.pqsimexico.com

ESPECIALIZADOS en Obra Civil, en complejos del sector industrial y energético así como en servicios de proyectos y obra en proyectos militares, balística, maquinaria industrial, equipos de proceso, ingeniería civil, arquitectura e instalaciones en general.
PROMOTORA ENERGÉTICA E3
HIDROCARBUROS / PRIVADO
PROTEXA

COMPAÑÍA mexicana desarrolladora de proyectos integrales de gas natural que más ha crecido en downstream en los últimos años. Alcanzando una cobertura casi total del territorio nacional. Actualmente son líderes en usos alternos del gas natural en México y cuentan con una de las gamas de productos y servicios más completa en GNV, GNC, GNL Y BioGas.

HOLDING con 70 años de experiencia, enfocada en el sector de hidrocarburos. Tiene sedes en Campeche, Tabasco, Veracruz, Nuevo León, San Luis Potosí y Ciudad de México, así como puntos de distribución en todo el país. Sus cuatro divisiones de negocio son: energía y petróleo; industrias, desarrollo de negocios, líder en construcción civil y desarrollo inmobiliario.
energeticae3.com Promotora Energética E3 @energeticae3 Promotora Energetica E3
protexa.com.mx Grupo Protexa @protexa Protexa
QUÍMICA APOLLO
TIENE su origen en Apollo Technologies Inc., con más de 40 años de experiencia en la fabricación y comercialización de todo tipo de aditivos de combustión. Establecida en México en 1983, a partir de 1988 se constituyó como una empresa con capital 100% mexicano, que brinda soluciones integrales para las cadenas de valor del petróleo y gas, generación eléctrica, minería y siderurgia, además de otros procesos industriales.

quimica-apollo. com.mx
Quimica Apollo QUIMICA APOLLO S.A DE C.V.
REPSOL
INICIÓ en el mercado de lubricantes hace 20 años, entre otras actividades y con presencia en más de 80 países, y ocho oficinas comerciales. En México la compañía suscribió una alianza con Bardahl para fabricar y comercializar productos aditivos. Se encuentra la apertura reciente de varias estaciones de servicio, para la venta de combustibles. En alianza con el grupo mexicano KUO, ha sido adjudicataria de seis bloques exploratorios en las últimas rondas mexicanas de licitación.
repsol.com.mx Repsol @repsolmexico Repsol México repsol

SAAVI ENERGÍA
PRODUCTOR privado de electricidad en el segmento energético que cuenta con centrales de ciclo combinado y estaciones de compresión de gas. Proporciona soluciones personalizadas a clientes en los sectores comercial e industrial. En 2015 creo su primer proyecto de energía renovable a través de una inversión con IEnova, en el parque eólico Energía Sierra Juárez, en Tecate, Baja California, que fue la primera instalación de energía renovable transfronteriza entre México y Estados Unidos.

CREADORES de tendencias durante más de 100 años, impulsan desarrollos e Introducen innovaciones en el mercado. Han tenido un impacto considerable en la evolución de las válvulas de componentes analógicos. Ofrece productos y sistemas para controlar todo tipo de industrias, especializándose en ingeniería de válvulas de control así como válvulas de control inteligentes. Actualmente se concentran completamente en las oportunidades que nos brinda la Industria 4.0.
saavienergia.com Saavi Energía Saavi Energía

www.samson.com.mx

Samson México @samsoncontrol
Samson Control México samsoncontrolmexico
petroleoenergia.com Diciembre 2022/Enero2023
75
EMPRESAS
HIDROCARBUROS / PRIVADO
HIDROCARBUROS / PRIVADO
HIDROCARBUROS / PRIVADO
HIDROCARBUROS / PRIVADO
PQSI
HIDROCARBUROS / PRIVADO
ELÉCTRICA / PRIVADO
GAS
/ PRIVADO
SAMSON
INNOVACIÓN/TECNOLOGÍA / PRIVADO
SEMPRA INFRAESTRUCTURA
HIDROCARBUROS / PRIVADO
SLB
INNOVACIÓN/TECNOLOGÍA / PRIVADO
SCHNEIDER ELECTRIC

CON un enfoque continuo en la sustentabilidad, innovación, seguridad de clase mundial, impulso a las personas y responsabilidad social, sus más de 2,000 colaboradores desarrollan, construyen y operan proyectos de energías limpias, infraestructura energética, GNL y cero emisiones netas.
EMPRESA de tecnología global que impulsa la innovación energética para un planeta equilibrado. Con presencia global en más de 100 países y empleados que representan casi el doble de nacionalidades. Con gran innovación en petróleo y gas, entregan soluciones digitales, y ayudan a descarbonizar industrias y desarrollar y escalar nuevos sistemas de energía que aceleren la transición energética.
semprainfrastructure. com

Sempra Infraestructura @SempraInfra_MX
slb.com Schlumberger schlumberger_oficial

PROPORCIONA soluciones digitales de energía y automatización para obtener mayor eficiencia y sostenibilidad, combinando nuevas tecnologías, automatización en tiempo real, software y servicios con soluciones integradas para hogares, edificios, centros de datos, infraestructuras e industrias.
SERVICIOS PETROLEROS OLIMPIA

EMPRESAS
INNOVACIÓN/TECNOLOGÍA / PRIVADO
SIEMENS ENERGY
HIDROCARBUROS / PRIVADO
OLIMPIA es una empresa de servicios petroleros que ofrece las mejores opciones de perforación, terminación y reparación de pozos petroleros terrestres y geotérmicos. También está dedicada a los estudios de subsuelo, superficie e infraestructura para diseñar y llevar a cabo trabajos eficientes de servicios a pozos, que permiten incrementar la productividad y generar un retorno eficaz de la inversión.
schneider-electric.com.mx Schneider Electric @SchneiderMX SchneiderElectricMX schneiderelectric
spolimpia.mx/home Servicios Petroleros Olimpia

GRUPO internacional de empresas del sector energético y petroquímico con casi 100 mil empleados a nivel internacional en más de 70 países. Al ser una de las líderes en su ramo utiliza tecnologías avanzadas y sigue un enfoque innovador para construir un futuro energético sostenible, porque confía en que el petróleo y el gas seguirán siendo un componente esencial de la combinación global de fuentes de energía. También opera en la extracción y suministro de recursos energéticos de manera rentable, con respeto al medio ambiente y a la ecología.
EMPRESA global que se centra en las áreas de electrificación, automatización y digitalización, por lo que está considerada una de las mayores productoras mundiales de tecnologías de ahorro de recursos y eficiencia energética. Siemens se estableció en el país el 1 de agosto de 1894, bajo el nombre de S&H Despacho Técnico México y desde entonces ha sido un factor clave para el desarrollo del país, con actividades comerciales que abarcaron desde energía y transporte, hasta sistemas industriales y dispositivos médicos eléctricos.
EL objetivo de esta empresa es el de entregar y proveer los servicios, herramientas y productos adecuados para cubrir las necesidades de sus clientes. Iniciaron sus actividades en el año 2009 en la ciudad de Villahermosa, Tabasco, México con el compromiso de prestar servicios en el ramo de la industria petrolera como lo son la construcción, el arrendamiento de maquinaría y equipo para la industria en general, y la capacitación de personal administrativo y operativo.
shell.com Shell @Shell Shell shell

siemens-energy.com/ mx/es.html

Siemens Energy @Siemens_Energy Siemens Energy siemens

grupospetro.com
TALANZA ENERGY
CON su metodología bulletproof-compliance se ha convertido en líder en consultoría especializada para clientes diversos, incluyendo super-majors y gobiernos extranjeros que buscan soluciones creativas, efectivas e integrales a sus desafíos regulatorios. Uno de sus proyectos insignia es REGTECH, software que controla las obligaciones legales y regulatorias de proyectos energéticos. Actualmente tiene la autorización de la ASEA como Tercero para dictaminar en materia de la regulación en metano.
www.talanza.energy Talanza Energy @TalanzaEnergy

TECHNIP FMC
TC Energía fue la primera compañía privada en construir y operar gasoductos en México. Actualmente con una inversión superior a los 5 mil millones de dólares y a través de más de 1.618 kilómetros de gasoductos, abastece gas natural a regiones consideradas estratégicas en México. Sumado a lo anterior, está en desarrollo constante tratando de expandir sus negocios en México y contribuir así al desarrollo de la infraestructura energética del país.
TECHNIPFMC es una empresa líder mundial en tecnologías submarinas, en tierra y costa fuera, que opera bajo sistemas de producción patentados, experiencia integrada y soluciones que transforman la economía de sus clientes. Ofrece además un servicio más eficiente en todos los ciclos de vida del o los proyectos que ofrece desde el concepto hasta la entrega final. También a través de tecnologías innovadoras y eficiencias mejoradas, su oferta abre nuevas posibilidades en el desarrollo de recursos de petróleo y gas.
tcenergia.com TC Energy @TCEnergia TC Energy
technipfmc.com TechnipFMC @TechnipFMC TechnipFMC technipfmc

76 Diciembre 2022/Enero2023 P&E Petróleo&Energía
GAS / PRIVADO
SPETRO
INNOVACIÓN/TECNOLOGÍA / PRIVADO
HIDROCARBUROS / PRIVADO
TC ENERGÍA
GAS / PRIVADO
SHELL
HIDROCARBUROS / PRIVADO
HIDROCARBUROS / PRIVADO

TENARIS TAMSA
HIDROCARBUROS / PRIVADO
TOTALENERGIES
HIDROCARBUROS / PRIVADO
ES uno de los centros industriales más grandes del mundo con sede en México, dedicado en la fabricación de tubos de acero para la industria energética. Se localiza en el estado de Veracruz, y desde hace más de seis décadas realiza además trabajos de exploración y producción de petróleo, minerales y gas, ya que cuenta con instalaciones de alta tecnología y modernidad, integradas para elaborar productos de alto valor agregado y apegadas a los estándares mundiales de calidad, seguridad y cuidado del medio ambiente.
GRUPO internacional clasificado en el cuarto lugar en el ranking de las compañías petroleras líderes en el mundo, al tener presencia en más de 130 países con una planta laboral de más de 90 mil empleados. En su división de lubricantes ofrece una amplia gama de productos gracias a sus segmentos, automotriz, industrial y marino, donde la compañía cumple con los más estrictos estándares internacionales y requisitos industriales con asociaciones internacionales.
TYPHOON OFFSHORE
PARTE de Grupo Salinas, sirve a la industria petrolera en el Golfo de México mediante un esquema de servicios integrales para las intervenciones a pozos petroleros y soporte en el mantenimiento de plataformas fijas costa afuera de Pemex. Realizan reparació, terminación y mantenimiento de pozos así como mantenimiento estructural a plataformas petroleras.
tenaristamsa.com Tenaris

@TenarisTamsa Tenaris tenaris
total.com.mx
TotalEnergies (MX) @TotalEnergiesMexico TotalEnergies totalenergies_mx

typhoon-offshore.com typhoon-offshore-mexico

valero.com
VALERO
EMPRESAS
A través de un conglomerado de subsidiarias, se constituye como un fabricante y comercializador internacional de combustibles y otros productos petroquímicos para el transporte. Tiene su sede en San Antonio, Texas, Estados Unidos y está dedicada también a la refinación de petróleo y producción de etanol, con una planta laboral de 10 mil empleados y una capacidad de producción combinada de aproximadamente 3.1 millones de barriles por día.
VEMO
HIDROCARBUROS / PRIVADO
WALWORTH
INNOVACIÓN/TECNOLOGÍA / PRIVADO
WETEAM
EMPRESA mexicana con un modelo integrado e innovador, comprometida a acelerar la movilidad limpia en México y América Latina. VEMO integra el talento con las capacidades tecnológicas y operativas claves para garantizar el éxito a largo plazo de proyectos de movilidad limpia.
Valero Energy Corporation
Valero

Energy
www.vemovilidad.com
VEMO
WINTERSHALL DEA MÉXICO
FUNDADA en 1842 por James Walworth; la compañía se ha dedicado al diseño y fabricación de una gran variedad de válvulas para el sector de control de fluidos del sector de los hidrocarburos. Cuenta con amplia experiencia en el suministro de válvulas para las industrias petroquímica, de petróleo y gas, petróleo, generación de energía, celulosa y papel, criogénica y geotérmica, entre otras actividades industriales.
ww.walworth.com WALWORTH

ZEECO THERME
EMPRESA global que ayuda a digitalizar y automatizar los procesos empresariales en el campo. Somos una realidad italiana, concebida por tres socios fundadores que se encuentra fuertemente orientada a los resultados, siguiendo paso a paso las actividades operativas de sus clientes adaptando sus productos a las necesidades de diseño. La pasión y las habilidades de Weteam, han creado soluciones innovadoras, modulares y patentadas mediante wayUp; principalmente en el sector energético en diversas empresas a nivel mundial.
WINTERSHALL Dea ha estado desarrollando hidrocarburos en México desde 2017, convirtiéndose eun un influyente jugador en el sector. Actualmente es el operador del campo petrolero terrestre Ogarrio y posee acciones en diez bloques de exploración costa afuera en el Golfo de México. La empresa opera tres de estos bloques de exploración.

weteam.it/es/ WETEAM @Weteam

wintershalldea.com/ en/where-we-are/mexico @wintershalldea Wintershall Dea
RECONOCIDA mundialmente como los expertos en soluciones de combustión y ambientales, e Industrias Therme S.A. DE C.V., conocida en México como el principal proveedor de equipos de combustión, ventas y servicio, han unido sus fuerzas para formar Zeeco-Therme S.A.P.I. DE C.V.. ZT provee ingeniería, fabricación, servicio al cliente, y el apoyo a todas las líneas de productos.

zeeco-therme.com.mx

ZEECO Inc
@Zeeco_Inc
Zeeco Therme
ZUMA ENERGÍA
PRODUCTOR independiente de energía renovable con un modelo integral de negocios, que cubre toda la cadena de valor en este sector; y que parte de la detección de grandes proyectos con potencial para desarrollarlos, estructurarlos, financiarlos, construirlos y operarlos. Trabaja con el respaldo financiero de grandes inversionistas globales (Actis y Mesoamérica) como ejemplo, y en este contexto, ha desarrollado un portafolio de más de 800 MW de proyectos eólicos y solares que se encuentran en operación y construcción en varios estados de la República Mexicana.
zumaenergia.com
Zuma Energía
@ZumaEnergia Zuma Energía

78 Diciembre 2022/Enero2023 P&E Petróleo&Energía
HIDROCARBUROS / PRIVADO
Walworth Valves
HIDROCARBUROS / PRIVADO
HIDROCARBUROS / PRIVADO
HIDROCARBUROS / PRIVADO
ELÉCTRICA / PRIVADO
RENOVABLE/ALTERNATIVA / PRIVADO

PERSPECTIVA DE 2023 PARA EL SECTOR PETRÓLEO Y GAS
Estamos ante un 2023 que será un año atípico en muchos sentidos y con grandes retos para el sector energético y especialmente para el segmento petrolero global. Si bien se pronostica un crecimiento del PIB mundial de 3.2%, y pareciera que el mundo está superando las implicaciones más severas de la pandemia, la guerra en Ucrania y los retos de la inflación, el mundo se presenta con una amalgama de tema complejos de entender y atajar.
Es importante considerar los riesgos de las alzas de precios y las consecuencias de nuevas medidas monetarias por parte de los principales bancos centrales. Además, la realidad es que la pandemia sigue siendo un riesgo difícil de mitigar que podría frenar el crecimiento dependiendo del alcance de las medidas para reducir los contagios. Y, una más, los cuellos de botella de las cadenas de suministro no se resolverán en el corto plazo.
Ante esto, en 2023 se pronostica crecimiento de la demanda de petróleo a la par de que es posible esperar una la caída de los inventarios mundiales del hidrocarburo a principios del año, lo cual precipite un alza de los precios del Brent por encima de los $90 dólares por barril a principios del segundo trimestre.
Anteriormente, en ese pasado remoto prepandemia, los precios del petróleo solían tener una oscilación estacional predecible: se esperaban alzas en la primavera a medida que los productores anticipaban la demanda alta durante verano. Una vez que la demanda alcanzaba su punto máximo, los precios solían caer en otoño e invierno.
De cara a 2023, los precios seguirán siendo extremadamente volátiles. Varios factores jugarán un rol importante: el embargo petrolero a Rusia, la caída en la producción de OPEP+, una menor disponibilidad de shale en Estados Unidos, la escala-
da de inflación, la caída en la demanda en China y una potencial recesión mundial serán factores que ejercerán más presión sobre los precios mundiales.
El sector petrolero global en 2023 estará influenciado por esos cambios económicos, sociales, de salud pública y geopolíticos por lo que se podrá observar desajustes oferta y demanda en muchas regiones.
La guerra en Ucrania

Rusia es el tercer mayor productor de combustibles líquidos y petróleo, por lo que cuando el país invadió Ucrania a fines de febrero de 2022, tuvo un impacto inmediato en los precios de los futuros del Brent. A medida que el conflicto continuó, los precios del crudo han tomado una trayectoria ascendente, alcanzando casi $130 dólares por barril a principios de marzo, y manteniéndose muy por encima de $100 por buena parte del verano.
Estados Unidos
La pandemia y los eventos naturales siguen afectando el mercado petrolero estadounidense. Primero se experimentó una caída en la producción tras el paso del huracán Ida, ya que la tormenta cerró al menos nueve refinerías.
La Agencia de Información Energética de EUA (EIA) estima que la producción promediará 12.01 millones de barriles diarios en 2022 y 12.95 millones en 2023.
80 MIGUEL TOVAR Diciembre 2022/Enero 2023 Petróleo&Energía
Miguel Tovar Luis E. González Piceno
MIGUEL TOVAR, SOCIO ALTERPRAXIS
COLUMNISTAS
Producción de la OPEP
Los aumentos del precio del petróleo también reflejan las limitaciones de suministro de la Organización de Países Exportadores de Petróleo (OPEP) y los países socios de la OPEP. En 2020, la OPEP redujo la producción de petróleo debido a la disminución de la demanda durante la pandemia. Posteriormente la producción de petróleo aumentó gradualmente, pero las interrupciones de la cadena de suministro a fines de 2021 afectaron el comercio mundial, por lo que se generaron desbalances sobre todo en Asia.

En su reunión de octubre de 2022, la OPEP declaró que ajustaría la producción de petróleo a la baja a partir de noviembre de 2022 en 2 millones de barriles por día (mb/d), lo cual implica un recorte de cerca de 2% de la producción mundial.
Gas natural
Los países de Asia en general dependen del carbón para la generación de electricidad, pero la escasez reciente ha presionado por una reconversión al gas natural. Las temperaturas más altas en partes de Asia y Europa han llevado a una alta demanda de gas natural.
Como resultado, los precios del gas natural se dispararon en 2021 y se mantuvieron altos en 2022, ya que Rusia bloqueó las entregas a Europa y se espera una tendencia al alza hasta 2023.

Reservas globales
A medida que continúa la reducción de la producción de petróleo a nivel mundial, los países se ven obligados a recurrir a sus reservas almacenadas. Esta estrategia contribuye al aumento de los precios, porque los inventarios están disminuyendo.
¿Dónde está el piso?
A pesar de la perspectiva alcista, vale la pena identificar dónde podría estar el piso para el mercado global. Una pista: el gobierno de Estados Unidos ha asegurado que comenzará a colocar sus reservas estratégicas de petróleo, en caso de que los precios se acerquen a los $70 dólares por barril. Esto pudiera percibirse como un piso, pero habrá que estar al tanto de la intervención de la OPEP y su influencia en el mercado.

@petroleoenergiaoficial petroleoenergia petroleoyenergia Petróleo Energia

Notas
81 petroleoenergia.com Diciembre 2022/Enero 2023
LAS 2O ASOCIACIONES
MÁS IMPORTANTES DEL SECTOR ENERGÉTICO EN MÉXICO 2020
Por cuarto año te presentamos el listado de las 20 asociaciones más importantes del sector energético en México, estas organizaciones han sido clave en la forma de hacer enlaces con los distintos actores de la industria y sus agremiados. Hoy más que nunca creemos en su importancia y participación.
SECTORES: Hidrocarburos Eléctrica Renovable/Alternativa Innovación/Tecnología
1 ALENER
Alianza por la Eficiencia Energética
Fundada en 2003 como Asociación de Empresas para el Ahorro de Energía en la Edificación y ha evolucionado para ser el referente en el conocimiento teórico y práctico respecto a soluciones orientadas a la eficiencia energética en la edificación, que participe e incida en el desarrollo de regulaciones en concordancia con tendencias internacionales.
alenermexico @AlenerMexico Alener - Alianza por la Eficiencia Eficiencia Energética ahorroenergia.org.mx

3 AIPM
Asociación de Ingenieros Petroleros de México Asociación que agrupa profesionales de la Ingeniería empleados por la industria petrolera mexicana. La asociacióncuenta con más de 3 mil 500 asociados agrupados en diez delegaciones que se ubican principalmente en zonas petroleras del país. Lleva por lema la frase “Fraternidad y Superación”.
AIPM-”Asociación de Ingenieros Petroleros de México, A.C.” @AIPM_AC aipmac.org.mx


5 AMEXHI
Asociación Mexicana de Empresas de Hidrocarburos Asociación civil sin fines de lucro que reúne a los principales inversionistas y operadores de petróleo y gas en México. Agrupa a 47 miembros para propiciar que la industria mexicana de los hidrocarburos se desarrolle con los más altos estándares internacionales en un entorno cada día más competitivo.
AMEXHIOficial @AMEXHI_Oficial amexhioficial amexhi.org

7 ASOLMEX
Asociación Mexicana de Energía Solar Creada en 2014, actualmente reúne a 110 empresas entre operadores, inversionistas, proveedores, fabricantes y desarrolladores de centrales solares fotovoltaicas a gran escala y de generación distribuida. Son un foro de análisis, propuesta y difusión de la energía solar que busca la mejora del marco legal y regulatorio en la materia así como el impulso de la industria solar en México.
asolm3x @asolmexac Asociación Mexicana de Energía Solar (ASOLMEX) asolmex.org

2 AMCHAM
American Chamber of Commerce Mexico AC

La AmCham ha promovido históricamente el libre comercio, transparencia y mejores prácticas dentro y fuera del sector empresarial, ayudando a sus socios a mejorar y hacer crecer sus negocios. Es una de las voces más propositivas en la relación México - Estados Unidos. Actualmente es presidida por Vladimiro de la Mora, CEO de GE México.
@AmChamMexico amchammexico amcham.org.mx
4 AMENEER
Asociación Mexicana de Empresas de Eficiencia Energética Fundada hace diez años, agrupa empresas, individuos, organizaciones e instituciones dedicadas a implementar modelos de eficiencia energética, desarrollando infraestructura sustentable que impulse la competitividad del mercado energético, tanto del lado de la oferta como de la demanda. Busca así fomentar en las entidades financieras el interés por el rubro.
ameneermx @AMENEER_MEX ameneer ameneer.org


6 AMDEE
Asociación Mexicana de Energía Eólica Desde 2005 ha promovido la generación y desarrollo de la energía eólica en el país. Representa a los desarrolladores de proyectos eólicos ante las autoridades, sectores económicos y la sociedad en general, ofreciendo oportunidades para la inversión nacional y extranjera, la creación de cadenas de valor para la manufactura y proveeduría de bienes y servicios.
AMDEEMexico @amdeemx Asociación Mexicana de Energía Eólica amdee.org
8 AMGN
Asociación Mexicana de Gas Natural Creada en 1988, actualmente reúne a más de 80 empresas (nacionales y extranjeras) de las cuales representa sus intereses. Además de promover y desarrollar el mercado, está activa en la creación de una mejor regulación del sector.
AMGNMx @AMGNMx amgnmx amgn.mx
82 ESPECIAL ASOCIACIONES Diciembre 2022/Enero 2023 P&E Petróleo&Energía
9 AMGNV
Asociación Mexicana de Gas Natural Vehicular
El objetivo de esta asociación, fundada en 2014 es participar en la estructuración, ajuste y modernización de políticas públicas, normas, reglamentos y buenas prácticas de seguridad, medio ambientales, comerciales e industriales que beneficien y apoyen el crecimiento del uso del gas natural para la movilidad.
AMGNV0 @amgnv amgnv amgnv.org

11 AMGP
Asociación Mexicana de Geólogos Petroleros Organización científico-técnica constituida por profesionales dedicados a la geología petrolera y profesiones afines, aplicadas a la exploración y producción petrolera y de otros recursos energéticos. Se encuentran agrupados en delegaciones regionales que dependen de una directiva nacional.

Asociación Mexicana de Geólogos Petroleros, Directiva Nacional amgp.org
13 AMPES
Asociación Mexicana de Proveedores de Estaciones de Servicio
Sus integrantes son expertos en la industria gasolinera nacional y extranjera de empresas que distribuyen aditivos y lubricantes, constructoras, servicios integrales, distribuidores de equipos e instaladores, fabricantes tanques, software, sistemas administradores, consultoría legal, inmobiliaria, entre otros.
AMPESACMX @AmpesMx Asociación Mexicana de Proveedores de Estaciones de Servicio ampes.mx



15 CIPM
Colegio de Ingenieros Petroleros de México Agrupa a profesionales de Ingeniería Petrolera que buscan contribuir y promover el progreso y fortalecimiento de esta profesión en todos sus campos. Con ello tratan de hacer un mejor aprovechamiento de los recursos energéticos del subsuelo del país, así como fomentar la investigación tecnológica.
CIPMex @CIPM_mx cipetrolerosmexico cipm.org.mx
17 CPEF
Consejo Nacionl de Profesionales de Energía Fotovoltáica
La CPEF es la asociación nacional más grande e influyente de la todavía muy joven industria fotovoltaica. Entre sus objetivos estan el profesionalizar las actividades la energía solar de México e impulsar su desarrollo.

CPEF.ORG @CpefORG cpef.org.mx
19 ONEXPO
ONEXPO NACIONAL
Son la unión de asociaciones de gasolineros más grande de México con representación en todos los estados. Busca ser enlace entre gobierno y empresa, emprendiendo diversas actividades que beneficie a los agremiados, fortaleciendo el compromiso social, al impulsar una cultura de transparencia, servicio y responsabilidad.
OnexpoNacional @OnexpoNacional Onexpo Nacional A. C. onexpo.com.mx

10 AMGE
Asociación Mexicana de Geofísicos
Fue creada eb 1958, por un grupo de profesionales de la industria petrolera, la primera de su tipo en América Latina. Su objetivo es ser el referente gremial más influyente en Geofísica y Ciencias de la Tierra en Latinoamérica, con presencia mundial. Tienen siere delegaciones en la República y una en el exterior (ubicada en Houston, Texas).
AMGEMEXICO Asociación Mexicana de Geofísicos de Exploración A.C. amge.mx
12 H2MÉXICO
Asociación Mexicana de Hidrógeno De reviente creación, esta asociación busca no solo socializar los temas relacionados al hidrógeno sino involucrar a todos los actores públicos y privados que incidan en el impulso y desarrollo de esta industria así como participar en el diagnóstico de la situación del hidrógeno en México, los retos y oportunidades, su potencial y posibles barreras de entrada.

h2mex.com

14 CANACINTRA

Cámara Nacional de la Industria de Transformación
La Cámara Nacional de la Industria de Transformación es el represente por excelencia del sector industrial de México y tiene como objetivo fomentar la competitividad y la productividad de las empresas. Por su cobertura, representatividad e infraestructura, es la cámara más importante de Latinoamérica.
CANACINTRAMexico @canacintramex canacintra.org.mx
16 COMENER
Consejo Mexicano de Energía Instancia privadaque busca generar consensos dentro del sector energético de México. Está integrada por los líderes de las principales industrias que lo componen. Comprometida con el impulso de la innovación, la infraestructura y el talento de los mexicanos, en el marco de amplios consensos públicos con el fin de garantizar una matriz energética.
comener.org
18 O&GA Oil & Gas Alliance

Agrupa a directivos del sector, enfocados a generar y desarrollar negocios en el sector energético con más de 2 mil miembros en la llamada Red Alliance. Tiene como objetivo a vincular y desarrollar proveedores del sector energía con operadores, tractores y contratistas.
Oilandgasalliance @oilgasalliance Oil and Gas Alliance oilandgasalliance.com
20 WEN
Women´s Energy Network

WEN es una organización a escala mundial, una red que busca apoyar profesional y personalmente a las mujeres profesionales del sector energético. El capítulo mexicanofue fundado en 2017 por cuatro jóvenes profesionales conscientes de la necesidad de crear una red con este propósito.
WENMEXICO @wen_mexico womensenergynetwork womensenergynetwork.org/Mexico/
petroleoenergia.com Diciembre 2022/Enero 2023
83
IMPULSO ENERGÉTICO POBLANO
El 27 de noviembre de 2019 el Congreso Estatal de estado de Puebla publicó el decreto por el cual se creaba la Agencia de Energía del Estado. Su obvia misión es promover el desarrollo energético pero con aristas que van más allá de lo sustentable pues sus acciones están enfocadas a tener un impacto positivo en la población.

El primer pilar en su modelo es el combate a la pobreza energética, tanto así que uno de los grandes anuncios en el 2o Foro Energético Poblano fue la inversión en el estado de la empresa canadiense Solfium, misma que comenzó dotando al sistema de educación pública de paneles solares para una escuela.
Este esfuerzo forma parte de Escuelas Solares, que lleva equipadas más de 30 instituciones de diferentes niveles educativos en 24 municipios, impactando la vida de 36 mil 376 alumnos.
Además, se instalaron paneles solares en el Sistema de Bombeo de agua potable de la localidad de San Lorenzo Joya de Rodríguez en el municipio de Tepeaca, reduciendo el costo de la factura eléctrica en 50% y beneficiando a más de 1800 personas y asimismo se inició la instalación de sistemas de bombeo y riego, los cuales reducirán la facturación eléctrica hasta en 50% de 50 productoras y productores agrícolas de diez localidades ubicadas en diez municipios.

En el pilar 2, de innovación, uno de las iniciativas más importantes también impacta a estudiantes (solo que mayores), al llevar a a cabo la prueba piloto MoveUp con un primer minibús interuniversitario 100% eléctrico en Puebla. MoveUP tuvo más de 16 mil abordajes y una reducción en 37% de las emisiones de dióxido de carbono (CO2) en comparación con el reparto modal.

El plan de descarbonización (pilar 3) que lleva a cabo la agencia no solamente trata de capacitaciones y talleres para hogares y PyMEs sino tam-
01 ERMILO BARRERA NOVELO, DIRECTOR GENERAL DE LA AGENCIA DE ENERGÍA DEL ESTADO DE PUEBLA
02 LAS PRIMERAS GRANDES BENEFICIADAS CON EL TRABAJO DE LA AGENCIA HAN SIDO MUCHAS ESCUELAS PÚBLICAS, AHORA ALIMENTADAS DE ENERGÍA SOLAR.
bién de un programa llamado Incentivos Verdes que busca que estas empresas, medianas y pequeñas, transiten a las energías renovables sin afectar su flujo de efectivo y al mismo tiempo incrustándolas en un modelo de ahorros energéticos.
El quinto pilar trata de la atracción de inversiones, para ello se ha creado el Catálogo de Proveedores del Sector Energético en Puebla, y se amplió el suministro competitivo de gas natural por más de 3 mil millones de pesos y se constituyó la asociación civil Clúster Energético de Puebla.
Al frente de este esfuerzo, Ermilo Barrera ha tenido éxito, al mando de un grupo entusiasta busca no solamente colocar a Puebla más alto en el
01
03
LA AGENCIA TIENE UN PLAN PARA INSTALAR MÁS DE 40 CARGADORES PARA AUTOS ELÉCTRICOS EN LA ENTIDAD Y ASÍ IMPULSAR ESTE TIPO DE MOVILIDAD.

84 TECNOLOGÍA E INNOVACIÓN AGENCIA DE ENERGÍA DEL ESTADO E PUEBLA Diciembre 2022 / Enero 2023 Petróleo&Energía
Redacción Cortesía Carlos Cuevas
ranking energético mexicano sino que todos estos esfuerzos tengan un impacto de 360 grados en la sociedad del estado, involucrando al sector privado pero buscando que todas las acciones tengan un beneficio real para todas las capas de la sociedad. 02
03

QUEMADOR DE BAJO NOX
GB SINGLE JET ZEECO
El pasado 10 de enero, Apollocom -empresa hermana de Química Apollo- y el Centro Nacional de Control del Gas Natural lanzaron el proyecto TELCO, el cual se basa en el Servicio Administrado de Transporte de Datos para las Tecnologías Operacionales.
Redacción Cortesía Carlos Cuevas
Definimos la innovación en Bajas Emisiones de NOx
Lo que se hace en Zeeco es crear nuevos y revolucionarios diseños de quemadores que han demostrado lograr emisiones bajas y ultra bajas. Continúan ampliando los límites de la innovación con diseños de quemadores como el Zeeco® GB de chorro simple. Este quemador en etapas, de flama redonda y bajo nivel de NOX destaca a todos los demás quemadores de proceso con las extraordinarias ventajas de su diseño compacto de boquilla sencilla y cono. El GB de chorro simple también abre las puertas a nuevas aplicaciones y actualizaciones nunca antes posibles.
El diseño para lograr bajas emisiones es un espacio más pequeño
El quemador de combustible por etapas GB de chorro sencillo utiliza un diseño no simétrico para impulsar la recirculación interna de gases de combustión y el aire por etapas para reducir las emisiones de NOx (20 a 49 ppmv para la mayoría de las aplicaciones).
El exclusivo diseño único de de la boquilla y el cono ofrecen un alto rango de capacidades, características de flama predecibles, mantenimiento mínimo y baja probabilidad de interacción con la flama.
• Flama Estable – El diseño de boquilla y cono proporcionan una alta estabilidad de flama. El patrón de perforación de la boquilla incluye puertos de quemador para crear la zona de combustión primaria (pobre) y un puerto de combustible en el centro para crear la zona de combustión secundaria (rica).

• Diseño Compacto – El diseño de boquilla y cono del GB
hace que el quemador sea más compacto e ideal para aplicaciones nuevas y mejoramientos debido a los requisitos de espacio limitado del quemador.
• Baja probabilidad de interacción con la flama – En comparación con un quemador de combustible por etapas convencional, el GB presenta una sola boquilla ubicada en la garganta del quemador. Esto significa que el gas que se dispara de un quemador a otro está más separado, lo que reduce la probabilidad de interacción de las flamas y una “nube de flamas” en el calentador, lo que puede generar emisiones elevadas.
• Bajo mantenimiento – El diseño de la boquilla y el cono son una de las configuraciones de quemadores más solicitadas por los usuarios y es la preferida por el personal de operación, ya que requiere un mantenimiento mínimo.
86 HIDROCARBUROS ZEECO THERME Diciembre 2022 / Enero 2023 Petróleo&Energía
• Control preciso del aire de Combustión – Controlar el aire de combustión de cada quemador es clave para un funcionamiento optimo. Zeeco utiliza un diseño de hoja de amortiguador doble con una manija de puerta de aire de 33 posiciones para control de aire sólido y preciso.

Características de Diseño del Quemador de Chorro Simple de Bajas Emisiones
• Diseño de Quemador de solo de gas, Flama Redonda
• Reduce el NOx a través de recirculación interna de gases de combustión, combustible por etapas y aire por etapas.
• Inducción de aire de combustión natural, forzada, inducida, tiro balanceado o escape de turbina.
• Quemado hacia arriba, lateral, y hacia abajo disponibles
• El diseño compacto hace que el quemador sea una excelente opción para reemlazo y optimización de quemadores.
• Forma de Flama Compacta
• Montado en Plenum o Caja de viento individual
• Bajo Costo a Largo Plazo
Desempeño del Chorro Simple (Simple
• Caída de presión de aire de combustión - tiro forzado: 0.5” a 10” (12.7 a 254 mm) columna de agua


Confianza en el Cumplimiento. Reputación Reconocida
Los nombres más reconocidos del mundo en las industrias de Refinación, Producción, GNL, Procesamiento de Gas, Generación de Energía, Biogás confían en Zeeco para mantener sus operaciones más limpias, seguras e inteligentes que nunca, Y no es de extrañar que Zeeco se ha ganado una excelente reputación por asumir proyectos más difíciles, hacer lo que decimos que haremos y trabajar con nuestros clientes para resolver los sistemas ambientales y de combustión adaptados exclusivamente a sus plantas.
Jet)
• Bajas Emisiones de NOx: utiliza aire por etapas, combustible por etapas y recirculación interna de gases de combustión.
• Rango de NOx pronosticado - Tiro natural: 40 mg/ Nm3 (20 ppmv) a 100 mg/Nm3 (49 ppmv)
• Rango de Liberación de Calor - Tiro Natural: 1 a 20 MM Btu/hr [0.293 a 5.860 MW]
• Rango de liberación de Calor - Tiro Forzado: 1 a 75 MM Btu/hr [0.293 a 21.98 MW]
• Turndown: 10:1 o mayor en la mayoría de los casos Espaciamiento de Boquillas de Chorro Simple GB • rango de exceso de aire de diseño: 8% para la mayoría de los casos.
• Caída de presión del aire de combustión - tiro natural: 0.2” a 1” (5 a 25 mm) columna de agua
87 petroleoenergia.com Diciembre 2022 / Enero 2023
VENTEO DE GAS: LA CATÁSTROFE SILENCIOSA
Hoy en día existe un creciente discurso que defiende y empuja las virtudes de la responsabilidad ecológica, la sustentabilidad y el cuidado al medio ambiente.
Aunque sin duda, este nuevo ímpetu es en algunos casos mera propaganda, también es cierto que hoy, en los aciagos momentos que vivimos, por lo menos ya es un avance que cada vez más personas adquieran la conciencia de cuidar al medio ambiente y también sepan sobre la importancia que tiene disminuir la emisión de los gases de efecto invernadero tales como el metano y dióxido de carbono, entre otros.
México vive en un escenario en el que muchas voces claman por la transición energética, pero pocas son las que han puesto su atención en el elemento que logrará consumar ese afán: el gas natural.
No es materia de este artículo presentar el amplio catálogo de las virtudes que lleva consigo la utilización de gas natural, entre las que destacan la seguridad energética, sino resaltar el lamentable hecho que en México la infraestructura para su transporte y



almacenamiento es, además de escasa, terriblemente paupérrima.
Lo anterior, por desgracia, coloca al sector energético en un severo estado de crisis porque entre otros, coloca a la transición energética en un campo minado y también da rostro a una catastrófica y silenciosa crisis medioambiental.
Sobre esto último nos preguntamos lo siguiente: ¿de qué manera la falta de infraestructura de transporte y almacenamiento de gas natural promueve una crisis de este tipo?
La respuesta es relativamente simple: la falta de infraestructura de transporte y almacenamiento de este hidrocarburo, así como la inexistencia de tecnologías y procesos estandarizados capaces de reconvertirlo en otros subproductos (e.g. fertilizantes como lo es el amoniaco) y la ausencia de mercados regionales interesados en reutilizarlo provoca que los operadores petroleros decidan liberarlo en la atmósfera, lo que significa que
grandes volúmenes de metano, CO2 y óxido de nitrógeno impacten negativamente en el medio ambiente y contribuyan a que sigamos respirando la nata tóxica que gradualmente está acabando con nuestras vidas.
A la actividad de liberar o “quemar” el gas en la atmósfera se le conoce como “venteo” y actualmente es un verdadero dolor de cabeza no solo para quienes lo respiramos, sino también para las empresas que en mayor o menor medida están obligadas a migrar sus operaciones hacia diversos esquemas tecnológicos que privilegien la disminución de metano, CO2 y óxido de nitrógeno.
No hace falta ser un gurú energético para asegurar que nuestro país aún está muy lejos de cumplir con los compromisos medioambientales asumidos a nivel internacional, como el Acuerdo de París o los recientemente adquiridos en el marco de la Conferencia de las Naciones Unidas sobre el Cambio Climático (COP27).
Apenas el mes pasado, uno de los aspirantes a la presidencia de la República y actual Secretario de Relaciones Exteriores, Marcelo Ebrard Casaubón, aseguró en la COP27 llevada a cabo en Egipto, que para el 2030 México reducirá entre 22 y 35% sus emisiones de gas de efecto invernadero a través del impulso de las energías renovables y la eliminación del venteo rutinario de las operaciones de PEMEX. Dicho sea de paso, como lo señaló el Grupo de Observación de la Tierra en la Escuela de Minas de Colorado, en 2021,
88 COLUMNISTAS MARCELO GONZÁLEZ Y JORGE A. ARRAMBIDE Diciembre 2022/Enero 2023 Petróleo&Energía
Marcelo González y Jorge Arrambide Luis E. González Piceno
MARCELO GONZÁLEZ JIMÉNEZ JORGE A ARRAMBIDE MONTEMAYOR
México alcanzó un récord histórico al quemar 6,500 millones de metros cúbicos de gas natural.
En un comunicado, la Secretaría de Relaciones Exteriores (SRE) informó que este compromiso será respaldado por una inversión de cerca de 2 mil millones de dólares.
Detengámonos un poco y seamos realistas, si tomamos como base que este gobierno tiene hondamente enquistado el fetiche cardenista de la soberanía energética –cuando la realidad es que precisamente por su falta de infraestructura nuestro país depende enteramente del gas texano, lo que mina la soberanía nacional– y que en los últimos cuatro años únicamente ha frenado permisos, obstruido autorizaciones, fiscalizado y amenazado a las empresas nacionales y extranjeras, y además
como cereza en el pastel, tuvo a bien destruir sin empacho a los reguladores del sector, por supuesto que no existe el mínimo indicio que pudiera hacernos pensar que lo dicho por el Canciller aterrizará en una intención sincera.
Lo que México necesita es la suficiente voluntad política y la solvencia técnica de los tomadores de decisiones del sector energético para crear una política de gas natural cuyos principales pilares sean la buena regulación y la modernidad tecnológica.

De no tener una buena política de gas natural seguiremos dependiendo del gas de Estados Unidos y lo peor es que poco a poco perderemos la salud e incluso vidas, por la catástrofe silenciosa que es el venteo de gas.
Veamos si lo que dice el Canciller va en serio.
@petroleoenergiaoficial petroleoenergia petroleoyenergia Petróleo Energia

PRIUS, EL NUEVO
En 1995 Toyota presentó al mundo su auto concepto híbrido, que dos años después debutaría en el mercado automotriz japonés como Prius, el primer auto que combinó un motor de combustión interna con uno eléctrico producido en serie.
AMéxico llegó la tercera generación cuando, en un arrebato de confianza, Tom Sullivan -Presidente de Toyota Motor Sales México- solicitó cien unidades para el mercado mexicano en 2010, mismas que logró vender, mostrando no solo a la corporación sino a la industria que México estaba listo para comenzar su transición a la movilidad electrificada.
En noviembre pasado fue presentado en Japón la quinta generación de este, que es sinónimo de ‘auto híbrido’ en el mundo; con la plataforma Toyota New Global Architecture (TNGA) de segunda generación, el nuevo Prius ofrece un paso más al futuro, pues llegará en 2023 una versión Plug-inHybrid(PHEV).



El impacto que Toyota ha logrado con este modelo es impresionante, no solamente porque ha vendido 5 millones 500 mil unidades a nivel global, esta cifra se puede traducir en una una reducción de al menos 82 millones de toneladas de emisiones de CO2.
Las novedades
El equipo a cargo de la quinta generación tuvo como concepto HybridReborn , co-
menzando desde cero luego de identificar qué necesitaba el modelo para seguir vigente al menos durante el próximo cuarto de siglo.
No solamente tiene un diseño nuevo que respeta apenas las formas básicas, el nuevo Prius emplea el SeriesParallelHybridSystem que ofrece una aceleración satisfactoria y conducción receptiva en un automóvil que reacciona como se espera mientras mantiene el mismo nivel de eficiencia de combustible que el modelo anterior. La potencia máxima del sistema es de 144 kW (193 CV) para la versión de 2.0 litros, que es 1.6 veces mayor que el modelo anterior, logrando un rendimiento dinámico apropiado para el nuevo Prius deportivo. Gracias al más reciente sistema E-Four, empleando un motor de alto rendimiento y otras características, ofrece un mejor rendimiento cuesta arriba en superficies de carreteras de baja fricción, como carreteras cubiertas de nieve, y una mayor estabilidad al girar.
90 TECNOLOGÍA E INNOVACIÓN TOYOTA PRIUS Diciembre 2022/Enero 2023 Petróleo&Energía
Jacobo Bautista Luis E. González
Híbrido Enchufable
Una de las grandes sorpresas en este lanzamiento fue el anuncio de un modelo PHEV, cuya batería puede ser cargada desde el exterior.
Adicional a esto se anunció que los modelos PHEV vienen equipados con un sistema de carga solar de segunda generación que consigue una conversión más eficiente de la energía solar en electricidad. Esto genera energía equivalente a conducir hasta mil 250 km por año.
La energía eléctrica generada mientras el auto está estacionado se utiliza para cargar la batería de la unidad, y el sistema no solo suministra electricidad para la conducción, sino también para el aire acondicionado y otras funciones. La energía eléctrica generada durante la conducción se utiliza para complementar el sistema de batería auxiliar.


El diseño
Lo más comentado después de su lanzamiento, fue el diseño radicalmente distinto. Esta nueva generación de Prius heredó la silueta monoforma original, regresó con proporciones aún más elegantes gracias a un centro de gravedad bajo y ruedas de gran diámetro de 19 pulgadas en la plataforma TNGA de segunda generación.



Su cuerpo simple pero esculpido expresa alegría que apela a los sentidos y una belleza universal que seguirá siendo popular en el futuro; su
diseño frontal tipo tiburón martillo logra un alto nivel de equilibrio entre funcionalidad y estilo, mientras que el diseño trasero ofrece una combinación de luces que se extienden horizontalmente hacia la izquierda y hacia la derecha, acentuando aún más el diseño avanzado de Prius.
Notas
@petroleoenergiaoficial petroleoenergia petroleoyenergia Petróleo Energia
91 petroleoenergia.com Diciembre 2022/Enero 2023
COMIENZA PRODUCCIÓN DE UN MODELO PROPULSADO POR HIDRÓGENO
En 1972 el Grupo BMW ensayó con un vehículo 100% eléctrico para las olimpiadas de aquel año. 50 años después BMW Group está comenzando la producción de su modelo BMW iX5 Hydrogen.
La fabricación del vehículo propulsado por hidrógeno no se dará a gran escala sino en una serie pequeña; esta se lleva a cabo en la planta piloto de su Centro de Investigación e Innovación de Múnich (FIZ). El primer SportsActivityVehicle (SAV) con tecnología de celda de combustible de hidrógeno ha completado un programa intensivo de pruebas en condiciones exigentes durante la fase de desarrollo y ahora se utilizará como demostrador de tecnología para la movilidad local libre de carbono en regiones seleccionadas a partir de la primavera de 2023.
Frank Weber, miembro del Consejo de Administración de BMW AG responsable de Desarrollo comentó sobre este anuncio que “el hidrógeno es una fuente de energía versátil que tiene un papel clave que desempeñar a medida que avanzamos hacia la neutralidad climática”, y
agrega: “estamos seguros de que el hidrógeno ganará significativamente en importancia para la movilidad individual y, por lo tanto, consideramos que una combinación de sistemas de propulsión eléctrica de batería y celda de combustible es un enfoque sensato a largo plazo. Las celdas de combustible tampoco requieren materias primas críticas como cobalto, litio o níquel, por lo que al invertir en este tipo de sistema de propulsión también estamos fortaleciendo la resiliencia geopolítica de BMW Group”.
Para el ejecutivo, la flota de prueba de BMW iX5 Hydrogen permitirá obtener nuevos y valiosos conocimientos, permitiendo presentar a los clientes una atractiva gama de productos una vez que la economía del hidrógeno se convierta en una realidad generalizada.

Este innovador iX5 Hydrogen se está construyendo en la planta piloto de BMW Group en su Centro de Investigación e Innovación en Munich, donde se fabrica por primera vez cada nuevo modelo de una de las marcas de la compañía. Alrededor de 900 personas trabajan allí en el taller de carrocería, ensamble, ingeniería de modelos, construcción de vehículos conceptuales y fabricación aditiva. Cada uno trabaja en hasta seis proyectos de vehículos simultáneamente y tiene la tarea de garantizar que tanto el producto como el proceso de fabricación estén listos para la producción en serie. En el caso del BMW iX5 Hydrogen, los especialistas en tecnología de hidrógeno, desarrollo de vehículos y ensamble inicial de nuevos modelos han estado trabajando en estrecha colaboración para integrar la tecnología de almacenamiento de energía y propulsión de vanguardia.
La tecnología
Los vehículos base para el modelo de hidrógeno, que se ha desarrollado sobre la plataforma del BMW X5 son suministrados por la Planta de BMW Group en Spartanburg, Estados Unidos.
Los vehículos están equipados con un nuevo conjunto de piso en el taller de carrocería de la planta piloto que permite acomodar los dos tanques de hidrógeno en el túnel central y debajo de la unidad del asiento trasero. Los sistemas eléctricos de 12 V y 400 V específicos del modelo, la batería de
92 Diciembre 2022/Enero 2023 Petróleo&Energía
Redacción Cortesía BMW Group Luis E. González Piceno
MOVILIDAD BMW
alto rendimiento, el motor eléctrico y la celda de combustible se integran durante la etapa de ensamble, junto con las piezas de producción de serie.
Ubicado en el área del eje trasero junto con la batería de alto rendimiento, el motor eléctrico es un producto de la tecnología BMW eDrive actual de quinta generación que también se emplea en los modelos híbridos conectables y eléctricos de batería de BMW. Los sistemas de celdas de combustible ubicados debajo del capó del BMW iX5 Hydrogen se han fabricado en el centro de competencia interno de BMW para hidrógeno en Garching, al norte de Múnich.

Al ser un modelo que no deja de ser experimental, numerosos componentes se producen exclusivamente para el SAV propulsado por hidróge-
no, incluidos algunos manufacturados en el Campus de fabricación aditiva, el centro de competencia de BMW Group para la impresión 3D, que también forma parte de la planta piloto.

El BMW iX5 Hydrogen pasa por todas las etapas habituales de producción, comenzando en el taller de carrocería y luego pasando por el taller de pintura y ensamble antes de finalizar con una inspección individual de cada vehículo. Después de esto, cada vehículo se somete a una revisión operativa integral en el centro de pruebas de BMW Group en Aschheim.
@petroleoenergiaoficial petroleoenergia petroleoyenergia Petróleo Energia

REDUCIR LA HUELLA DE CARBONO
Air Liquide México (líder mundial en gases, tecnologías y servicios para la Industria y la Salud, presentes en México desde 2011) lanzó este año una de sus más recientes iniciativas que genera gran impacto en términos de reducción de la huella de carbono. Esta iniciativa consiste en convertir el transporte de CO2 líquido por carretera en transporte ferroviario desde Texas hasta Monterrey, Nuevo León.

Al entregar mayores cantidades de CO₂ por ferrocarril, esta iniciativa disminuirá las emisiones del transporte en más de un 70% anual, reduciendo el impacto en nuestro medio ambiente. La iniciativa está en consonancia con el nuevo plan estratégico global llamado “Advance”, que sitúa el desarrollo sostenible en el centro de su estrategia empresarial. Con la convicción de que es nuestra misión contribuir a la sociedad en todos los aspectos en los que pueda marcar la diferencia, Air Liquide México ha decidido apostar por este proyecto, que se traduce en una mayor eficiencia, pero que responde, ante todo, al compromiso de la compañía de reducir sus emisiones de CO₂ en un 30% para 2035, en línea con los esfuerzos internacionales para reducir el calentamiento global.
Maersk descarboniza la industria logística
La industria naviera contribuye de 2% a 3% de las emisiones mundiales, lo que equivale a alrededor de 940 millones de toneladas de C0₂. La logística de descarbonización es el único compromiso a través del cual la industria puede hacer una contribución importante. A inicios de 2022 Maersk establece ambiciosos objetivos para lograr cero emisiones netas de gases de efecto invernadero en 2040, una década antes de su ambición inicial de 2050. Los objetivos van más allá de los esfuerzos por reducir las emisiones de la flota oceánica, pues cubren todas las emisiones indirectas del negocio de Maersk.
Los objetivos para 2030 garantizan un progreso en la reducción de las emisiones directas de Maersk en esta década. Incluyen una reducción de 50% en las emisiones por contenedor transportado en la flota de Maersk Ocean y una reducción de 70% en las emisiones absolutas de las terminales.
Para reducir las emisiones de CO₂ Maersk ha invertido para ahorrar energía y mejorar el desempeño ambiental, incluida la navegación lenta de los barcos, los sistemas de recuperación de calor residual, el diseño del casco de los barcos e incluso pintura de baja fricción. Los sistemas de recuperación de calor residual son estándar
94 TECNOLOGÍA E INNOVACIÓN DESCARBONIZACIÓN Diciembre 2022/Enero 2023 Petróleo&Energía
La industria naviera contribuye con cerca del 3% de las emisiones mundiales de CO2, y Maersk es la empresa más grande del sector
en todos los barcos nuevos y reducen las emisiones de CO₂ en alrededor de 10%. Los diseños optimizados del casco de las embarcaciones redujerion casi 8% las emisiones de CO₂. La navegación lenta ha reducido las emisiones de CO₂ hasta en un 20%.
Maersk anunció en abril pasado la decisión de unirse a Climate Group SteelZero, una iniciativa global que tiene como objetivo acelerar la transición a la industria siderúrgica neta cero, en asociación con Responsible Steel, el primer estándar global de la industria del acero. Así, Maersk colabora con organizaciones industriales de ideas afines comprometidas con la adquisición de acero alineada con el clima y el progreso en el desarrollo de un marco de políticas hacia la producción y el abastecimiento responsable de acero.
Recientemente el integrador logístico ordenó seis nuevos buques que se entregarán en 2025 y con los cuales se alcanzará un total de 19 buques con motores de combustible dual capaces de operar con metanol verde. Cuando los 19 buques solicitados estén desplegados y hayan reemplazado a los buques más antiguos, generarán un ahorro anual de emisiones de CO₂ de alrededor de 2.3 millones de toneladas. Maersk reitera además su estrategia de mantener una capacidad de flota en un máximo de 4.3 millones de TEU.
Mazda mete el acelerador
Mazda Motor Corporation anunció la actualización de su plan a mediano plazo y políticas hacia 2030, esto al considerar los cambios significativos que se han producido en el entorno empresarial, incluidas tendencias regulatorias ambientales en distintas regiones, riesgos geopolíticos y el rápido desarrollo de tecnologías avanzadas representadas por CASE (Connected, Autonomous, Shared and Electric).

Parte de su estrategia se enfoca en lograr la neutralidad de carbono para 2050; la empresa estableció un objetivo provisional de hacer que las fábricas de Mazda sean neutrales en carbono en todo el mundo para 2035. Sobre esta iniciativa han fijado tres pilares: conservación de energía, cambio a energías renovables y uso de combustibles neutrales de carbono.
Su estrategia de electrificación se ha dividido en tres fases hasta 2030 y será abordada de manera flexible. En la primera fase, harán uso de sus activos tecnológicos que comprenden múltiples tecnologías de electrificación para lograr una reducción de su huella ambiental y producir productos atractivos. En la segunda fase, presentarán un nuevo sistema híbrido y, en China, donde la electrificación está avanzando, darán a conocer vehículos EV, que luego lanzarán a nivel mundial.
En la tercera fase, promoverán el lanzamiento completo de vehículos eléctricos con batería y se estudiará invertir en la producción de baterías. Se estima que la relación EV de Mazda en las ventas globales aumentará a un rango entre 25 y 40% a partir de 2030.
Mazda abordará también la reducción de costos y la mejora de la cadena de suministro, que ha sido los últimos años una suerte de talón de aquiles para toda la industria automotriz. Desde un punto de vista integral, han prometido analizar tanto las cadenas de valor como las cadenas de suministro para eliminar por completo los desperdicios, las irregularidades y las sobrecargas para refinar sus costos, mejorando así nuestra capacidad para reducirlos y resistir las reducciones en la producción. Al avanzar hacia 2030, Mazda tendrá como objetivo continuar nuestra investigación basada en nuestra filosofía centrada en el ser humano, crear más experiencias conmovedoras para que las personas disfruten mientras conducen en su vida diaria y brindar más placer a la vida cotidiana.
@petroleoenergia Petróleo&Energía petroleoenergia Petróleo Energía Petróleo&Energía
95 petroleoenergia.com Diciembre 2022/Enero 2023
Redacción Cortesía Moisés Cervantes
Mazda está analizando producir sus propias baterías, pero su objetivo es claro: aumentar su venta de eléctricos hasta 40% para 2030.
APRUEBAN OBJETIVOS DE REDUCCIÓN DE EMISIONES DE CO2 DE AIR FRANCE-KLM
El Grupo Air France-KLM, Air France y KLM han presentado sus objetivos de reducción de emisiones de CO2, mismos que han sido aprobados por el Equipo de Validación de Objetivos del SBTi.
El SBTi ha aprobado los objetivos de reducción de emisiones de alcance 1 y alcance 3 del Grupo y confirmaron que están en línea con un objetivo muy por debajo de los 2°C, tal y como determina el Acuerdo de París firmado en 2015.
“La aprobación de los objetivos del SBTi es un elemento clave para que el Grupo garantice que la estrategia de descarbonización de Air France-KLM es coherente con los objetivos científicos.” declaró Benjamin Smith, CEO del Grupo Air France-KLM y agregó que el grupo “diseñó un enfoque coherente, desarrollado dentro de su estrategia de Sostenibilidad de Destino, con el objetivo de reducir las emisiones de CO2 basado en tres pilares principales: la renovación de la flota, el combustible de aviación sostenible y las medidas operativas”.


La aprobación de los objetivos del SBTi es un elemento clave para que el Grupo garantice que la estrategia de descarbonización de Air France-KLM sea coherente con los objetivos científicos.
Destination Sustainability
El Grupo Air France-KLM se ha comprometido a reducir el impacto medioambiental de sus actividades. Para ello, ha establecido un objetivo de descarbonización basado en tres palancas principales agregadas dentro del programa Destination Sustainability .
Estas palancas son las siguientes:
• Un ambicioso plan para modernizar y renovar las flotas de las aerolíneas del Grupo con aviones de última generación, que emiten entre un 20 y un 25% menos de CO2 en comparación con sus predecesores. Con el objetivo de tener un 64% de aviones de nueva generación en la flota del Grupo para 2028, el Grupo está invirtiendo actualmente más de 2,000 millones de euros anuales para la adquisición de Airbus A220, Airbus A320neos y A321neos, Airbus A350, Boeing 787 y Embraer 195-E2, que se encuentran entre los aviones más eficientes de sus respectivas categorías.
• El uso de combustibles de aviación sostenibles (SAF). Estos combustibles no fósiles pueden producirse a partir de residuos industriales o domésticos en una economía circular, y el SAF obtenido por Air France-KLM no compite con la cadena alimentaria humana ni con la alimentación de los animales. Air France y KLM han sido pioneras en el uso de estos combustibles alternativos, que desempeñarán un papel clave en la descarbonización del transporte aéreo, ya que pueden reducir las emisiones de CO2 hasta en 80% durante su ciclo de vida. En este sentido, en noviembre de 2022 se firmaron dos acuerdos de off-take que permiten al Grupo asegurar 3% del objetivo de incorporación de 10% de SAF para 2030.
• La mejora de la eficacia operativa, favoreciendo objetivos más directos y aplicando procedimientos que limitan el consumo de combustible (rodaje monomotor, descenso continuo, etc.).
TECNOLOGÍA E INNOVACIÓN INDUSTRIA AEROESPACIAL
Redacción Cortesía Carlos Cuevas

DIRECTORA GENERAL DE NRGI BROKER
DIRECTORA GENERAL DE NRGI BROKER
















 SECRETARIA DE GESTIÓN TECNOLÓGICA Y VINCULACIÓN DEL IER-UNAM
SECRETARIA DE GESTIÓN TECNOLÓGICA Y VINCULACIÓN DEL IER-UNAM







 DIRECTORA GENERAL TOTALENERGIES MÉXICO
DIRECTORA GENERAL TOTALENERGIES MÉXICO

















 DIRECTORA GENERAL DEL INSTITUTO NACIONAL DE ELECTRICIDAD Y ENERGÍAS LIMPIAS (INEEL)
DIRECTORA GENERAL DEL INSTITUTO NACIONAL DE ELECTRICIDAD Y ENERGÍAS LIMPIAS (INEEL)











 DIRECTOR
MÉXICO
DIRECTOR
MÉXICO




 DIRECTOR DEL CENTRO NACIONAL DE CONTROL DE ENERGÍA
DIRECTOR DEL CENTRO NACIONAL DE CONTROL DE ENERGÍA






 DIRECTOR GENERAL DE NATURGY MÉXICO
DIRECTOR GENERAL DE NATURGY MÉXICO
 GAS / PRIVADO
GAS / PRIVADO










 DIRECTOR GENERAL DE COMBUGAS
DIRECTOR GENERAL DE COMBUGAS

 PaulAlejandros
PaulAlejandros






































































 HIDROCARBUROS / PRIVADO
HIDROCARBUROS / PRIVADO



















 HIDROCARBUROS / PRIVADO
HIDROCARBUROS / PRIVADO

























 HIDROCARBUROS / PÚBLICO
HIDROCARBUROS / PÚBLICO
 / PRIVADO
/ PRIVADO



























































































